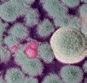

NR. 41 / 1 / 2024 GATES ATBILD UZ JAUTĀJUMIEM 40.–42. lpp. GAIDĀM HOKEJA BRĪNUMU 130.–134. lpp. “PARKINGSENSORU” VĒSTURE 60.–63. lpp. MOTOINTEGRATOR “SIEVIEŠU RALLIJS 2024” 44.–46. lpp. BEZMAKSAS 68.–71. lpp. SARUNA AR “TET RALLY LATVIA” ORGANIZATORU RAIMONDU STROKŠU CEĻŠ UZ LATVIJAS WRC POSMU 14 GADU GARUMĀ



















































































Žurnāls “IC informācija”, Inter Cars Latvija
Redakcijas adrese:
SIA “Inter Cars Latvija”, Plieņciema iela 35, Mārupe Tālr. (+371) 6767 0275; www.intercars.lv
Redaktors: Armands Umbraško
Sadarbībā ar: Danilu Kacovu (Car-Use), Daci Janovu (4 rati), Ilonu Bērziņu Grafiskais dizains un maketēšana: Andis Laizāns (Inter Cars Latvija) Ketija Grūbe (MASTER AD LTD)
Vāka attēls: Dace Janova
Žurnāls iespiests: SIA “Green Print”
Atbildīgais par reklāmas izvietošanas iespējām žurnālā: Armands Umbraško, tālr. (+371) 24113500, e-pasts: armands.umbrasko@intercars.eu
Visas izdevumā izmantotās preču un servisa zīmes ir atbilstošo uzņēmumu reģistrētais vai faktiskais īpašums. Izdevumā paustie viedokļi var atšķirties no redakcijas, kā arī no pārstāvēto ražotāju oficiālajiem uzskatiem. Izdevuma tapšanā ir izmantoti autordarbi, kā arī redakcijas ziņu un attēlu arhīva materiāli. Informatīvajos materiālos var tikt izmantoti atbilstošo ražotāju preses materiāli un publicitātes fotoattēli bez papildu atsaucēm. Visas norādītās cenas ir informatīvas, un tās var tikt mainītas bez iepriekšēja brīdinājuma.
Jebkuri pārpublicējumi ir iespējami tikai ar žurnāla “IC informācija” rakstveida atļauju. Citējot atsauce uz žurnālu “IC informācija” ir obligāta. SIA “Inter Cars Latvija” neatbild par reklāmu un tās valodu.

Digitālais laikmets ir mainījis gan to, kā mēs komunicējam, gan lielā mērā arī to, kā strādājam. Tehnoloģiju attīstība klientiem ļauj ekonomēt laiku, atrast sev piemērotākos pakalpojumus un to sniedzējus, tiešsaistes platformās iepirkties, izīrēt savu mājokli vai atrast sev piemērotu īres dzīvokli, rezervēt automašīnu, lidmašīnas biļetes vai pakalpojumu –iespēju netrūkst, un ar katru dienu to paliek arvien vairāk. Globālā tendence liecina, ka digitālo pakalpojumu loma turpinās augt, jo cilvēki arvien vairāk novērtē digitālo rīku priekšrocības pakalpojumu pieteikšanā. To integrācija jebkuras jomas uzņēmējdarbības praksē ir viens no sekmīgas konkurētspējas priekšnoteikumiem, un autoservisu darbība nav izņēmums. Tiešsaistes platformu potenciāls biznesa attīstībā un jaunu klientu piesaitē ir viens no “Inter Cars” autoservisu meklēšanas digitālās platformas “Motointegrator.lv” panākumu stūrakmeņiem.
Platformas datubāzē vienuviet apkopoti jau vairāk nekā 950 Latvijas autoservisu un katru dienu nāk klāt arvien jauni. Eiropā tendence, kad autoservisi un autovadītāji apvienojas šādās platformās, lai atrastu piemērotāko apkopes vai remonta darbu veicēju savam automobilim vai motociklam, kļūst arvien izplatītāka.
Autoservisiem nav jāinvestē ne programmatūras izstrādē, ne vietnes uzturēšanā, pietiek reģistrēties “Motointegrator.lv”, lai gūtu iespēju piesaistīt arvien jaunus klientus un pēc iespējas plašākai auditorijai pastāstīt par saviem pakalpojumiem, īpašajām akcijām, piedāvājumiem, remontdarbu izmaksām un citām lietām. Būtisks bonuss ir arī “Motointegrator.lv” partneru piedāvātās akcijas autoservisu un to klientu savstarpējās lojalitātes stiprināšanai.
Auto īpašnieki – vai tās būtu privātas vai juridiskas personas – platformā var atrast ne vien sev tuvāko autoservisu, bet arī caurspīdīgā un pārskatāmā veidā izvērtēt gan servisa piedāvātās cenas, gan iepriekšējo klientu verificētās atsauksmes. Turklāt, tā kā platforma darbojas 12 dažādās Eiropas valstīs, to var izmantot arī ceļojot.
“Motointegrator.lv” nemitīgi aug, paplašinās un attīstās, lai spētu lietotājiem piedāvāt arvien jaunas iespējas. Šobrīd platforma tiek veidota kā digitālā ekosistēma, kas nākotnē praktiski netiks nodalīta no “Inter Cars”, un lielu daļu darbu autoservisi varēs saplānot jau “Inter Cars” e-katalogā. Tiks izveidots speciāls kalendārs, lai, ieejot sistēmā, autoservisa darbinieki jau redzētu, uz kura pacēlāja kāda mašīna atrodas vai arī cik automobiļi atrodas riepu stendā. Šie jauninājumi būs nopietns palīgs autoservisiem to ikdienas darba plānošanai un tāpat kā “Motointegrator.lv” platforma būs pieejami bez maksas.
INTER CARS AKTUALITĀTES 1–46 NODERĪGA INFORMĀCIJA 50–65 AUTOSPORTA JAUNUMI 68–85 RAŽOTĀJU INFORMĀCIJA 88–115 IZKLAIDE 118–134
1 Redaktora sleja
IVARS KLINTS B2C segmenta vadītājs





INTERCARS.LV
Lai piedalītos akcijā, lūdzu, reģistrējies šeit: www.ej.uz/gadaakcija vai sazinies ar savu Inter Cars tirdzniecības pārstāvi!
AR INTER CARS “PACEL” SAVU SERVISU



















KĀ LIETOT ATLAIŽU KUPONU?
1Pievieno akcijas preces pirkumu grozam
2Akcijas preces katalogā tiek atzīmētas ar birku.
4Pasūtījuma grozā spied uz aktīvo saiti –


5Ieraksti kupona kodu, spied PIEVIENOT un pēc tam pasūti atlasītās preces.



3Zem akcijas birkas redzēsi atlaižu kupona kodu
6Akcijas precēm tiks piemērota norādītā atlaide!
GADA AKCIJA SEKO JAUNUMIEM E-CAT UN SAŅEM PAPILDU ATLAIDES APRĪLIS
INTERCARS.LV

















Pērc Bosch bremzes, filtrus, logu slotiņas, siksnas piedziņas produktus!

Pērc Bosch bremzes, filtrus, logu slotiņas, siksnas piedziņas produktus vienā pirkumā par vismaz 100 EUR (bez PVN) un saņem pludmales dvieli par 1 centu!
- Akcijas balva jūsu pirkumam tiks pievienota automātiski.
- Ja vēlies, to no pasūtījuma var izņemt.
- Vienā pirkumā klients var iegūt 1 balvu.


Pērc Bosch bremzes, filtrus, logu slotiņas, siksnas piedziņas produktus akcijas periodā par vismaz 500 EUR (bez PVN), uzrādi pieaugumu un saņem kafijas aparātu!
- Balvu saņems TOP 5 klienti, kas uzrādīs lielāko pirkumu apjoma pieaugumu EUR pret pagājušā gada analoģisko periodu (01.04.–30.06.2023.).
- Balvu saņems TOP 10 lielāko pirkumu kopsummu sasniegušie klienti.
- Balva – kafijas aparāts Siemens EQ.500 TP501R09
- Akcijas rezultātu aprēķinā tiks ņemtas vērā tikai juridiskas personas.
- Pirkumi tiek summēti visas akcijas laikā.
- Akcijas uzzvarētāji tiks informēti personīgi.
- Balvas tiks izsniegtas ar nosacījumu, ka klientam nav kavētu maksājumu.
- Pilni akcijas noteikumi – www.intercars.lv.
Akcijas periods: 01.04.–30.06.2024.

INTER CARS PRODUKTU JAUNUMI
Jaunumi no KYB
INTER CARS
paplašinājis klāstu ar pasaulē pazīstamā balstiekārtas zīmola KYB produkciju – jau tagad INTER CARS klāstā ir pieejami lodbalsti, stūres stieņi, stūres pirksti, stabilizatora atsaites.
Jaunums starteru un ģeneratoru segmentā INTER CARS





Daži INTER CARS piedāvātie KYB balstiekārtas un stūres sistēmas kodi:

• KYBKTR1391,
• KYBKSLR1059,
• KYBKRE1079,
• KYBKBJ1004.
Poļu zīmols –
POLSTARTER! Kvalitāte par labu cenu!
Sākot ar 2024. gada martu, INTER CARS piedāvā jaunu ekonomiskās klases starteru un ģeneratoru zīmolu – POLSTARTER.
POLSTARTER, tā ir vairāk nekā 30 gadu pieredze. Sā kotnēji, kā mazs ģimenes uzņēmums – starteru un ģeneratoru remontdarb nīca, POLSTARTER gadu gaitā izaudzis par tehnoloģiski augsti attīstītu uzņēmumu ar vairāk nekā 70 darbiniekiem un pastāvīgu klientu tīklu visā Eiropā.



• Rūpnieciski atjaunoti starteri;
• Rūpnieciski atjaunoti ģeneratori;
• Iekārtas un stendi starteru un ģeneratoru remontam un diagnostikai;
• Rezerves daļas un komponentes starteriem un ģeneratoriem.

22
aktualitātes
Jaunums INTER CARS piedāvājumā. “Landport” – moto tehnikas akumulatoru ražotājs
IC papildina savu plašo motociklu akumulatoru klāstu ar tirgū jau iepazīto ražotāju “Landport”, kas piedāvā pilnu motociklu akumulatoru klāstu –sērijas: DRY, AGM, SLA, GEL, LFP un HVT.

Jaunumi no OE GERMANY

INTER CARS paplašinājis klāstu ar vācu zīmola OE GERMANY dzinēja balstiem vieglajām automašīnām – BMW, MERCEDES, VAG.
OE GERMANY produkti jau iepriekš bija INTER CARS piedāvājumā – galvenokārt dzinēja daļas kravas automašīnām. Ņemot vērā zīmola kvalitātes / cenas attiecību, tika pieņemts lēmums iekļaut piedāvājumā arī dzinēja balstus vieglajām automašīnām.
Dažu INTER CARS piedāvāto OE GERMANY dzinēju balstu kodi:
• OEG800529,
• OEG800531,
• OEG801206,
• OEG800535.


Piemērots motocikliem, skrejriteņiem, visurgājējiem, ūdens motocikliem, sniega motocikliem.
Jau daudzus gadus LP ir bijis “Powersport” profesionāļu un uzņēmumu ieteiktais zīmols.
POWERSPORT sērija piedāvā
• Inovatīvas tehnoloģijas;
• Plašs produktu klāsts; Uzticamība; Drošība.

Jaunumi no “DRAGON WINCH”
Sākot ar 2024. gadu, “Dragon Winch” piedāvā 6 jaunus gaisa kompresoru “Professional Line” modeļus.
Spēcīgs dzinējs, pārdomāts un praktisks, tomēr moderns dizains. Daudzas kustīgās plastmasas detaļas dzinējā un sūknī ir uzlabotas un izgatavotas no alumīnija, tādējādi ievērojami palielinot kompresora kalpošanas laiku. Ergonomisks dizains ļauj ērti kompresorus pārvadāt. Dažādas jaudas un pielietojumi.


Izvēlies nevis vienkārši darba rīku, bet uzticamu un profesionālu partneri saviem projektiem.
IC kodi:
• DWKPS500P
• DWKPS500S
• DWKPS150T
• DWKPS150S
• DWKPS150P
• DWKPS50T
Visi akumulatori tiek pakļauti stingrām kvalitātes pārbaudēm un atbilst prasībām ar starptautiskajiem drošības standartiem.






INTER CARS aktualitātes 23
“YOUNG CAR MECHANIC 2024” PUSFINĀLS NOSLĒDZIES. MAIJĀ NOSKAIDROSIM LABĀKO!
Profesionālās izglītības iestāžu audzēkņu profesionālās meistarības konkurss “Young Car Mechanic”, kurš no nacionāla mēroga pasākuma pārtapis prestižā starptautiskā konkursā, šogad norisinās jau 17. gadu pēc kārtas, bet kopā ar “Inter Cars” konkurss piedzīvo jau savu 8. sezonu. Kā norāda “Inter Cars Latvija” mārketinga vadītājs un viens no konkursa organizatoriem Armands Umbraško, pateicoties konkursam, studentiem tiek nodrošināts ļoti labs pamats nākotnei un iespēja gūt starptautisku pieredzi, savukārt skolas un pasniedzēji apmainās ar pieredzi.

Konkurss “Young Car Mechanic” ir viens no nozīmīgākajiem profesionālās izglītības iestāžu mācību gada notikumiem. Šogad konkursā varēja piedalīties visi tehnisko skolu audzēkņi, kuri dzimuši 2022. gada 1. janvārī un vēlāk. Viņiem interneta testā bija jāatbild uz 100 jautājumiem ar iespējamiem atbilžu variantiem. Uz pusfinālu devās katras skolas trīs audzēkņi, kuri bija ieguvuši lielāko punktu skaitu pirmajā kārtā, un viens audzēknis, kuru pieteica skola pēc saviem ieskatiem.
Cīņa kļūst arvien spraigāka
Ar katru gadu cīņa par dalību pusfinālā un finālā kļūst arvien spraigāka. Par to liecina arī lielais jauniešu skaits, kuri piedalījās konkursa pirmajā jeb atlases kārtā. Ja 2021. gadā pirmajā kārtā konkurss pulcēja 216 konkursantus, 2022. gadā – 343 dalībniekus, tad šogad, tāpat kā pērn, spēkus, atbildot uz testa jautājumiem tiešsaistē, izmēģināja 413 jaunie automehāniķi, no kuriem testu izpildīja 407. Labāko
rezultātu – 83 punktus – ieguva divi jaunieši, otrs labākais rezultāts bija 80 punkti, kurus ieguva viens dalībnieks, bet vidējais rezultāts bija 51 punkts. “Ja pirmās kārtas rezultāti bija ļoti skaisti, ļoti labi, tad otrajā kārtā vidējais rezultāts jau bija nedaudz sliktāks – 25 punkti,” saka Armands Umbraško un uzsver, ka tie puiši, kas sasniedza labākos rezultātus pirmajā kārtā, arī stabili turējās līderos otrajā kārtā. “Malači, labi sagatavojušies. Nacionālajā finālā raudzīsimies, ko viņi var paveikt praktiskajos uzdevumos.”
INTER CARS aktualitātes 24
Braukšanas komforta nākotne

MEYLE ORIGINAL amortizatori ne tikai rūpējas par klientu drošību, bet arī nodrošina braukšanas komfortu, jo mūsu ražošanas un izstrādes zināšanas ļauj mums to pasniegt vienmēr augstākā kvalitātē. Izstrādājot un ražojot mūsu amortizatorus, mēs koncentrējamies uz drošību un komfortu. Šīs sastāvdaļas rada perfektu saķeri ar ceļu, mēs esam ne tikai jums blakus, bet arī uz klāja – ar tādu kvalitātes līmeni, kas patīk mūsu klientiem. Spēcīgi!
Vairāk informācijas m e y le . c om
Klupšanas akmeņos pat Oma likums
Konkursa pusfinālam, kurš 23. februārī norisinājās Starptautiskajā izstāžu centrā “Ķīpsala” izstādes “Skola 2024” ietvaros, kvalificējās 63 jaunieši no 17 skolām. Viņiem vienas stundas laikā bija jāatbild uz 50 testa jautājumiem. Uzdevumu vēl vairāk sarežģīja tas, ka daļa jautājumu bija angļu valodā.
“Inter Cars Latvija” produktu vadības speciālists Sergejs Savkins, kurš šogad bija viens no testu pārbaudītājiem, atzīst, ka bijuši jautājumi, uz kuriem viņš gaidījis, ka rezultāti būs labāki, jo uz šiem jautājumiem atbildes studentiem būtu jāzina.
Taujāts, kādi bija lielākie klupšanas akmeņi, Sergejs pauž, ka dažiem tie bijuši gaužām vienkārši. “Man liekas, ka studentiem jāzina tādas lietas kā Oma likums, ko skolā māca 9. klasē, tomēr tajos jautājumos daži izgāzās. Vai arī tādi jautājumi kā kompresijas pakāpe, kas automehāniķim būtu jāzina, bet vairākiem pareizi atbildēt uz šo jautājumu nesanāca.” Tomēr viņš uzsver, ka bijuši arī studenti, kuri patīkami pārsteidza ar atbildēm uz grūtākiem jautājumiem. Kā piemēru viņš min studentu labās zināšanas par nozarē lietotajām angļu abreviatūrām. “Uz jautājumu, ko nozīmē SCR, vairāki studenti sniedza pareizo atbildi – “Selective Catalytic Reduction”.”
Izaicinājums un izaugsmes iespēja
Tehnisko skolu pedagogi atzīst, ka dalība konkursā motivē vairāk mācīties un apgūt ko jaunu arī ārpus mācību programmas. Jelgavas tehnikuma pedagogs Aivars Granskis, kura audzēknis 2018. gadā plūca uzvarētāja laurus, norāda – dalība konkursā ir izaugsmes iespēja un pierāda puišu interesi par šo profesiju. “Tā vēlme zēniem ir, tāpat kā dzirkstelīte, kas mudina iet tālāk. Viņi paši ir motivēti uz to, un es ceru, ka rezultātiem jābūt,” saka pieredzējušais pedagogs. Viņš atzīst, ka puišu, kuri vēlas mēroties spēkiem ar citu skolu studentiem, Jelgavas tehnikumā netrūkst un nācies pat raudzīties, kuru laist uz konkursu un kuru – nē. Rezultāts ir labs – no Jelgavas tehnikuma nacionālajā finālā startēs divi jaunieši.

Savukārt Rīgas Tehniskās koledžas pedagoģe Sanita Eihmane, kuras audzēkņi iepriekšējos trīs gados kāpuši uz goda pjedestāla, pērn iegūstot otro vietu, 2022. gadā – pirmo un otro, bet vēl gadu iepriekš otro vietu, atzīst, ka vienmēr jau gribas tikt godalgotajā trijniekā, bet savu lomu spēlē arī uztraukums. Pēc viņas teiktā, daudziem studentiem dalība “Young Car Mechanic” dod pārliecību par sevi.
Sanita stāsta, ka studenti paralēli arī strādā kurš lielākā, kurš mazākā autoservisā, taču visi ir aktīvi un labprāt piedalījās arī konkursā. “Šogad man visi dalībnieki ir no trešā kursa, viņiem vēl gads mācību priekšā. Bet, kā es saku, lai viņi pierāda sevi.”
Arī Liepājas Valsts tehnikuma pedagogs Artūrs Bunka uzsver – daudziem studentiem konkurss ir kā sava veida izaicinājums. “Viņi redz, kā citi iepriekšējos gadus piedalās, es viņiem rādu tos pozitīvos piemērus, un tas motivē jauniešus mācīties, piedalīties, izaicināt sevi uz jauniem sasniegumiem.” Viņa audzēknis varēja lepoties ar otrās vietas iegūšanu 2020. gadā. “Parasti es uz šo konkursu sūtu tikai ceturtos kursus, bet šogad sanāca tā, ka ceturto bija maz un palaidu arī trešo kursu. Viņi sevi tik labi pierādīja, ka divi no konkursa otrās kārtas dalībniekiem man ir “trešie”, divi – “ceturtie”. Redzu, ka šī gada otrie kursi ir vēl labāki, tā ka nākamgad konkursā no mūsu skolas būs vēl “niknāki” jaunieši.”
Iespēja pārbaudīt zināšanas
Testa izpildei paredzēto laiku – sešdesmit minūtes – pilnībā neizmantoja neviens students. Vieni no pirmajiem darbus nodeva Dāvis Salmiņš un Toms Samulons, Jelgavas tehnikuma 4. kursa studenti. Atbildot uz jautājumu, kādi bija 2. kārtas jautājumi – grūtāki vai vieglāki nekā atlases testā, abi puiši atzina, jautājumi šķituši nedaudz vieglāki nekā pirmajā posmā. Dāvis Salmiņš uzsvēra gandarījuma sajūtu par to, ka nonācis otrajā kārtā, un teica: “Tas ir ļoti augsts līmenis.” Viņš stāsta, ka, gatavojoties konkursam, papildu nodarbības nav bijušas, bet “skolotāji bija ļoti atsaucīgi – ja kaut ko vajag palīdzēt, vienmēr izstāsta, pamāca, kā pareizāk darīt un ko nevajadzētu darīt. Tāpēc problēmu nav”.
Savukārt Toms Samulons, vaicāts, kā veicās ar testa pildīšanu, atbildēja: “Gājām jautājums pēc jautājuma, zināšanas ir tik, cik ir, lieki nedomājām –pildījām testu.” Puisis arī uzsvēra – tas, ka daļa jautājumu bija angļu valodā, viņam nesagādāja nekādas grūtības.
Arī Kandavas Lauksaimniecības tehnikuma “ST Saulaine” students Kristiāns Saulītis pēc otrās kārtas testa izpildīšanas atzina, ka jautājumi bija interesanti un vieglāki nekā pirmajā kārtā, bet kā lielāko ieguvumu no dalības konkursā viņš min iespēju pārliecināties par to, cik daudz īsti tu zini. “Tas bezmaz vai ir tā, kā sagatavoties gala eksāmenam,”
INTER CARS aktualitātes 26





Nacionālajā finālā piedalīsies 11 finālisti no 10 skolām:
Skolas nosaukums
Aizkraukles Profesionālā vidusskola
Jelgavas tehnikums
Jelgavas tehnikums
Kandavas Lauksaimniecības tehnikums
Kandavas Lauksaimniecības tehnikums “ST Saulaine”
Kuldīgas Tehnoloģiju un tūrisma tehnikums
Latgales Industriālais tehnikums
Malnavas koledža
Rīgas Tehniskā koledža
Smiltenes tehnikums
Vidzemes Tehnoloģiju un dizaina tehnikums
viņš saka. Kristiāns atzīst, ka pedagogi palīdzējuši gatavoties. “Vienmēr ir pretimnākoši un palīdz, ja tiek uzdoti jautājumi.”
Valters Jansons no Rīgas Tehniskās koledžas saka, ka dalība konkursā ir izaicinājums – piedalīties, pamēģināt konkurenci. “Priekš sevis pieņēmu to kā izaicinājumu.” Pēc viņa teiktā, bija jautājumi, kas likās diezgan viegli, bet bija arī tādi, kas šķita diezgan sarežģīti. Atbildot uz jautājumu, kādēļ viņš izvēlējies automehāniķa profesiju, Valters saka: “Patīk mašīnas. Patīk braukt ar mašīnām, patīk lauzt mašīnas, un vajag arī mācēt tās sataisīt.”
Vārds Uzvārds
Ritvars Sirmais
Helmuts Dučkens
Helmuts Vēza
Andrejs Vaivods
Renārs Bernhards
Kristers Juris Pūkainis
Elvars Friliņš
Raitis Ormanis
Arturs Vids
Egīls Ausējs
Kristers Ansis Ārgalis
Savukārt Liepājas Valsts tehnikuma 3. kursa students Intars Sproģis atzīst, ka bijis interesanti, jo “daudzi jautājumi, kas bija pirmajā kārtā, neatkārtojās un tagad var pārbaudīt savas zināšanas”. Taujāts, kādēļ izvēlējās automehāniķa profesiju, puisis saka: “Mans tētis ir automehāniķis, un viņš mani par to visu ieinteresēja. Pašu interesē mašīnas, vēlos uzzināt vairāk.”
Arī vienīgā meitene, kura tika līdz otrajai kārtai, Diāna Līve no Malnavas koledžas teic, ka automehāniķa profesiju izvēlējusies, pateicoties vecākiem. “Jau no agras bērnības garāžā palīdzēju vecākiem, kaut kā gadu gaitā tas
iepatikās, un es atnācu mācīties uz Malnavu.” Diāna neslēpj, ka stress bijis liels, tomēr visi jautājumi bijuši diezgan interesanti.
Iegāž pārlieka pašpārliecinātība
Sergejs Savkins norāda, ka daudzus studentus iegāzusi pārliekā pašpārliecinātība, jo vairākos jautājumos vajadzējis ilgāk padomāt un vēlreiz pārbaudīt rezultātus. “Students atbildēja pārāk ātri, neielasījās, neizlasīja līdz galam un neiedziļinājās jautājuma būtībā, kas tika prasīts.”
Rezumējot rezultātus, Sergejs teic: “14 cilvēki saņēma 30 un vairāk punktu, bet 50% no tiem studentiem, kuri tika nākamajā kārtā, visiem bija vienāds rezultāts – 31 punkts.” Viņš stāsta, ka studentam, kurš saņēma visvairāk punktus, testa izpildei vajadzēja 37 minūtes, otrs labākais tika ar uzdevumu galā 28 minūšu laikā, trešais testu izpildīja 33 minūtēs. Ilgākais testa izpildes laiks starp visiem nacionālajā finālā iekļuvušajiem jauniešiem bija 43 minūtes.
Labas izglītības iespējas nav tikai Rīgā vien
Viens no lielākajiem pārsteigumiem ir, ka šogad nacionālajam finālam nekvalificējās neviens no pagājušā un aizpagājušā gada pirmās vietas ieguvušā Rīgas Valsts tehnikuma. Armands Umbraško saka, iespējams, šī neveiksme skaidrojama ar to, ka daudziem jauniešiem, kuri mācās 4. kursā, sākas prakses un mācību apmaiņas, viņi mēdz kaut kur aizbraukt projām, un sanāk tā, ka pašiem labākajiem nemaz nav iespējas piedalīties.
Toties pozitīvais ir, ka varam redzēt –labas izglītības iespējas nav tikai Rīgā vien. “Puisis no Latgales skolas parādīja labāko rezultātu gan 1., gan 2. kārtā. Tas, ka Rīgas skolas nav starp acīm redzamiem līderiem un pat vispār nav iekļuvušas, rāda, cik liels potenciāls ir profesionālajām skolām reģionos. Manuprāt, tas ir diezgan pozitīvi,” tā Armands Umbraško.
Nacionālā fināla dalībnieki ir noskaidroti. Tomēr lielākā intriga – kuri studenti kāps uz goda pjedestāla jau maija vidū un, galvenais, kurš pārstāvēs Latviju starptautiskajā finālā Lietuvā –vēl priekšā.
INTER CARS aktualitātes 28
UZ T ICIE S ORIĢIN Ā L A M .

Riteņu gultņi no FAG. Drošība OE kvalitātē.
gultņi tiek izmantoti automašīnās, velosipēdos, skrituļslidās, lidmašīnās un pat kosmosa kuģos. Un ir pamatots iemesls, kāpēc tik daudzi uzticas mūsu izstrādājumiem – precizitāte, ilgs kalpošanas mūžs un zema rites pretestība, kas samazina degvielas patēriņu. Tie ir galvenie iemesli, kāpēc FAG gultņi ir uzstādīti neskaitāmās automašīnās kā oriģinālaprīkojums.
Tehniskā apmācība ir daļa no mūsu piedāvājuma.
www.repxpert.com


CIETO DAĻIŅU DAUDZUMA
MĒRĪŠANA IZPLŪDĒ
PĀRBAUDES METODIKAS
TEHNISKAJĀ APSKATĒ
UN IEKĀRTAS
Medijos jau vairākkārt ir izskanējis, ka Latvijā no 2025. gada plāno ieviest stingrākus izplūdes pārbaudes noteikumus Euro 5 un Euro 6 standarta dīzeļautomašīnām. Vienkāršāk sakot, iziet tehnisko apskati ar noņemtu kvēpu filtru neizdosies. “Inter Cars” speciālisti pastāsta, kādas pārbaudes metodikas un kāds aprīkojums var tikt izmantots.

Mēdz teikt, ka dīzeļdzinēja izplūdē tiek pārbaudīta dūmainība. Jaunu metodiku gadījumā šis termins nebūs gluži pareizs: izplūdē tiks pārbaudīts tajā esošo cieto daļiņu –proti, kvēpu – daudzums. Šo daļiņu daudzuma mērīšanai ir divas metodes: kondensācijas (CPC – Condensation Particles Counter) un difūzijas (DC − Diffusion Charge).

Īsāk sakot, metožu būtība ir šāda. Mērīšanai ar kondensācijas metodi nepieciešams darba šķidrums – izopropilspirts. Šis spirts tiek izmantots daļiņu suspendēšanai – tās kļūst redzamas, pēc tam tās tiek saskaitītas, izmantojot lāzerskenēšanu. Difūzijas metode nozīmē daļiņu jonizāciju, izmantojot augstu spriegumu (> 3 kV), un ģenerētās strāvas attiecību ar daļiņu skaitu. Katrai metodei ir savi plusi un mīnusi.
Kondensācijas metodes priekšrocības:
daļiņu reālā daudzuma mērīšana; precizitāte nav atkarīga no daļiņu sadalījuma pēc izmēriem; augsta mērīšanas precizitāte pat zemā temperatūrā; piemērota spēkā esošajām un potenciāli stingrākām nākotnes prasībām, pateicoties maksimāli iespējamai precizitātei.
Par trūkumu tiek uzskatīta nepieciešamība izmantot minēto darba šķidrumu, kā arī fakts, ka kondensācijas metode uzskatāma par dārgāku. Vispār jau CPC metodi izmanto ne tikai izplūdes gāzes pārbaudei: piemēram, medicīnas laboratorijās šādā veidā pārbauda filtru darbības efektivitāti.
INTER CARS aktualitātes 30

Difūzijas metode ir lētāka, darba šķidrums nav vajadzīgs, tomēr to kompensē daži trūkumi:
netiek izmērīts reālais daļiņu daudzums;
precizitāte atkarīga no daļiņu sadalījuma pēc izmēriem; izplūdes gāzu mērīšana ar augstu piesārņojuma (kvēpu) līmeni var samazināt iekārtu tehniskās apkopes intervālus; nav garantijas, ka metode atbildīs striktākiem noteikumiem nākotnē.
CSDD jau ir veikti eksperimenti ar iekārtām, kas mēra daļiņu daudzumu izplūdē. Visai likumsakarīgi, ka autoservisi ir izteikuši interesi iegādāties tādu pašu aprīkojumu, lai varētu pilnvērtīgi sagatavot automašīnas tehniskajai apskatei. “Inter Cars” sortimentā ir dažādi piedāvājumi – lūk, daži piemēri.
Šis analizators ir pirmais no “Texa” ierīču jaunās paaudzes cieto daļiņu koncentrācijas izplūdē mērīšanai. NP 01 analizatorā tiek izmantota difūzijas mērīšanas metode. Ar līdzstrāvas devēju aprīkotā ierīce darbojas 23–200 Nm (nanometru) mērījumu diapazonā. Reakcijas laiks –15 sekundes. 5 collu skārienekrāns nodrošina vienkāršu un intuitīvi saprotamu vadību, bet Wi-Fi un USB tiek izmantoti sakariem ar ārējām ierīcēm. Ierīce izstrādāta atbilstoši tehniskajām specifikācijām, kas noteiktas Nīderlandes N-PTI un Vācijas PTB-A 12.16 reglamentā.

Detalizētāku informāciju par minēto iekārtu izmantošanas un arī to periodiskās apkopes niansēm var saņemt pie “Inter Cars” speciālistiem.
 Texa NP 01
Texa NP 01
INTER CARS aktualitātes 31
Bosch BEA 090
Šajā ierīcē tiek izmantota kondensācijas mērīšanas metode. Iekārta ir gatava lietošanai pēc īsas iesildīšanas. Mērījums tiek veikts, automobiļa izplūdes caurulē vienkārši ievietojot BEA 090 zondi kopā ar uzsildītu izplūdes gāzu paraugu ņemšanas cauruli. Datu apstrādei tiek izmantota iepriekšējos modeļos (Euro 1 – Euro 5) pārbaudītā BEA programmatūra, savukārt pats analizators tiek pieslēgts diagnostikas datoram, izmantojot “Bluetooth”. Pēc katra mērījuma daļiņu skaitītājs tiek iztīrīts. Turklāt automātiskā tīrīšana likvidē daļiņas visā gāzejā, sistēmu izslēdzot. Obligātā ikgadējā kalibrēšana “Bosch” servisa darbnīcā garantē augstu mērījumu precizitātes līmeni.
MAHLE Brain Bee PMU 400
“Mahle” analizators balstīts uz to pašu CPC metodi, proti – mērījumiem arī nepieciešams izopropilspirts. 250 ml ietilpības rezervuārs paredzēts 80 darba stundām, kas ir pietiekami 1000–2000 izmēģinājumiem. Tā kā izopropilspirts ir higroskopisks, ir jāveic piesardzības pasākumi, lai novērstu

Bez ārējiem filtriem, kurus var viegli nomainīt, BEA 090 nav nolietojamu detaļu, kas būtu jānomaina ārpus ikgadējās apkopes. Mērīšanas tehnika analizatora iekšpusē nav jātīra. Ja nepieciešams, jānomaina tikai pudele ar mērījumos izmantojamo izopropilspirtu. Šai procedūrai nav nepieciešami nekādi instrumenti, un turklāt lietotājs nesaskaras ar izopropilspirtu. Tāpat kā visām “Bosch” BEA sērijas ierīcēm, jaunajam analizatoram ir izturīgs korpuss, bet,

pateicoties samērā nelielajam svaram un praktiskajam rokturim, ierīci ir viegli transportēt.
ūdens vai ūdens tvaiku iekļūšanu spirta rezervuārā. Ierīce ir kompakta, darbojas gan no stacionāra elektrotīkla, gan arī no 12 voltiem. PMU 400 var izmantot gan vieglo auto, gan arī komerctransporta izplūdes pārbaudei. Analizators savietojams ar citām diagnostikas līnijas ierīcēm.


Starp citu, kāpēc “Mahle” ierīcei ir “Brain Bee” logotips un ko tas nozīmē? Lieta tāda, ka 2017. gadā “Mahle” iegādājās akciju paketi Itālijas uzņēmumā “Brain Bee”, kas specializējas diagnostikas un servisa iekārtās, kā arī programmatūrā. “Brain Bee” inženieru pieredze un daži nestandarta risinājumi izrādījās visai interesanti un tika izmantoti “Mahle” iekārtās, bet “Mahle” iespējas savukārt palīdzēja uzņēmumam “Brain Bee” apgūt jaunus tirgus.

INTER CARS aktualitātes 32
EVolucionizēts,



 lai sniegtu vairāk jebkuros laikapstākļos
lai sniegtu vairāk jebkuros laikapstākļos
IELU MOTOCIKLU RIEPAS IZVĒLES PARAMETRI UN NIANSES
Saskaņā ar CSDD statistiku, ar katru gadu reģistrēto motociklu skaits pieaug. Proti –motociklistu kļūst arvien vairāk. Ievērojama daļa no pirmo reizi reģistrētajiem motocikliem ir lietoti. Pieredzējuši baikeri saka, ka, iegādājoties lietotu motociklu, būtu ļoti noderīgi nomainīt riepas. Cilvēkam, kurš nesen papildinājis motociklistu rindas, var rasties jautājums: kāpēc tas jādara, ja riepas izskatās normāli, bet ja nu tomēr tiek mainītas – tad pamatojoties uz kādiem parametriem?

Kā zināms, riepām ir divi savstarpēji izslēdzoši parametri: saķeres īpašības un resurss. Protams, ka motociklu riepu gadījumā prioritāte tiek atdota saķeres īpašībām. Automašīnām ir četri atbalsta punkti, bet motociklam tikai divi, turklāt vidēja pilsētas motocikla riepu saskares punkta laukums ir salīdzināms ar bankas kartes laukumu. Nav jāpaskaidro, cik daudz ir atkarīgs



no saķeres ar virsmu šajos divos mazajos plankumiņos. Kāpēc pieredzējuši baikeri iesaka mainīt riepas pat tad, ja tās izskatās pieklājīgi? Viss ir vienkārši: motociklu riepas daudz kritiskāk izturas pret pārkaršanu, ilgstošu nepareizu uzglabāšanu utt. Turklāt nav saprotams – kā un kādos režīmos ir braucis nopirktais lietotais motocikls un arī cik ilgi un kur tas ir stāvējis uzglabāšanā.
Riepu lietošanas mērķis
Kas ir svarīgi, izvēloties riepas – dimensijas un marķējums? Jā, taču ar to problēmu parasti nav: šie dati tiek norādīti pārdodot, un internetā ir daudz informācijas par šo tēmu.
Svarīgs ir riepu lietošanas mērķis – it īpaši, ja runa ir par tā dēvēto ielas motociklu riepām. Vienam un tam
INTER CARS aktualitātes 34


pašam motociklam viena ražotāja līnijā var tikt piedāvāti 5–10 modeļi, un tās visas būs riepas braukšanai pa asfaltu. Galvenais jautājums – kādai braukšanai.
Raksta sākumā tika runāts par tādiem parametriem kā resurss un saķere ar ceļu, taču tas ir vienkāršoti. Dažādiem riepu modeļiem ir atšķirīga prioritāte: maksimāla saķere ar sausu vai slapju asfaltu? Aukstā vai karstā laikā? Baikeri ar stāžu asfalta riepas nosacīti iedala trīs kategorijās: tūrisma, pilsētas un treka vai “fanu” riepas. Arī tas ir vienkāršoti, bet ar tādu piemēru ir vieglāk parādīt starpību parametros – turklāt nodemonstrēt ar skaitļiem un faktiem. Protams, ka labāk aplūkot kāda pazīstama ražotāja kvalitatīvas riepas.
Nosacītie tipāži
Tātad, tūrisma riepas parasti ir riepas jebkādiem laikapstākļiem. Dažiem modeļiem resurss var sasniegt 20−30 tūkst. km vai vairāk. Pēdējo desmit gadu laikā motociklu riepu izgatavošanas tehnoloģiju ziņā ir veikts nopietns izrāviens, un ar labām tūrisma riepām pilnībā iespējams, kā saka baikeri, “veikt pagriezienus līdz ceļgalam” – proti, tos izbraukt kārtīgā slīpumā. Šeit ir zināma atruna, bet par to nedaudz vēlāk.
Vidējas pilsētas riepas arī parasti ir arī riepas jebkuriem laikapstākļiem, taču nedaudz lielāks uzsvars tiek likts uz saķeri uz sausa asfalta. Resurss ir nedaudz mazāks: līdz 15−20 tūkst. km. Pagriezienus izdodas izbraukt vēl asāk, ar šādām riepām var pat pabraukt pa treku, bet
mērenā tempā un ne pārāk ilgi. Treka (“fanu”) riepas – tā ir vēl lielāka prioritāte saķerei uz sausa asfalta. Sliktāk tās ir adaptētas braukšanai lietū (sliki nemaz arī nav paredzēti lietum), un aukstā laikā braukšana ar šādām riepām var būt bīstama. Proti – diez vai tas var būt universāls variants tiem, kuri pieraduši sezonu sākt pie +5 ºC. Šādu riepu resurss lielā mērā ir atkarīgs no braukšanas režīmiem, bet reti pārsniedz 5−10 tūkst. km.
Cietība
Tiek uzskatīts, ka treka riepas ir mīkstākas un elastīgākas, bet tūrisma riepas – cietākas un izturīgākas. Kā šo cietību izmērīt? Ir tāda ierīce – durometrs Šora cietības noteikšanai, taču ar to veikalā mērīt riepas un, pamatojoties uz to, izdarīt
INTER CARS aktualitātes 35
secinājumus – diezin vai ir optimāls risinājums. Ņemsim divus polus: tūrisma riepas un treka riepas. Sarežģīti ir tas, ka istabas temperatūrā abas riepas nesasildītā stāvoklī (piemēram, veikalā) var demonstrēt aptuveni vienādu gumijas sastāva cietību: apmēram 65 Šora vienības. Citā temperatūrā aina mainās, turklāt būtiski.

Pie +5 ºC tūrisma riepas cietība var būt 68−75 pēc Šora, bet treka riepas –80 vai vairāk: kā saka baikeri – tā jau ir gandrīz plastmasa. Starp citu, treka slikiem ir aptuveni tās pašas īpašības. Mūsdienu riepas bieži tiek izgatavotas kā divkomponentu, proti – tām ir atšķirīga cietība dažādās protektora zonās: centrā un sānos. Pārbaude ar durometru istabas temperatūrā atkal neko neparāda: displejā tāpat būs tās pašas aptuveni 65 vienības visur. Viss mainās +40 ºC: sāni kļūst mīkstāki. Tūrisma riepas cietības ziņā zaudē mazāk: Šora rādītājs uz sāniem var būt aptuveni 58−60, bet treka – 52−55. Kāpēc aprēķina parametrs ir tieši +40 ºC? Tā ir aptuveni tā temperatūra, līdz kādai riepas sasilst, braucot taisni, pat ja ārā ir +10 ºC.
Sasilšana un pārkaršana
Vēl interesantāk situācija izskatās +60 ºC. Treka riepa kļūst maksimāli mīksta un elastīga: protektora centrā Šora cietība var būt 62−64, bet sānos – mazāka par 50 (piemēram, 46−48). Salīdzinājumam – 40 ir cietība dzēšgumijai, ko izmanto zīmuļa dzēšanai no papīra. Tūrisma riepa +60 ºC protektora centrā demonstrē 63−65, sānos aptuveni 55. Daļēji tas ir salīdzināms ar treka riepu rādītājiem pie +40 ºC, un baikeri saka, ka pat ar tūrisma riepām var “ielikt līdz
elkonim”, proti – pagriezienos braukt dziļā slīpumā, bet pavisam neilgi: ne vairāk kā vienu treka apli, jo šādas riepas vienkārši pārkarsīs.
Protams, ka karstā laikā, pat braucot pa koplietošanas ceļiem, tūrisma riepas var uzsilt līdz tiem pašiem +60 ºC, taču šajā gadījumā tas nav tik kritiski, jo parasta braukšana un treka režīms ir absolūti dažādas lietas riepu slodzes un vadāmības ziņā. Tie, kas ir mēģinājuši pabraukt pa treku sporta režīmā ar tūrisma riepām, zina, kas ir pārkaršana: riepa it kā “peld”, motocikla aizmugure sāk mesties no vienas puses uz otru. Šī parādība ir visai bīstama.
Gumijas maisījuma sastāvs
Atkarībā no lietošanas mērķa riepas atšķiras pēc protektora, karkasa un gumijas maisījuma sastāva. Bez kaučuka, pildvielas, plastifikatoriem un piedevām ir divi ļoti svarīgi komponenti: silika (silīcija dioksīds) un ogleklis (carbon), vienkāršāk sakot – sodrēji. Silika ir komponents, kas savulaik radīja revolūciju riepu ražošanas tehnoloģijā. Pateicoties silikas klāt būtnei, uzlabojās riepu saķere ar virsmu – pat ar slapju un zemā temperatūrā, samazinājās rites pretestība un pa lielinājās resurss. Taču silīcija dioksīdam nepatīk augsta temperatūra un liela pārslodze, savukārt ogleklis gan, gluži pretēji, šādus apstākļus iztur diezgan sta bili. Citiem vārdiem sakot, galvenā atšķi rība starp riepām ar dažādiem lietošanas mērķiem būs silīcija dioksīda daudzums un dažreiz arī vienkārši tā esamība. Tūrisma riepās būs diezgan daudz silīci ja dioksīda, pilsētas riepās, iespējams, mazliet mazāk, bet treka riepās tā var būt pavisam nedaudz vai nebūt vispār. Vien laikus ogleklis ir visās riepās: gan tūrisma, gan pilsētas riepās – runa ir par daudzumu.
Vēl viena nianse saistībā ar treka riepām, pirmām kārtām – sacīkšu
slikiem. Tā kā šādās riepās ir daudz oglekļa, tad lielākas elastības un “lipīguma” labad to sastāvā bieži ir vairāk eļļainu substanču. Riepai sasilstot un dilstot, šīs substances izdalās un riepa neatgriezeniski sacietē. Dažreiz pietiek ar 5−6 nopietniem braucieniem un riepas formāli var norakstīt. Tas nozīmē, ka izmantot slikus, ar kuriem jau ir intensīvi braukts un kas ir gadu vai divus veci, nav pati labākā ideja drošības ziņā. Tūrisma riepu gumijas maisījumā arī ir eļļas, un arī tās laika gaitā pazūd, taču tas notiek daudz lēnāk.
Karkass
Svarīgs elements, kas atbild par riepas ilgizturību, ir karkass. Divas vizuāli līdzīgas riepas var būtiski atšķirties cietības ziņā: vienu riepu viegli var iespiest ar roku, bet otra šķiet ļoti cieta. Riepa ar mīkstu karkasu sasils daudz ātrāk: dažreiz pietiek tikai ar vienu kilometru. Vēl viena priekšrocība ir komforts.


INTER CARS aktualitātes 36


Tūrisma riepas var atšķirt ne tikai pēc protektora raksta, bet arī pēc svara − parasti tās ir smagākas: karkass ir cietāks un masīvāks, gumijas maisījuma slānis –biezāks. Diezgan lielais silikas daudzums gumijas maisījuma sastāvā padara riepas samērā piemērotas jebkuriem laikapstākļiem. Tūrisma riepas sasilst ilgāk, stundām ilga braukšana nerada pārkaršanas draudus, bet trekā šādas riepas var pārkarst pat vienā aplī.

Vidēji statistiskām pilsētas riepām parasti ir diezgan mīksts karkass, tādēļ tās ātri uzsilst un nodrošina komfortablāku braukšanu. Šādas riepas jebkādos laikapstākļos ir diezgan labs kompromiss starp labu saķeri ar virsmu un izturību. Tirgū tiek piedāvāts daudz modeļu ar prioritāti vienā vai otrā virzienā.

Mīksts karkass parasti ir pilsētas riepām. Tūrisma riepas ar cietu karkasu sasilst ilgāk (dažreiz jānobrauc 20−30 minūtes), bet atdziest ātri, toties tāda gumija labi iztur garus ceļa posmus. Vai iepriekš teiktais nozīmē, ka treka riepām ir mīksts karkass? Ne vienmēr, bieži vien tas ir pietiekami ciets, jo trekā svarīga ir atgriezeniskā saite. Ja karkass ir pārāk mīksts, tad, strauji pārkārtojoties, karkass “pārliekas” un motocikls uz stūrēšanu reaģē nedaudz novēloti. Tas nav komfortabli vadāmības ziņā un ir bīstami.
Jebkurai medaļai ir divas puses: riepas ar mīkstu karkasu ir mazāk izturīgas: pastāvīgu spēcīgāku deformāciju dēļ gumija ātrāk nodilst. Pēc zināma nobraukuma riepas ar mīkstu karkasu kļūst plakanas centrā. Uz taisna ceļa tas var šķist pat pluss – stabilitāte ir nedaudz augstāka, bet pagriezienos ieiet ir grūtāk: riepa it kā pārveļas pāri ribai. Karkasa cietība ne vienmēr ir saistīta ar korda slāņu skaitu, atšķirība var būt pašā materiālā.

Arī treka (“fanu”) riepas sasilst diezgan ātri, tomēr karkass tām ir nedaudz cietāks. Svarīga nianse: nevis masīvs kā tūrisma riepām, bet tieši ciets – lai nodrošinātu atgriezenisko saiti, ātrgaitā veicot pagriezienus. Gumijas maisījumā silīcija dioksīda ir ļoti maz vai nav vispār. Galvenā prioritāte – saķere uz sausa asfalta, izturība pret pārkaršanu no treka slodzēm ir augsta, bet resurss nebūs liels.

Karkass arī nosaka profila formu: treka un pilsētas riepām vidus dažreiz ir šaurāks, bet sānu daļas ir attīstītas: tas liecina, ka riepa galvenokārt ir paredzēta braukšanai līkumos. Tūrisma riepām centrālā daļa var būt mazliet platāka, jo to galvenais uzdevums ir ilgstoša braukšana taisni. Starp citu, tūrisma riepas bieži vien ir cietākas arī tāpēc, ka gumijas maisījuma slānis ir biezāks. Salīdzinot ar pilsētas riepu modeli uz tāda paša motocikla, atšķirība var būt 1−1,5 kg. Treka braucienos lieks kilograms vai pusotrs neatsperotas masas ir būtiski, garākos ceļa posmos tas nav īpaši svarīgi.
Protams, ka vienā īsā materiālā nav iespējams aprakstīt visas riepu īpašības, jo daudzveidība ir pārāk liela. Jāatzīmē arī tas, ka sniegtā informācija ir vispārīga: katram ražotājam ir sava pieeja riepu izgatavošanā: tas attiecas gan uz formu, gan cietību, gan gumijas maisījuma sastāvu, gan protektoru. Būdami savas nozares profesionāļi, “Inter Cars” motociklu struktūrvienības “Inter Motors” speciālisti var pastāstīt vēl par daudzām niansēm, taču viens no pirmajiem jautājumiem, ko viņi uzdos klientam, būs: “Kam tieši riepas vajadzīgas un kā jūs plānojat braukt ar motociklu?”
INTER CARS aktualitātes 38
VI SĀS AU TO DA Ļ ĀS SP Ē K S
“Motul” saviem par tneriem piedāvā spēku vis ās autodaļās – ar mūsu ser visa k valitāti esot paš ā kodolā Kā pieredzējuši speciālisti mē s atbalstām autodarbnīcas un specializētos izplatītājus, lai palīdzētu viņiem sasniegt savus mērķus un ambīcijas Uz ticība mums ir tas, kas padara “Motul” unikālu un jūsu biznesu veiksmīgu

S E K O MUM S
SIKSNAS PIEDZIŅAS KOMPONENTI GATES SEMINĀRS

Kompānijas “Inter Cars” organizētā semināra ietvaros “Gates” pārstāvis Džeisons Fords (Jason Ford) pastāstīja par piedziņas komponentu – siksnu, spriegotāju un dzesēšanas šķidruma sūkņu konstrukciju. Pietiekami detalizēti tika aplūkota tēma par siksnām eļļas vannā, jo arvien vairāk kļūst automašīnu ar šādu GSM piedziņu, savukārt īpaša uzmanība tika veltīta servisa jautājumiem.
Sūkņa nomaiņa
Prakse liecina, ka bieži vien nopietnu problēmu un dārgi maksājošu seku iemesls ir vienkāršu ieteikumu neievērošana. Aksioma: mainot GSM siksnu, ieteicams nomainīt arī dzesēšanas šķidruma sūkni. Šķietami vienkārša procedūra, tomēr, saskaņā ar “Gates” reklamāciju nodaļas statistiku, aptuveni 80% sūkņa priekšlaicīgas atteices gadījumu ir saistīti ar montāžas kļūdām.
Dažkārt dzesēšanas šķidruma sūknis neatgriezeniski tiek sabojāts jau pirms uzstādīšanas. Izņemot sūkni no kastes, var rasties vēlme šurp turp pagriezt tā skriemeli vai spārnu ratu. Tā darīt nevajag. Sūkņa blīvējumi ir paredzēti darbam antifrīza klātbūtnē, kas šajā gadījumā darbojas kā sava veida smērviela. Pat īslaicīga darbība sausā veidā var sabojāt blīvējumus. Rezultātā jaunajam sūknim var rasties sūce uzreiz pēc uzstādīšanas. Runa nav par zināmu daudzumu antifrīza, kas pēc pirmās palaišanas var iztecēt no drenāžas atveres (tas ir normāli), bet gan par sistemātisku noplūdi.
Pirms uzstādīšanas sūkni ieteicams iegremdēt tīrā antifrīzā un pagriezt skriemeli, veicot apmēram desmit apgriezienus – tā tiks izveidota šķidruma plēve starp statisko un dinamisko blīvgredzenu. Ir vēl viens veids: uzstādīt sūkni, uzpildīt sistēmu ar antifrīzu un manuāli pagriezt sūkni apmēram tās pašas desmit reizes.
Sistēmas skalošana
Protams, nomainot sūkni, ir jānomaina arī antifrīzs. Turklāt svarīgi ir sistēmu izskalot. Pirmkārt, vecā antifrīza paliekas satur korozijas produktus un mehāniskus piemaisījumus. Tas ir ļoti svarīgi: vien 50 mikronu (0,05 mm) lielas mehāniskās daļiņas var sabojāt jauna sūkņa blīvējumus. Otrs faktors –autoīpašnieks ne vienmēr atceras, kāds antifrīzs sistēmā ir bijis. Jaunais antifrīzs var atšķirties ar piedevu komplektu, un tāpēc tā sajaukšana ar vecā paliekām ir ļoti nevēlama. Piedevu konflikta rezultātā jaunais antifrīzs

“Gates PowerGrip” komplektā iekļauts ūdens sūknis un blīve. Ja komplektā jau ir blīvējums, tad nekādā gadījumā nevajag uzklāt papildu hermētiķi.
var zaudēt savas īpašības, un sliktākajā gadījumā var izveidoties želeja.
Lai pareizi izskalotu sistēmu, “Gates” iesaka izmantot speciālu ierīci: “Power Clean Flush Tool”. Šis instruments rada spēcīgu, kontrolējamu plūsmu un likvidē netīrumus pat no grūti sasniedzamām vietām, nebojājot sistēmas komponentus. Skalošana jāveic ar veco sūkni, lai jauno neaizsprostotu ar sistēmā uzkrātajiem netīrumiem. Svarīga nianse: lai pareizi nomainītu antifrīzu un izskalotu sistēmu, mūsdienu automašīnām bieži vien nepieciešama diagnostikas iekārta.
INTER CARS aktualitātes 40


Siksnas un spriegotāji
Ideālos apstākļos GSM siksna viegli iztur norādīto kalpošanas laiku, bet ne vienmēr reālos apstākļos. Tāpat kā ar sūkņiem – arī priekšlaicīgs siksnas nodilums bieži ir uzstādīšanas kļūdu rezultāts: spriegojums ir vai nu pārāk vājš, vai pārmērīgs.
Vienkāršākais uzstādīšanas instrukcijas iegūšanas veids –noskenēt QR kodu uz kastes.

“Gates Power Clean Flush Tool” (numurs katalogā − 91002) likvidē uzkrājušos netīrumus un katlakmeni, neizmantojot agresīvas ķīmiskas vielas un šķīdinātājus. Instruments rada šķidruma pulsāciju, būtībā – dozētus hidrotriecienus. Izmantojot šo ierīci, var izskalot radiatorus, ūdens sūkņus un termostatus, siltummaiņus, šļūtenes un dzinēja blokus. Tehnoloģija ļauj izmazgāt netīrumus no tām vietām, kur tie parasti uzkrājas: stūriem, salaidumiem utt. “Power Clean Flush Tool” uztur drošu spiedienu, tādējādi tiek saglabāts sistēmas veselums un detaļu pārklājums. Pilns uzgaļu un savienotāju komplekts ļauj izmantot skalošanas ierīci visdažādākajiem uzdevumiem.
Spriegotāji vizuāli ir atšķirīgi, bet savstarpēji aizstājami. Galvenā atšķirība uzstādot ir tāda, ka “Gates” spriegotājam jāgriežas pretēji pulksteņrādītāja virzienam, savukārt “Litens” spriegotājam jāgriežas pulksteņrādītāja virzienā.
Praksē ir pietiekami daudz tamlīdzīgu piemēru. Lai nodrošinātu pareizu montāžu, “Gates” GSM nomaiņas komplektu kastēs ir “Autodata” instrukcija ar shēmām un paskaidrojumiem. Daudz noderīgas informācijas var atrast arī informatīvajos materiālos, kas pieejami resursā www.gatestechzone. com vai uzņēmuma “YouTube” kanālā.
Siksna eļļas vannā
Siksnas spriegojuma kļūdas skaidrojamas ar konstrukciju pārpilnību un nespēju paturēt prātā visas nianses. Pat ja šķiet, ka viss ir skaidrs, noteikti nebūs lieki ieskatīties instrukcijā, jo gadījumi mēdz būt ļoti sarežģīti. Vadītājs minēja pāris piemērus – lūk, viens no tiem –regulāri minēts, bet visai aktuāls. VW 1,2 / 1,6 / 2,0 l dīzeļdzinējiem spriegotājveltnīšus konveijeram piegādāja divi uzņēmumi: “Gates” un “Litens”.
Katram GSM piedziņas veidam – siksnas vai ķēdes – ir savas priekšrocības un trūkumi. Siksnas izveide, kas spēj darboties dzinēja eļļas vidē, ļāva apvienot abu konstrukciju priekšrocības, rezultātā iegūstot gandrīz beztrokšņa darbību, mazākus dzinēja gabarītus un svaru, inerces momenta samazinājumu, berzes koeficienta samazināšanos un degvielas efektivitātes palielināšanos utt. Patlaban uz Eiropas ceļiem jau ir vismaz 10 milj. automobiļu ar šādu GSM piedziņas shēmu. Kā piemēru var minēt “Peugeot”, “Honda” vai “Ford” motorus, tostarp labi zināmo
INTER CARS aktualitātes 41

“Ecoboost” 1,0 l, kuram dzinēju siksnas komplektus “Gates” piegādā gan autoražotāja konveijeriem, gan arī neatkarīgajam rezerves daļu tirgum.
“Gates” sortimentā siksnas, kas paredzētas darbībai eļļas vannā, tā arī tiek sauktas: “Belt-in-Oil”. Kā zināms, tradicionālajām siksnām eļļa ir agresīva vide, tāpēc, izstrādājot “Belt-inOil” siksnas, galvenais jautājums bija materiālu izvēle. Šādās siksnās zobainā puse ir aizsargāta ar eļļizturīga kombinēta auduma pārklājumu, bet otra puse ir pārklāta ar eļļizturīgu neilonu. Daudzslāņu un arī eļļizturīgais kompaunds satur paaugstināta blīvuma stikla šķiedras kordus, kas piesūcināti ar speciālu un tāpat pret eļļas ietekmi izturīgu vielu. Izmantojot piekļuvi oriģinālajām specifikācijām, “Gates” inženieri ņēma vērā visas autoražotāju prasības un vienlaikus radīja zināmu rezervi izturības ziņā. Izmēģinājumu rezultāti parādīja, ka “Gates” siksnas “Belt-in-Oil” tipa piedziņām demonstrē par aptuveni 30% lielāku resursu.
“Belt-in-Oil” komplektā ietilpst tieši sadales vārpstas siksna, eļļas sūkņa
“Ford Ecoboost” 1,0 l dzinējs ar “Belt-in-Oil” siksnas piedziņu. Konstrukcijas kompaktums un zemais trokšņa līmenis tiek kompensēts ar darbietilpību, nomainot siksnu komplektu: procedūra var aizņemt līdz 12 stundām, ņemot vērā visu salikšanas un izjaukšanas procesu. Saskaņā ar autoražotāja ieteikumu, kloķvārpstas skrūve jāpievelk ar speciālu multiplikatoru, lai ievērotu diezgan lielo savilkšanas spēku – 450 Nm.

siksna, spriegotājs un zvaigznīte. Citiem vārdiem sakot, konstrukcija paredz divas siksnas un jāmaina ir tās abas. Eļļā tiek iegremdēta apakšējā – eļļas sūkņa siksna, bet uz augšējās siksnas, kas pievada sadales vārpstu, eļļa nonāk izsmidzinoties. Dažādi autoražotāji deklarē dažādu “Belt-inOil” piedziņas siksnu kalpošanas laiku, piemēram – tas pats “Ford” norāda, ka siksnas spēj nokalpot līdz 200 tūkst. km. Teorētiski tas ir iespējams, tomēr daudzi autoīpašnieki cenšas neizaicināt likteni un minētās siksnas mainīt pie divreiz mazāka nobraukuma.
Kad uz apkopi atbrauc automašīna ar tādu GSM piedziņu, noderīgi būs paskatīties motoreļļas stāvokli – tā var norādīt, ka laiks mainīt siksnas. Kāda ir nianse: neraugoties uz kompaunda un korda eļļizturību, fizikas likumus neviens nav atcēlis. Eļļa sagrauj pat eļļizturīgus gumijas sastāvus, tikai tas notiek daudz lēnāk, turklāt savu artavu dod mehāniskā berze un temperatūra. Prakse liecina, ka siksnas darbojoties tomēr nedaudz rada putekļus, un laika gaitā no tām dažkārt sāk krist nost nelieli gumijas
kompaunda gabaliņi – iemesls var būt gan skarbi ekspluatācijas apstākļi, gan arī neatbilstošas eļļas izmantošana. Šīs mehāniskās daļiņas nonāk karterī un pēc tam aizsprosto eļļas uztvērēju. Kādas ir hroniska eļļas bada sekas –paskaidrot nevajag. Starp citu, “Gates” piedāvā vienkāršu instrumentu, kas ļauj noteikt “Belt-in-Oil” siksnas stāvokli (sk. fotoattēlu).


Vienkāršs Gates instruments
Belt-in-Oil shēmas ķēdes stāvokļa pārbaudei. Ja šo metāla dakšiņu var uzlikt uz siksnas, tad tā vēl ir darbderīga. Taču ja siksna ir uzbriedusi un uz tās dakšiņu uzlikt nevar, tad siksna ir jāmaina.
Tika pastāstītas daudzas tamlīdzīgas praktiskas nianses, un tieši tās izraisīja lielāko interesi no semināra dalībnieku puses, no kuriem vairums bija autoservisu pārstāvji. Instrukcijas un informatīvie biļeteni nenoliedzami ir ļoti noderīgi materiāli, taču komunikācija klātienē ar komponentu ražošanas uzņēmuma pārstāvi ļauj uzzināt tādas nianses, kas ne vienmēr ir rakstītas instrukcijās.
INTER CARS aktualitātes 42



POWERGRIP™ ZOB SIKSNA



POWERGRIP™ ŪDENS SŪKNIS
POWERGRIP™ SPRIEGOTĀJS




MICRO -V® ŪDENS SŪKNIS
MICRO -V® ĢENER ATOR A SKRIEMELIS (OAP)





MICRO -V® SPRIEGOTĀJS




MICRO -V® VADOŠAIS RULLĪTIS

MICRO -V® CELIŅU SIKSNA



MICRO -V® VĒRPES VIBRĀCIJU SLĀPĒTĀJS ( T VD)




Piedziņas siksnas sastāvdaļas strādā kā vienot s mehānisms. Problēma ir tāda, ka katra sastāvdaļa nolietojas savā laikā. Un piedziņas sistēmas kopējā veik t spēja sāk mazinātie s Šeit ir saskatāma līdzība ar motospor ta komandām –uzvarētājām. Tās zina, ka viena neveiksme var maksāt čempiona titulu
“Gate s” kopā ar par tneriem oriģinālā aprīkojuma jomā saprot, kā ir būt daļai no uzvarošās komandas. Tāpēc, kad pienācis laiks mainīt siksnu, mēs ie sakām vienlaikus veik t visu piedziņas sistēmas komponentu nomaiņu Tas ir viegli izdarāms ar “Gate s” Micro-V ® un PowerGrip™ komplek tiem Tajos atradīsiet visas kapitālajam remontam nepieciešamās oriģinālā aprīkojuma k valitāte s daļas





GATE S TEC HZONE .COM
© GATES 2024 - All rights reser ved











GATE S . Uzt icama OE k valitāte , st abila veik t s pēja , mazāk at griezto preču un laimīgāki klient i .
















MICRO -V® KOMPLEKTI














POWERGRIP™ KOMPLEKTI



U M M A IR U Z V A R O Š Ā
VISU DAĻU S
KOMANDA
AR “MOTOINTEGRATOR.LV” ATBALSTU VĒRIENĪGI AIZVADĪTS
“SIEVIEŠU RALLIJS 2024”!
Par “Sieviešu ralliju” labāks var būt tikai “Sieviešu rallijs”! Tā, visticamāk, teiktu visas dāmas, kuras 9. martā sēdās pie auto stūres, lai izbaudītu braukšanas prieku, sacensību garu un azartiskā orientēšanās spēlē parādītu savu erudīciju, atjautību, plānošanas spējas. Par iespējamām ķibelēm nevienai ekipāžai nebija jāsatraucas, jo par palīdzību uz ceļa gādāja rallija lieldraugs “Motointegrator.lv”.
“Sieviešu rallijs 2024” pēc trīs gadu pauzes atgriezās ar tiešām iespaidīgu vērienu, krāšņiem dāmu tērpiem, žilbinošiem smaidiem un vērā ņemamu dalībnieču skaitu. Tajā piedalījās 1858 dāmas, kuras kopskaitā veidoja 499 komandas. Var teikt, ka autoceļi Rīgas, Tukuma un Engures apkaimē šajā dienā piederēja sievietēm, un daiļā dzimuma pārstāves pārliecinoši pierādīja, ka azartiski traukties pa ceļu un ķert adrenalīnu iespējams arī skrupulozi ievērojot visus ceļu satiksmes noteikumus. No teju 500 komandām brīdinājumus par ceļu satiksmes noteikumu neievērošanu saņēma vien 15 komandas, bet diskvalificēta netika neviena ekipāža.

Pie stūres tikai sievietes!
“Inter Cars Latvija” projekta “Motointegrator.lv” vadītājs Ivars Klints norāda: ““Motointegrator.lv” tāpat kā “Sieviešu rallijs” ir par to, lai ceļu satiksme būtu baudāma, patīkama un bez raizēm ne vien sacensību laikā, bet arī katru dienu.” Rallija lieldrauga “Motointegrator.lv” komandas uzdevumos bija arī rūpes par atbalsta sniegšanu ekipāžām, kurām brauciena laikā gadītos tāda nepieciešamība. “Mūsu partneri autoservisi
bija kaujas gatavībā, bet, par laimi, viņu palīdzība nebija nepieciešama. Nevienu auto nekāda ķibele nepiemeklēja, un dāmas ar savu uzdevumu tika galā godam,” gandarīts ir Ivars Klints.
Rallijā varēja pieteikties gan draudzeņu un uzņēmumu komandas, gan arī darba kolektīvi. Pats galvenais noteikums – piedalīties drīkst tikai un vienīgi sievietes, turklāt obligāta bija arī reģistrācija lietotnē “Roadgames”, pēc kā dalībnieces varēja lejuplādēt spēles aplikāciju. Tās ekipāžas, kuras spēles laikā ieguva visvairāk punktu, arī plūca “Sieviešu rallija” uzvarētāju laurus.
INTER CARS aktualitātes 44
Specbalvas ieguvēju komanda no Jēkabpils “Palete ar meitenēm”, kuras rallijā devās ar smago automašīnu!




Lieliska komanda un foršs piedzīvojums
Anete Zalkovska “Sieviešu rallijā” piedalījās pirmo reizi, un viņai tika atbildīgais auto pilotēšanas uzdevums. Anete saka, lai arī vārds “rallijs” it kā uzliek pienākumu braukt pēc iespējas ātrāk, tomēr viss bija CSN nospraustajās robežās, nekāda ātruma pārsniegšana nemaz nevarēja notikt un kaislības galvenokārt vērpās ap
pildāmajiem uzdevumiem. “Mēs savā sarkanajā “Škoda Fabia”, īstā dāmu rallija mašīnā, bijām četras kolēģes, un izveidojās tiešām lieliska komanda. Tas bija tāds foršs piedzīvojums, kurā kopā braukšanas un uzdevumu pildīšanas laikā katrā atklājās kaut kas jauns un neredzēts. Mans uzdevums bija auto vadīšana, bet pārējo meiteņu ziņā bija maršruta izvēle, taktiskā domāšana un koordinēšana, jo skaidrs, ka pilots pats neizvēlas, kurp
“Motointegrator” komanda starta lēcienā. No kreisās – Anete, Agita, Anita, Patrīcija .
braukt, bet seko norādēm. Tas bija kā īstā rallijā! Paralēli bija mīklu minēšana, nācās arī domāt, kurš uzdevums ir ātrāk izpildāms un sniedz vairāk punktu,” atceres Anete.
Taujāta, kurš uzdevums šķitis sarežģītāks, Anete atklāj, tas bijis “Detektīvs”, kura laikā bija jāsavāc vairāki pavedieni, jāatklāj attēli un jāsaprot, kas tos vieno. “Ļoti interesanti bija arī jautājumi, uz kuriem bija jāizvēlas pareizās atbildes, un spēles gaitā uzzinājām daudz jauna. Tai skaitā arī to, ka visām sievietēm zināmo āķīšu aizdari krūštura aizmugurē izgudrojis rakstnieks
Marks Tvens!” (Ar vārdu Semjuels Lenghorns Klemenss viņš šo izgudrojumu patentēja 1871. gadā.)
Iespēja
sevi pārbaudīt
Anitu Rusku var dēvēt par pieredzējušu “Sieviešu rallija” dalībnieci, jo šis viņas kontā ir jau trešais dāmu rallijs. Anita atzīst, ka bija ļoti interesanti un, ja iepriekšējās reizes bija aptverta plašāka brauciena teritorija, tad šogad viss bijis vairāk digitalizēts. Viņa teic, ka tā bija lieliska iespēja pārbaudīt sevi, tu esi vai neesi komandas spēlētājs. “Būt vienā komandā visu dienu ar citām kolēģēm, kurām katrai ir savs raksturs un redzējums, kā kuri uzdevumi jāpilda, ir interesants
INTER CARS aktualitātes 45
Kad gabarīti pārspēj iespējas –komandai no Jēkabpils pēdējie metri līdz kārtējam kontrolpunktam jāveic skriešus.
pārbaudījums gan sadarbības, gan komunikācijas iespējai. Tam, cik ļoti tu esi gatavs strādāt komandā un paļauties vienam uz otru,” saka Anita. Viņa atzīst, ka šis rallijs vairāk līdzinās orientēšanās spēlei un izaicinājumu nav trūcis. Kā vienu no interesantākajiem viņa min uzdevumu “Nokrāso buferi”, kura laikā pie “Motointegrator.lv” partnera – autoservisa Piņķos –SIA “GMM Autopasaule” bija pareizā secībā jāsaliek kartītes, uz kurām uzrakstīts – kādi soļi un kādā secībā jāveic, lai šo darbu godam padarītu. “Apbrīnojami, bet dāmas zināja ļoti labi, kā to darīt, – par visām gruntēšanām, attaukošanām, pulēšanām – tur meitenēm ar zināšanām viss bija kārtībā,” atceras Anita.
Savukārt runājot par šī gada jaunumu – iespēju ar “Motointegrator.lv” starpniecību saņemt palīdzību uz ceļa, viņa saka: “Automašīna mūs nepievīla, un arī neizdarījām neko tādu, lai būtu jālūdz palīdzība. Tomēr “Motointegrator” aplikācijai vajadzētu būt jebkura autovadītāja tālrunī, jo, ja nu auto nonāk situācijā, kad palīdzība uz ceļa ir nepieciešama, tā ir ļoti laba iespēja ātri un kvalitatīvi iegūt pakalpojumu.” Viņa atzīst, iespējams, vīriešiem domāšana ir savādāka un ir lietas, kuras turpat uz ceļa viņi var paveikt paši, piemēram, nomainīt riepu, bet sievietēm iespēja praktiski jebkurā vietā palūgt atbalstu ir ļoti būtiska. “Tā ir tāda laba drošības sajūta, ka tu vari saņemt palīdzību, Vēl viens liels pluss ir, ka Eiropā “Motointegrator” platforma strādā divpadsmit valstīs un, ja gadījumā mašīnai kas notiek, ir iespēja atrast savā tuvumā kādu, kas var palīdzēt. Tā ir tāda elementārā drošība uz ceļa.”

Jaunas emocijas, adrenalīns un prieks
Atbildot uz jautājumu, vai arī nākamgad plāno piedalīties “Sieviešu rallijā”, Anita saka – dzīvosim, redzēsim. “Ja uzreiz teiktu, jā, noteikti piedalīšos, tas būtu ļoti pārgalvīgi un neapdomīgi, bet ja tāda iespēja būs, tad kāpēc gan nē!”

“Sieviešu rallijs” ir neaizmirstams festivāls ar draudzeņu kopā būšanu, krāsainiem tērpiem, unikālām frizūrām, košiem meikapiem un neatkārtojamiem autodizainiem. Kā atzīst rallija dalībniece Diāna Krone, tās zināmā mērā ir arī sava veida jaunas emocijas, adrenalīns, prieks, asaras un, ja iespējams, arī uzvara. “Tomēr galvenais ir kopā būšana,” saka Diāna. Turklāt Latvijas dāmām braukšanas prieks jau ir asinīs. Ne velti desmitajā “Sieviešu rallijā”, kurš norisinājās 2018.gadā,

“izgriezām pogas” iepriekšējai rekordistei Indijai un sasniedzām Ginesa rekordu nominācijā “Visvairāk sieviešu dalībnieču motorsporta pasākumā”. Toreiz piedalījās 702 ekipāžas un 1600 sieviešu. Nu ko, šogad dalībnieču ir vēl vairāk – 1858 dāmas.
Noslēgumā “Sieviešu rallijs 2024” dalībnieces gaidīja jaudīgs “After party” pasākums modes un izklaides centrā “Riga Plaza” ar labāko ekipāžu apbalvošanu, autoservisu pakalpojumu meklēšanas un rezervēšanas platformas “Motointegrator”, rallija oficiālā auto “Citroen”, kā arī citu rallija partneru sarūpēto balvu pasniegšanu un izspēlēšanu dažādos konkursos, Kārļa Būmeistera un “Coco Orchestra” koncertu un citiem pārsteigumiem. Īpaši jāatzīmē specbalvas ieguvēju komanda no Jēkabpils “Palete ar meitenēm”, kuras rallijā devās ar smago automašīnu! Šogad “Sieviešu rallijs”, ja tā var teikt, “uguņoja”. Ar nepacietību gaidām nākamo gadu!
INTER CARS aktualitātes 46
“Inter Cars” Ogres filiāles meitenes rallija finišā.






GaismasJaunumi
NIGHT BREAKER® LED GEN 2




Jaunākās paaudzes OSRAM H7 LED spuldzes, kuras paredzētas lietošanai uz koplietošanas ceļiem1)
OSRAM ir izstrādājis, optimizējis un pārveidojis jauno NIGHT BREAKER® LED GEN 2 H7. Tas pārsteidz ar uzlabotu inovatīvu optisko konstrukciju, kas nodrošina vairāk spilgtuma un tādējādi ļauj sasniegt labāku apgaismojumu. To raksturo efektīvāka siltuma pārvaldība, kas var samazināt siltuma slodzi. Ar OSRAM ielu legālajām1) LED spuldzēm jūs varat izmantot priekšrocības, ko sniedz augstas kvalitātes energoefektīvs, spilgts un moderns LED apgaismojums. Ar jaunajām ielu legālajām1) NIGHT BREAKER® GEN 2 H7-LED tagad varat uzlabot sava transportlīdzekļa tālās un tuvās gaismas lukturu funkciju ar modernāko LED tehnoloģiju. Šīs LED spuldzes ir piemērotas parasto H7 spuldžu nomaiņai tiem transportlīdzekļu modeļiem un gaismu funkcijām, kas patlaban ir uzskaitītas savietojamības sarakstā (www.osram.com/nb-led). Tās nodrošina modernu un spilgtu baltu gaismu ar krāsu temperatūru līdz 6000K un nodrošina līdz 230%. lielāku spilgtumu2), savukārt citu satiksmes dalībnieku apžilbināšana ir līdz pat 50% mazāka par pieļaujamajām maksimālajām normām2). Salīdzinot ar standarta gaismu, tā ir līdz pat 50% mazāka par pieļaujamo. Piemēram, halogēnspuldzēm, šīs LED maiņas spuldzes patērē līdz pat 60% mazāk enerģijas, pateicoties LED tehnoloģijai, kā arī LED spuldzes ir īpaši iestrādātas pret vibrācijām izturīgā konstrukcijā, kas nodrošina līdz pat 5 reizēm ilgāku kalpošanas laiku3). Turklāt OSRAM piedāvā īpašu garantiju visām NIGHT BREAKER® LED retrofit spuldzēm4).


par OSRAM produktu jaunumiem
Informācija

Īpašības
OSRAM izstrādāja, optimizēja un pārveidoja –Jaunās NIGHT BREAKER ® LED GEN-2 H7 (legālas uz ielas1)
tuvajām un tālajām gaismām
Uzlabots optiskais dizains)
Uzlabota elektroniskā uzvedība)
Lielāka gaismas intensitāte)
6000 kelvinu
Līdz 230% vairāk gaismas2)
Līdz 50% mazāk apžilbināšanas2)
— Līdz 5 reizēm ilgāks kalpošanas laiks 3)
— Līdz 55% mazāks enerģijas patēriņš 3)
— Videi draudzīgs
— Izturīgs pret vibrācijām
Kompakts dizains
Īpaša OSRAM garantija4)
Augstākā kvalitāte, kas izstrādāta un uzturēta sertificētā OSRAM ražošanas rūpnīcā (IATF16949) (TÜV un KBA) apstiprināta individuāla transportlīdzekļu testēšana.
Priekšrocības
Īpaši izstrādāta, lai aptvertu arvien vairāk transportlīdzekļu un lai nodrošinātu tos ar legālu1) LED modernizācijas risinājumu. Uzlabots optiskais dizains, pateicoties mazākai gaismas izstarošanas platībai, un tajā pašā lielāka gaismas intensitāte un labāka elektronikas darbība
Labāka redzamība un labāk pamanāms, lai nodrošinātu lielāku drošību uz ceļa, jo īpaši naktī
Vēsas baltās gaismas diodes uzlabojums ar tuvu krāsu temperatūru dienas gaismai
— Videi draudzīgs un izmaksu ziņā efektīvs, jo ilgmūžīgāks, tādējādi samazinot autoservisa apmeklējumu skaitu un enerģijas patēriņu 3)
— Jaunākā LED tehnoloģija ar aizsardzību pret viltojumiem, pateicoties OSRAM Trust programmai
Inovatīvas tehnoloģijas un izcila kvalitāte
12V
Tālās gaismas
Tuvās gaismas











•



Ielu legālas
Premium OSRAM kvalitāte
Gaismas plūsma
Elektromagnētiskie traucējumi (EMC)
Elektroniska
Kvalitāte
Aizsardzība pret putekļiem/mitrumu
Optikas patents
Nepārtraukti paplašinās transportlīdzekļu skaits un pieaugošais valstu skaits
Izstrādāts un apkalpots sertificētā OSRAM ražotnē (IATF16949)
1550lm (vienmērīgā stāvoklī)
Atbilstoši R10 CISPR 25 3. klase FM diapazonā @ 12V
Iekļauta polaritāte Novērš aukstās lampas testa kļūmes ziņojumu
Izstrādājums atbilst IATF16949 prasībām.
IP53 – ar uzlabotu ūdens aizsardzību izolāciju
Inovācijas, lai atbilstu ECE R112/ECE 113 prasībām konkrētos priekšējos lukturos
Aksesuāri Pieejams pilns OSRAM klāsts
Vibrācija Īpaši izstrādāts pret vibrāciju izturīgs dizains


1) Apstiprināts LED gaismas avots – attiecas tikai uz attiecīgajām valstīm, kurās ir
apstiprinājums vai uz kurām attiecas līdzvērtīgs apstiprinājums, un uz transportlīdzekļu modeļiem un gaismas funkcijām, kas pašlaik ir uzskaitīti savietojamības sarakstā. Sīkāku informāciju skatīt www.osram.com/nb-led. 2) Salīdzinājumā ar ECE R112 minimālajām prasībām, bet apžilbinājums ir mazāks par maksimāli pieļaujamajām vērtībām līdz pat 50%. 3) Salīdzinājumā ar tradicionālajām halogēna spuldzēm 4) Precīzus nosacījumus skatīt: www.osram.com/am-guarantee. Produkta detalizēta informācija 13.90 40 Product Name Order Number Purchase Order Description EAN10 ECE/ Category Base W V Kelvin Light Color lm Packaging Type Packaging Content EAN 10 [pcs.] Product Dimensions (Diameter x Length) [mm] Packaging Dimensions EAN10 (Height x Length x Width) [mm] Product Weight EAN10 (Gross incl. Packaging) [g] Approval Number Guarantee [years] NIGHT BREAKER ® LED GEN 2 H7RECOM 64210DWNBG2-2HFB 4062172369244 H7-LED PX26D 16 12 6000 white 1500 Hanging Folding Box (2HFB) 2 13.90 x 77.90 62 x 140 x 130 210 K 1821 | TP LED 22017 4 | 4+1 NIGHT BREAKER ® LED GEN 2 H7TRADE 64210DWNBG2 4062172369268 H7-LED PX26D 16 12 6000 white 1500 Folding Box (2FB) 2 13.90 x 77.90 60 x 127 x 132 204 K 1821 | TP LED 22017 4 | 4+1 NIGHT BREAKER® LED GEN 2 H7 – 12V | 16 W
Tehniskā informācija Pielietošanas jomas
AUDI Q5, 1. PAAUDZE (2008−2017)
EKSPLUATĀCIJAS
Kāpēc daži īpašnieki
“Audi Q5” sauc par diezgan
uzticamu automašīnu pēc mūsdienu mērauklām, taču citi –par kaprīzu un dārgi
NIANSES

uzturamu? Tāpat kā daudzu VW modeļu gadījumā, daudz kas ir atkarīgs no sākotnējās komplektācijas, stāvokļa un korekti veiktas apkopes.
Automašīnas virsbūve gandrīz pilnībā izgatavota no tērauda, tikai motora pārsegs un aizmugurējās durvis ir izgatavotas no alumīnija. Sportiskajai versijai SQ5 ir alumīnija priekšējie spārni. Zināma problēma automašīnām uz MLB platformas – priekšējo lukturu aizsvīšana. Aizmugurējā optika ir daudz hermētiskāka. Fotoattēlā – versija pirms restailinga.
Benzīna dzinēji
“Audi Q5” būvēta uz MLB platformas – kā, piemēram, A4 (B8) un A6 (C7) modeļiem, un tiem ir daudz kopīgu elementu, tostarp aprīkojumā. Interesanti, ka A4 un Q5 riteņu bāze ir gandrīz vienāda: atšķirība ir tikai 1 milimetrs. Dzinējs atrodas garenvirzienā un riteņus iedarbina caur sadales kārbu ar “Torsen” tipa pašbloķējošu starptiltu diferenciāli. Moments tiek sadalīts nesimetriski attiecībā 60:40 ar prioritāti uz aizmugurējo asi.
Pirms 2013. gada restailinga uzstādītie 2,0 litru benzīna motori (EA888 Gen2, 180–230 ZS) zināmi ar augstu eļļas patēriņu, tā iemesls – uz iekoksēšanos tendēti virzuļu gredzeni. GSM ķēde nav visai izturīga, bet problēmas ar tās spriegotājiem var rasties pie 80–100 tūkst. km nobraukuma. Diezgan ātri aizsērē kartera ventilācijas sistēmas vārsts, tādēļ dzinējs var sākt izspiest eļļu caur turbīnu vai kloķvārpstas aizmugurējo blīvslēgu. Vēl viena raksturīga problēma ir sūkņa sūces korpusa plaisu dēļ. Sūkni parasti maina uz uzlabotu (ar burtu P detaļas kodā) vai neoriģinālu analogu ar metāla korpusu.
Dzinējos EA888 Gen3, kas parādījās pēc restailinga, GSM un kartera ventilācijas problēmas tika atrisinātas, tomēr eļļas darba spiediena samazināšana un masveidīga zemas viskozitātes eļļu izmantošana palielināja iespējamību,
ka sadales vārpstu ieliktņiem radīsies skrambas. Modeļu gammā ir arī hibrīdi, kas tika komplektēti ar tiem pašiem 2,0 litru dzinējiem, bet mūsu tirgū šādi modeļi sastopami reti.
Kas attiecas uz 6 cilindru dzinējiem, pirms restailinga Q5 tika uzstādīts EA837 sērijas atmosfēras 3,2 FSI (270 ZS), kura cilindru čaulu alusila pārklājumam mēdz rasties skrambas agri drūpošu katalizatoru un eļļas plēves izskalošanas ar benzīnu aukstas palaišanas gadījumā dēļ. Ķēžu mehānisms nav vienkāršs: četras ķēdes un fāžu regulatori atrodas spararata pusē. Ķēžu klaudzēšana un pārlēkšana sastopama jau ar 100–120 tūkst. km nobraukumu. Nobraukumam sasniedzot 180–200 tūkst. km, ļoti ieteicams ķēdes nomainīt. Lai veiktu šo procedūru, nākas noņemt pārnesumkārbu, bet labāk ir noņemt dzinēju, jo tobrīd tam tāpat labākajā gadījumā nepieciešams nomainīt daudzus blīvējumus, bet sliktākajā – nopietns remonts.
Noderīga informācija 50
3,0 TFSI (arī EA837 sērija, 272–354 ZS), kas parādījās pēc restailinga, aprīkots nevis ar turbokompresoru, bet ar mehānisku piedziņas kompresoru. Kompresoram, kas atrodas cilindru bloka sāngāzumā, ir divi starpdzesētāji, taču temperatūras režīmu joprojām nevar saukt par saudzējošu: mezgls reti nokalpo vairāk par 120–150 tūkst. km. Termostata resurss – 50–70 tūkst. km. Daži īpašnieki maina termostatu uz citu, ar tā saukto auksto (zemākas temperatūras) programmaparatūru, un ne velti: ar standarta termostatu pārkaršanas risks ir diezgan augsts. Izplatīta parādība ir arī eļļas apetīte un skrambas cilindros. Forumos par šo dzinēju kopumā saka apmēram tā: “Lielisks potenciāls tūninga ziņā, resursa ziņā – ne visai.”
Dīzeļdzinēji
“Audi Q5” tika komplektēts ar 2,0 litru dīzeļdzinējiem EA189 un EA288 (143–190 ZS), kā arī 3,0 litru agregātiem EA896 un EA896 Gen2 (240–340 ZS). Pēc konstrukcijas arī dīzeļdzinēji nav vienkārši, taču benzīna motoru fonā tie izskatās daudz drošāki. Ar normālu ekspluatāciju un apkopi visu dīzeļdzinēju resurss var sasniegt 350–400 tūkst. km un vairāk. Agrīnās 2,0 TDI versijās bija pjezo sprauslas: mazāk drošas nekā elektromagnētiskās, taču vismaz 150 tūkst. km tās spēj sasniegt.
Zināma 2,0 litru dzinēju EA189 vājā vieta ir sešstūra eļļas sūkņa piedziņas vārpsta, kas iebūvēta balansieru modulī. Tā resurss parasti ir apmēram 200–250 tūkst. km, bet nodiluma sekas izmaksā dārgi. Eļļošanas režīma pasliktināšanās dēļ vispirms cieš turbīna, pēc tam cilindru un virzuļu grupa. Lai izvairītos no problēmām, šo vārpstu ieteicams mainīt katru reizi, kad tiek mainīts GSM. EA288 dzinēju priekšrocības – ātrāka uzsilšana un vienmērīgāka motora darbība. Šie dzinēji ir ievērojami sarežģītāki CBG lējuma ziņā, tiem ir arī sarežģītāks atslēdzams ūdens sūknis un termostats, un tāpēc rūpīgāk jāuzmana antifrīza kvalitāte. Tajā pašā laikā mehāniskās daļas ziņā nopietnu atšķirību no EA189 gandrīz nav.
3,0 V6 dzinējam GSM ķēde teorētiski spēj nokalpot līdz 300 tūkst. km, tomēr tās augšējie spriegotāji parasti padodas jau pie divreiz mazāka nobraukuma. Ja jau nācies izjaukt GSM piedziņu,

Salons sākotnējo izskatu praktiski nezaudē līdz 150–200 tūkst. km, sēdekļi turas līdz 250–300 tūkst. km pat minimālas apkopes gadījumā. Automašīnās pirms restailinga dažreiz atsaka multivides sistēmas ekrāna apgaismojums, taču lampas ir viegli nomainīt. Klimata sistēma ir diezgan uzticama: neaizmirstot par regulāru apkopi un uzpildīšanu, kompresors spēj nokalpot 300–350 tūkst. km. Salona ventilators bieži sāk gaudot pie 80–100 tūkst. km nobraukuma. Slēdzeņu un logu drošums ir pieņemams, taču durvju rokturi ar bezatslēgas piekļuvi nekalpo ilgi: iekšpusē iekļūstošais mitrums sabojā to elektronisko pildījumu. Elektrības sistēma ir samērā stabila, arī elektronikas kļūmes daudz nekaitina, tomēr, ņemot vērā elektronisko bloku skaitu automašīnā, ik pa laikam ar šo daļu tomēr ir kaut kas jādara.
tad daži īpašnieki izvēlas uzlikt arī jaunu ķēdi. Augšējā alumīnija paliktņa stiprinājuma skrūves laika gaitā izstiepjas, un detaļu savienojuma vieta zaudē hermētiskumu. Rezultātā pēc 80–120 tūkst. km ātrumkārbas pusē var tikt novērota eļļas noplūde. Defekta novēršanai nākas noņemt dzinēju.

Transmisija
Q5 ir diezgan plaša pārnesumkārbu izvēle: tās ir 6 pakāpju MPK, DL501 0B5 sērijas 7 pakāpju DSG, kā arī divi hidromehāniskie “automāti”: 6 pakāpju ZF 6HP19 (0B6) un 8 pakāpju ZF 0BK. Mehāniskā kārba ir visai droša. 6 pakāpju ātrumkārba ZF sastopama diezgan reti: ar to galvenokārt komplektēja automašīnas ar benzīna V6 3,2 FSI. Ātrumkārba nav pati veiksmīgākā gan “dzelzs”, gan programmatūras ziņā, lai gan saudzējošā braukšanas režīmā un ar regulārām eļļas maiņām spēj nokalpot vismaz 200–250 tūkst. km bez nopietnas iejaukšanās. Šos ieteikumus neievērojot, remonts var būt nepieciešams, ja nobraukums ir mazāks par 100 tūkst. km.
8 pakāpju “automāts” konstruktīvi ir sarežģītāks, tam nepatīk skarbi braukšanas režīmi, bet normālas ekspluatācijas gadījumā agregāts spēj iepriecināt ar resursu to pašu 250 tūkst. km
Noderīga informācija 51
apmērā vai pat vairāk. Pamatoti ir arī tas, ka apkopes ignorēšana ātri izraisa virkni problēmu, kuru novēršana izmaksā dārgāk nekā 6 pakāpju automātiskas ātrumkārbas gadījumā.
Robotizētā kārba ir kaprīzāka un dārgāka ekspluatācijā, taču viss nav tik traki: 200–250 tūkst. km resurss arī ir visai sasniedzams. Ja MPPK un “automātos” eļļu vēlams mainīt ne retāk kā ik pēc 50–60 tūkst. km, tad saistībā ar DSG šo intervālu labāk divreiz samazināt –tas palīdzēs izvairīties no daudzām problēmām. Viens no galvenajiem šo problēmu cēloņiem ir neveiksmīga eļļošanas sistēma ar ežekcijas sūkni un zemu eļļas filtrācijas pakāpi, kā rezultātā rodas hidrauliskās daļas traucējumi. Parādoties pirmajiem kārbas nepareizas darbības simptomiem, ieteicams nomainīt ne tikai eļļu, bet arī solenoīdus.
Pilnpiedziņas sistēma ir diezgan stipra. Atkal banāli, taču fakts: galvenais ir regulāri (ik pēc 50–60 tūkst. km) mainīt eļļu visos reduktoros, neaizmirstot ne “Torsen”, ne priekšējo diferenciāli. Jaudīgajām versijām dažkārt ne pārāk ilgi kalpo aizmugurējais reduktors un kardāns, bet lielākajai daļai automašīnu tas nav aktuāli līdz 300–350 tūkst. km. Ja uzmana putekļaizsargus, tad pusass šarnīru resurss parasti sasniedz 200–250 tūkstošus km.
Ritošā daļa
Priekšējā un aizmugurējā balstiekārta ir daudzsviru, kopumā tā ir diezgan stipra. Priekšējās piekares alumīnija sviru kalpošanas laiks ir pieņemams, taču galvenā problēma ir sviru stiprinājuma savilcējskrūves oksidēšanās grozāmasī. Aizmugurējai piekarei reti nepieciešama iejaukšanās agrāk par 100 tūkst. km. Stūres stienis atrodas apakšrāmī, bet stūres pastiprinātājs var būt hidraulisks vai elektrisks. Abām konstrukcijām problēmas galvenokārt rodas putekļaizsargu hermētiskuma traucējumu dēļ.
Bremzes Q5 ir labas: jau bāzē uzstādīti 30 mm biezi priekšējie diski ar 320 mm diametru – tas ar uzviju ir pietiekami gandrīz visām versijām. Jaudīgākajām modifikācijām var būt 345 milimetru diski. Uz aizmugures ass diski ir mazāki – 300 mm. Daži

Aizmugurējo durvju elektropiedziņas ir stipras, bet elektromotoru stiprinājuma skrūves pašas atskrūvējas un pazūd kaut kur apšuvumos. Laiku pa laikam niķojas slēdzenes gala devēji, tāpēc bieži vien durvju aizvērēju funkcija vairs nedarbojas. Standarta problēmu ar benzīntvertnes vāciņa bloķēšanu var atrisināt, nomainot piedziņu. Iepildes atvere ir vienreiz lietojama detaļa, tā tiek sabojāta ikreiz, kad tiek noņemta piedziņa.
īpašnieki mēģina uzstādīt lielākus nestandarta diskus, taču šāda procedūra ne vienmēr ļauj samazināt bremzēšanas ceļu: nenomainot vakuuma pastiprinātāju un galveno bremžu cilindru, ne katrs autovadītājs varēs bremzēt pārliecinoši.
Situācija kopumā? Q5 ir tipisks “Audi” uz MLB platformas: komfortabls, bagātīgi aprīkots, savā ziņā diezgan uzticams, bet citā ziņā arī kaprīzs un uzmanību prasošs. Taču gandrīz to pašu var teikt par klasesbiedriem no “Mercedes-Benz” vai BMW. Pozitīvi ir tas, ka visa VW grupas agregātu bāze ir sen un kārtīgi izpētīta, un tas nozīmē, ka ir risinājumi gandrīz visām problēmām, kas rodas. Protams, ka tehnoloģiski pārlieku sarežģītai “Premium” klases automašīnai ir nepieciešama regulāra un kvalificēta apkope, kas nozīmē noteiktas izmaksas, un, ja īpašnieks ir tam gatavs – tad viss ir kārtībā.

Virsbūve turas sliktāk, nekā daudzi cer sagaidīt no šīs markas un šo izlaiduma gadu automašīnas. Lakas un krāsas pārklājuma slānis ir diezgan plāns, un tāpēc viegli izveidojas robi. Protams, cinkojums glābj, taču labāk tā izturību nepārbaudīt un robus piekrāsot pēc iespējas ātrāk. Apskatot automašīnu, noderīgi būs rūpīgi pārbaudīt, vai nav rūsas – īpaši sliekšņus, jumta priekšējo malu un aizmugurējo durvju iekšējās malas. Visvairāk problēmu sagādā arkas, galvenokārt aizmugurējās, kur dažkārt sastopama caurejoša korozija. Viscaur sarūsējušās arkas bieži izraisa hermētiskuma samazināšanos un korozijas bojājumus sliekšņiem no iekšpuses. Nopietni korozijas bojājumi, kas skar garensijas vai virsbūves spēka struktūras metinātās šuves, ir reti sastopami, galvenokārt – sistām un slikti atjaunotām automašīnām.

Noderīga informācija 52



 NIEMIECKA PRECYZJA ZNANA NA CAŁYM SWIECIE
NIEMIECKA PRECYZJA ZNANA NA CAŁYM SWIECIE
DĪVAINS KONDICIONĒTĀJA DEFEKTS PIEMĒRS
NO DZĪVES
Ir pāris vienkāršu ieteikumu: pirmais – doties veikt kondicionētāja profilaksi, kamēr vēl nav sācies karstais laiks, otrais – uz ziemu neatstāt sistēmu nehermetizētu. Šo ieteikumu neievērošana dažkārt rada pārsteigumus, kuru cēloņu meklēšana liek palauzīt galvu.

Situācija: kāda automobiļa īpašnieks vasaras sākumā pamanīja, ka kondicionētājs nedzesē. Cilvēks automašīnu nogādāja autoservisā, kur viņam paskaidroja, ka problēma ir noplūdē: maģistrāle saplīsusi, aukstuma aģents pazudis. Defekts ātri tika novērsts, sistēma uzpildīta, kondicionētājs sāka darboties. No sākuma, kamēr cilvēks brauca īsos attālumos, viss bija normāli. Tomēr, tiklīdz automašīnu sāka lietot ilgāku braucienu režīmā, sāka parādīties diezgan dīvains defekts.
Kas par lietu: kādu laiku kondicionētājs darbojās normāli, bet pēc tam pārstāja dzesēt: braucot pa pilsētu – pēc apmēram vienas stundas, trasē – pēc 40 minūtēm. Pēc 15–20 minūšu ilgas stāvēšanas viss normalizējās, taču pēc tam vēsture atkārtojās. Īpašnieks atkal devās uz servisu, kur viņam uzpildīja kondicionētāju. Pavirši apskatot automašīnu, cilvēkam pateica, ka apledo iztvaicētājs. Kā daļēju pagaidu līdzekli ieteica salona appūtei ieslēgt nevis ventilatora pirmo ātrumu, bet vismaz otro un papildus pagriezt temperatūras regulatoru no aukstākās pozīcijas mazliet

uz siltuma pusi – vienlaikus iztvaicētājs ātrāk tiek izpūsts ar siltāku gaisu un tik intensīvi neapledo.
Autoīpašnieks darīja tā, kā viņam ieteica, un patiešām: kondicionētāja darbības laiks palielinājās aptuveni divas reizes. Tomēr tādu agregāta darbību nevar saukt par normālu. Kāds ir defekta cēlonis, un kā to novērst? Kā cēlonis tika norādīta nekorekta termoregulējošā ventiļa (TRV) darbība. Tas ir mezgls, caur kura sprauslu izejot aukstuma aģents strauji atdziest, pārvēršoties gāzveida stāvoklī. Mezglu nolēma nomainīt. TRV parasti atrodas netālu no iztvaicētāja, un mehāniķis teica, ka šai automašīnai, lai nomainītu šo mezglu, nāksies noņemt priekšējo paneli. Tā nav vienkārša un lēta procedūra, tāpēc īpašnieks nolēma
Iztvaicētājs var apledot daudzu iemeslu dēļ: aukstuma aģenta trūkums, slikta siltuma noņemšana nestrādājoša ventilatora vai aizsērējuša salona filtra dēļ utt.
katram gadījumam pakonsultēties citā autoservisā. Interesanti, ka tur noteica pavisam citu diagnozi.
Pieslēdzis manometru, meistars konstatēja, ka TRV darbojas normāli, bet defekta cēlonis ir banāls: mitrums sistēmā. Kā tas tur nokļuva? Kā izrādījās, pagājušās vasaras beigās kondicionētājs bija pārstājis dzesēt. Karstais laiks jau it kā beidzies, īpašnieks nolēma, ka nav īpašas vajadzības pēc kondicionētāja, un remontu nolēma atlikt uz nākamo sezonu. Kā teikts iepriekš, kad īpašnieks atbrauca uz pirmo autoservisu, kondicionēšanas sistēmā tika konstatēta noplūde. Caur noplūdes vietu vispirms aizplūda aukstuma aģents, bet tad nehermētiskajā sistēmā caur to arī iekļuva mitrums visas aukstās sezonas laikā.
Noderīga informācija 54

Pirmajā autoservisā vienkārši aizlodēja saplīsušo cauruli un uzpildīja sistēmu. Taču mitrums jau sistēmā palika, jo sausinātājs, kas visu šo laiku to bija uzsūcis, netika nomainīts. Turpmāk viss ir likumsakarīgi: pēc kāda laika aukstuma aģentā esošā mitruma dēļ sasala droselējošā ierīce, iztvaicētājā kritās spiediens un tas sāka apledot. Pēc automašīnas stāvēšanas iztvaicētājs atkusa un kondicionētājs atkal darbojās.
Devēju problēmas
Līdzīgi simptomi – kad kondicionētājs pēc kāda laika vairs nedzesē – ir iespējami arī tāpēc, ka nekorekti sāk darboties iztvaicētāja temperatūras devējs. Kad iztvaicētāja temperatūra nokrītas līdz +2..+3 °C, šis pats devējs dod komandu izslēgt kondicionētāju – lai iztvaicētājs nesāktu apledot. Ja devējs ir zaudējis jutību, tad
Problēmas risinājums izrādījās daudz vienkāršāks nekā TRV nomaiņa ar priekšējā paneļa noņemšanu: sistēmas caurpūšana (dažreiz izpūš ar slāpekli), sausinātāja nomaiņa un uzpilde ar svaigu aukstuma aģentu. Citiem vārdiem sakot – lūk, kārtējais piemērs, kā sākotnēji nekorekti veikta apkope var radīt, kā minimums, atkārtotas problēmas un, kā maksimums – nevajadzīga, bet dārga remonta nepieciešamību.

Ideālā gadījumā sausinātājs būtu jāmaina vismaz
ik pēc 70 tūkst. km (precīzs intervāls parasti ir norādīts tehniskajā dokumentācijā). Filtra iekšpusē ir silikagels, kas uzsūc mitrumu – tieši pateicoties tam, arī notiek nosusināšana. Aprakstītajā gadījumā, kad automašīna diezgan ilgi bija braukusi ar nehermetizētu sistēmu, sausinātāja nomaiņa ir obligāta, jo silikagels ar mitrumu no apkārtējā gaisa līdz kritiskai robežai tiek piesūcināts ļoti ātri. Prakse rāda, ka diemžēl par sausinātāju bieži vien vispār aizmirst, kas kļūst par dārgi maksājošu problēmu cēloni. Piemēram, pēc kompresora sabojāšanās sausinātājs ir obligāti jānomaina, jo tajā uzkrājušās vecā kompresora nodiluma skaidas spēj ļoti ātri sabojāt jauno kompresoru.


temperatūra turpina kristies – līdz mīnus grādiem, un iztvaicētājs, protams, apledo. Ar devējiem gadās
arī kuriozākas problēmas. Piemēram, sāk niķoties buferī esošais ārējā gaisa temperatūras mērīšanas devējs. Ārā karstums, bet devējam šķiet, ka temperatūra ir nulle vai mīnus grādi, un tātad kondicionētājs neieslēgsies, neskatoties uz to, ka visi tā mezgli ir kārtībā.
Noderīga informācija 55
DIVI AKUMULATORI AUTOMAŠĪNĀ
Kā zināms, dažiem automašīnu modeļiem ir nevis viens akumulators, bet divi. Kādas mēdz būt pieslēguma shēmas, un kādas nianses ir lietderīgi atcerēties, ekspluatējot šādus automobiļus?



Vieglajos automobiļos galvenokārt tiek izmantotas divas divu akumulatoru pieslēgšanas shēmas. Pirmā shēma ir paralēlā, visbiežāk tā tiek izmantota apvidus automobiļos vai pikapos. Kā norāda nosaukums, tā sastāv no diviem vienādiem akumulatoriem, kas savienoti vai nu vienkārši paralēli, vai arī caur akumulatoru atsaistes ierīci. Dažās automašīnās var sastapt arī secīgi savienotus akumulatorus (sk. iespraudumu), taču tā nav tipiska parādība. Otrajā shēmā paredzētas divas baterijas, no kurām


“Mitsubishi L200”: divi akumulatori pieslēgti paralēlā shēmā.
viena ir galvenā, bet otra – papildu. Šāds variants sastopams galvenokārt augšējā cenu segmenta automašīnās, piemēram – dažos “Mercedes-Benz”, BMW, “Jaguar” utt. modeļos.
Paralēlā shēma
Šo pieslēgšanas variantu var sastapt tādās automašīnās kā “Toyota Land Cruiser”, “Mitsubishi Pajero”, “Pajero
Noderīga informācija 56
Sport”, pikapā L200 un citās. Abi akumulatori dažreiz ir uzstādīti zem pārsega, dažreiz viens var būt zem pārsega, bet otrs – kaut kur salonā, piemēram – zem vadītāja sēdekļa. Divu bateriju uzstādīšanas mērķis ir vienkāršs: kopējās kapacitātes palielināšana, piemēram – divi paralēli pieslēgti 75 Ah akumulatori kopumā nodrošina 150 Ah. Dzinēja palaišanai vispār jau pietiek ar vienu bateriju, ja vien tā ir darbderīga. Kāpēc vajadzīga divkāršota kapacitāte? Apvidus automobilis dažreiz nonāk apstākļos, kad nākas izmantot vinču, prožektoru lukturus uz jumta (ja tādi ir) utt. Kad sāka izmantot šādu shēmu, tika praktizēts parastais paralēlais pieslēgums. Tomēr trūkums ir acīmredzams: ja, piemēram, no rīta nav izdevies iedarbināt motoru, tad vienlaikus būs izlādējušās abas baterijas, divu akumulatoru priekšrocībai zaudējot jebkādu nozīmi. No tā izriet, ka kaut kādā veidā jāliek baterijām darboties pārī, bet vienlaikus katrai no tām jāsaglabā zināma autonomija. Šim nolūkam sāka izmantot akumulatoru atsaistes ierīces, kuru uzdevums ir saplānot AKB darbību tā, lai tās vienlaikus uzlādētu, bet izslēgtu vienlaicīgas izlādes iespēju.
Vienkāršāk sakot, dzinēja iedarbināšanai vienlaikus tiek izmantots tikai viens akumulators, lai neizlādētu abus uzreiz. Otrs akumulators var pieslēgties, ja nepietiek ar pirmā kapacitāti. Kad dzinējs darbojas, abas baterijas uzlādējas, tomēr, ja viens akumulators ir pilnībā uzlādēts (kā reālajā dzīvē gandrīz nekad nemēdz būt), tas tiks atvienots un visa uzlādes strāva nonāks otrajā akumulatorā. Proti – ierīce kontrolē vismaz spriegumu katras baterijas spailēs, šos datus uztverot kā vadošos signālus savas darbības algoritmam. Pirmās akumulatoru atsaistes ierīces bija diezgan vienkāršas: tā varēja būt divu diožu shēma vai releja shēma. Tamlīdzīgas mūsdienu ierīces ir sarežģītākas un parasti neiztiek bez mikroshēmām.
Papildu akumulators
Otrā shēma – ar galveno un papildu bateriju – nozīmē neviennozīmīgu akumulatoru uzstādīšanu. Viens no pirmajiem masveida automobiļiem ar papildu akumulatoru bija
“Mercedes-Benz
E-class W211” – viens no pirmajiem masveida automobiļiem, kas tika komplektēts ar papildu akumulatoru.



pirmsrestailinga “Mercedes-Benz E-class W211”, kur otrs akumulators bija nepieciešams, lai nodrošinātu nepārtrauktu bremžu darbību. Lieta tāda, ka automobilis tika komplektēts ar SBC elektrohidraulisko bremžu sistēmu, kur parastā režīmā nav tieša savienojuma starp bremžu pedāli un bremžu sistēmu. SBC sistēmai ir elektriskais sūknis, kas sūknē bremžu šķidrumu. Tas nozīmē, ka pēkšņa sprieguma pazušanas gadījumā automašīna paliek bez bremzēm.
Lai izvairītos no šādām situācijām, automašīnai bez galvenā akumulatora (60–95 Ah dažādās W211 versijās) ir vēl arī neliela papildu baterija (12 Ah), kas izvietota zem pārsega. Interesanti, ka galveno akumulatoru konstruktori izvietoja bagāžniekā. Mēģinājums uzstādīt papildu akumulatoru šajā formātā nebija pārāk veiksmīgs: pēc W211 restailinga no SBC sistēmas atteicās, un rezerves akumulators vairs nebija vajadzīgs. Tomēr citos “Daimler-Benz” modeļos (galvenokārt augšējā cenu segmentā – piemēram, “Maybach”) arī tika izmantota SBC sistēma, turklāt šādos automobiļos sāka parādīties arvien vairāk elektronikas, kurai strāvas atslēgšana ir ļoti nevēlama.
Taču kopumā papildu akumulatoru izplatīšanos veicināja “Start-Stop”
sistēmu izmantošana. Runa nav tikai par to, ka, apstādinot dzinēju pie luksofora, ir jāpieslēdz klimata sistēma, multivide utt. – to var atrisināt, izmantojot ietilpīgāku galveno akumulatoru. “Start-Stop” bija jāapvieno, piemēram, ar tādām sistēmām kā “Auto Hold” – automašīnas noturēšana uz vietas pēc apstāšanās. Pastāv dažādi “Auto Hold” konstruktīvie varianti: tas var būt elektromehāniskās stāvbremzes funkcijas paplašinājums vai arī sistēma uztur spiedienu galvenajā bremžu sistēmā pēc tam, kad vadītājs ir noņēmis kāju no bremžu pedāļa. Jebkurā gadījumā drošības apsvērumu nolūkā sistēmai nevajadzētu palikt bez strāvas.
Ekspluatācija un nomaiņa
Paralēlās shēmas akumulatoriem parasti ir aptuveni vienāds kalpošanas laiks, tādēļ tie jāmaina abi uzreiz. Daži autoīpašnieki izskata kompromisa variantu: nomainīt tikai vienu bateriju. Šādu risinājumu diezin vai var saukt par optimālu: tik tikko dzīvs, uzlādi gandrīz neuzņemošs otrs akumulators stipri samazinās jaunās baterijas resursu. Kāds iet vēl tālāk un nolemj pavisam noņemt otru akumulatoru, tomēr arī tas nav visai labi, jo borta elektrotīkls ir paredzēts ne tikai bateriju pāra kapacitātei, bet arī noteiktai pretestībai ķēdē.
informācija 57
Noderīga
Citiem vārdiem sakot, labāk tomēr nomainīt abus akumulatorus, taču jāuzstāda divi vienādi, jo dažādas kapacitātes baterijas pārī nespēs normāli uzlādēties.
Kā zināms, lai pagarinātu akumulatoru resursu, tos ieteicams laiku pa laikam uzlādēt no ārēja avota. Automašīnu ar galveno un papildu akumulatoru īpašnieki auto forumos dažreiz jautā: vai papildu baterija jāuzlādē tādā pašā veidā? Teiksim tā: šī procedūra nebūs lieka, lai gan diezin vai izdosies ievērojami pagarināt mazas baterijas resursu: mazās kapacitātes dēļ līdz ar vecumu tā strauji degradē. Viens no rādītājiem, ka ir pienācis laiks nomainīt papildu akumulatoru, var būt “Start-Stop” sistēmas atteice. Protams, pirms akumulatora nomaiņas jāpārliecinās, ka sistēma pārtraukusi darboties tieši šī iemesla dēļ.
Kāds ir papildu akumulatora resurss? Dažos avotos teikts, ka tas spēj noturēties 4–6 gadus – tāpat kā galvenais, un to mainīt vēlams kopā. Iespējams, ka kāds pajautās: kā var būt runa par tik ilgu kalpošanas laiku, ja mūsdienās baterijas ir kļuvušas vienreiz lietojamas un nekalpo ilgāk par 1–2 gadiem? Patiesi, dažreiz tiešām gadās, ka jauns akumulators sabojājas aizdomīgi ātri, tomēr daudzos gadījumos runa nav par akumulatoru, bet gan par ekspluatācijas režīmu. Ja bateriju regulāri un pareizi uzlādē un netiek pieļauta dziļa izlāde, tad kalpošanas laiks spēj pārsteigt šī vārda labā nozīmē.



Savulaik populārajiem “Toyota Land Cruiser 80” zem pārsega arī bija divi akumulatori, bet tie bija pieslēgti secīgā shēmā – proti, izejā sanāca 24 volti. Kāpēc tas vajadzīgs automašīnai ar 12 voltu borta tīklu? Lieta tāda, ka šis apvidus automobilis tika aprīkots ar tilpuma ziņā diezgan lieliem dīzeļdzinējiem, kuru iedarbināšanai nepieciešams jaudīgs starteris. Šāds starteris sanāca vai nu pārāk dārgs, vai ļoti liels – tā laika tehnoloģijas neļāva to izgatavot kompaktu un lētu. “Toyota” inženieri to atri sināja vienkārši, uzstādot 24 voltu starteri: tam nepieciešams divas reizes mazāk strāvas, un tātad arī tinumi būs gandrīz divreiz mazāki. Turklāt šādā starterī ilgāk nokalpos sukas, kas ātrāk sabojājas no pārāk lielas strāvas, nevis sprieguma. Atšķirībā no paralēlā pieslēguma secīgi pieslēgtie akumulatori ir prasīgāki pret savu stāvokli, jo šajā gadījumā nav rezerves, bet nepieciešams iegūt 24 voltus.


Secīgā shēma
+ –Noderīga informācija 58
“Toyota Land Cruiser 80”: divi secīgā shēmā pieslēgti akumulatori.
Mums ir vienkārša formula Jūsu biznesam.
Vairāk jaudas.
Novatoriskais AGM akumulators nosaka jaunus standartus nepārspējamai Start-Stop veiktspējai.


exidegroup.com Inovācijas Ilgtspējība Uzticamība Augsta veiktspēja Radot nākotni - Exide stilā!
Ekskluzīvi Jums!

Par pirmo automašīnu novietošanas asistentu tiek uzskatīts ASV 1950. gados izgudrotais “Curbfeeler”: būtībā metāla stieple, kas rada raksturīgu skaņu, saskaroties ar apmali.
PALĪGSISTĒMAS AUTOMAŠĪNAS NOVIETOŠANAI UZBŪVE UN VĒSTURES FAKTI –INFORMĀCIJA NO VALEO
Tā gadās, ka daži tirdzniecības nosaukumi kļūst par sugasvārdiem: kopēšanas ierīces sauc par kseroksiem, apvidus automašīnas par džipiem, savukārt auto novietošanas palīgsistēmas par parktroniķiem. Nosaukuma “Parktronic” etimoloģija ir vienkārša: tas cēlies no vārdu parking + electronic apvienojuma. Šo nosaukumu ikdienas lietošanā ieviesa uzņēmums “Daimler-Benz” 1990. gados. Interesanti, ka pirmās automašīnas novietošanas palīgsistēmas parādījās aptuveni pirms 70 gadiem, kad elektronikas mūsdienu izpratnē vēl nebija.
Viens no pirmajiem parkošanās asistentiem sastāvēja no maziem stiepļu vai atsperu gabaliņiem, ko piestiprināja pie automašīnas priekšējā un aizmugurējā bufera. Šādas ierīces dēvēja par “Curbfeeler”, kur “curb” – apmale, bet “feel” – just. Saskaroties ar apmali, karbfilers radīja metālisku skaņu, brīdinot vadītāju par šķērsli. Karbfileru izdomāja Amerikā 1950. gados: tad modē bija lielas automašīnas ar hromētiem buferiem
un riteņu dekoratīvajiem diskiem, kā arī vaitvoliem – baltām svītrām uz riepām. Lielo automašīnu novietošana stāvvietā nebija vienkārša, un saskare ar apmali varēja sabojāt ārējo izskatu.
60 Noderīga informācija



Tiek uzskatīts, ka parkošanās asistenti vispirms parādījās “Premium” klases automašīnām, tomēr gluži tā tas nav. Viens no pirmajiem automobiļiem, kuram jau 1982. gadā kā opcija tika piedāvāts parkošanās asistents ar ultraskaņas devējiem, bija 7. paaudzes “Toyota Corona”. Parkošanās sistēma tika saukta par “Back Sonar”. Fotoattēlā –japāņu reklāmas buklets, kurā aprakstīta šī opcija.
Attīstoties elektronikai, parādījās pilnveidotas sistēmas, kas aprīkotas ar ultraskaņas devējiem. Pirmā samērā plaši izplatīta līdzīga sistēma debitēja 1978. gadā. Šis parkošanās asistents darbojas pēc eholotes principa: devējs sūta ultraskaņas impulsu, kas tiek atstarots no šķēršļiem un atkal tiek fiksēts ierīcē. Sistēma mēra laiku starp impulsa izveidošanu un fiksāciju un aprēķina attālumu līdz objektam. Dati tiek pārraidīti uz indikācijas ierīci – skaņas vai grafisko. Sistēmas ar ultraskaņas devējiem tiek izmantotas joprojām.
1990. gadu sākumā “Audi” inženieri nodemonstrēja parkošanās asistentu ar elektromagnētiskiem devējiem. Šādas ierīces uzstādīšanai buferī

Interesants automašīnu novietošanas asistents tika piedāvāts “MercedesBenz S-Class W140”: izbīdāmas antenas, kas pacēlās, ieslēdzot atpakaļgaitas pārnesumus. Plaši izplatīti ir maldi, ka tie ir sava veida parktronika devēji, taču tā tas nav. Šo antenu uzdevums ir vizuāli parādīt automašīnas izmērus, jo bagāžnieka mala spoguļos nav redzama. Šādas antenas tika uzstādītas līdz 1995. gadam, bet vēlāk parādījās “Parktronic” sistēma.
caurumi nav vajadzīgi: devējs ir lente, kas pielīmējama vai citādi piestiprināma bufera iekšpusē. Viena no tamlīdzīgas sistēmas priekšrocībām ir tāda, ka devējs ir labi pasargāts no netīrumiem: tas nozīmē, ka sistēmas darbspējas ir mazāk atkarīgas no laikapstākļiem. Šādas sistēmas parasti labāk pamana šķēršļus, jo devējs atrodas visā bufera platumā, proti – parkošanās asistentam praktiski nav aklo zonu. Ir arī trūkumi: elektromagnētisko devēju darbības tālums parasti ir mazāks nekā ultraskaņas devējiem.
Attīstoties tehnoloģijām un parādoties elektroniskajiem vadītāja palīgiem, bija nepieciešami jauni devēji, jo tagad sistēmai ir jāuzrauga ne tikai šķēršļi nelielā attālumā, bet arī jāskenē pretimbraucošo automašīnu plūsma. Šim nolūkam tiek izmantoti lāzera tālmēri un lidari, kuru pamatā ir optiskās tehnoloģijas. Taču parko šanās asistentos joprojām izmanto ierastos ultraskaņas un elektromagnētiskos devējus, un kombinācijā ar videokamerām tie nodrošina īpaši labu efektu.


Elektromagnētiskā parkošanās asistenta lente-devējs.
Parkošanās asistenta ultraskaņas devējs.
Noderīga informācija 61

“Valeo” parkošanās asistentu komplektos iekļauts viss nepieciešamais uzstādīšanai, tostarp devēju montāžas gredzeni dažādām bufera formām (0°, 4°, 10°). Devēji izstrādāti, lai uzlabotu ūdens pilienu novadīšanu, tāpēc parkošanās asistenti efektīvi darbojas pat stiprā lietū. Fotoattēlā – “Valeo beep&park/vision” komplekts ar devējiem un atpakaļskata kameru.
Patlaban uz ceļiem joprojām ir daudz automobiļu, kuriem nav standarta parkošanās asistenta – šīm automašīnām “Valeo” piedāvā “beep&park” un “beep&park/vision”. Pirmais variants ir sistēma ar skaņas paziņojumu vai šķidro kristālu displeju, otrais variants –ar atpakaļskata kameru. Abas sistēmas ir pieejamas dažādās modifikācijās: piemēram, “beep&park” komplektam var būt četri līdz astoņi devēji, bet “beep&park/vision” var būt tikai kamera vai kamera kopā ar devējiem.
Interesanta “Valeo” parkošanās asistentu īpatnība ir tā, ka tie brīdina arī citus autovadītājus par bīstamu tuvošanos novietotam transportlīdzeklim,
kas aprīkots ar “beep&park” vai “beep&park/vision”. Vienkāršāk sakot, automašīna ar parkošanās asistentu var dot skaņas vai gaismas signālus, piesaistot citu vadītāju uzmanību. Parkošanās asistenti ir savietojami ar atpakaļgaitas ieslēgšanas impulsa signālu, tos arī var izmantot automašīnās, kur atpakaļgaitas lukturim nav līdzstrāvas avota, bet ir modulāra sprieguma avots. Visas “beep&park” līnijas ierīces ir savietojamas ar vilkšanas sistēmām. Produkcijai ir “E-mark”, CE un “Rohs” sertifikāti.
Plašāka informācija par automašīnu novietošanas palīgsistēmām un citu “Valeo” produkciju pieejama resursā valeoservice.com.
Saistītā produkcija
Vēl viens “Valeo” risinājums, kas palīdz kontrolēt telpu ap automašīnu, ir aklo zonu noteikšanas sistēma “safe side”. Sistēma balstīta uz diviem radaru devējiem (79 GHz), kas nozīmē pārliecinošu darbību gan diennakts gaišajā, gan tumšajā laikā. Darbības rādiuss līdz 5 metriem, iespējami vizuāli un skaņas paziņojumi. Sistēma ir vienkārši uzstādāma, un to var izmantot gan vieglajām automašīnām, gan arī komerctransportā: nominālais spriegums no 9 V līdz 30 V.

Noderīga informācija 62

Inovācijas lielākai ilgtspējībai *

Gumijas sastāvs, kas izgatavots no vairāk nekā 80% dabīgu, atjaunojamu vai pārstrādātu materiālu
Iepakots 90% pārstrādāta & 100% kartona iepakojumā
Ražots un iepakots Francijā, lai ierobežotu transportēšanu un CO2 emisijas
Radījis Valeo, lai nodrošinātu izcilu tīrīšanas veiktspēju
valeocanopy.com
* Mūsu produkts ir ilgtspējīgāks, jo vairāk tiek izmantoti dabīgi, pārstrādāti vai atjaunojamie materiāli. Sīkāka informācija v ietnē
valeocanopy.com
Noderīga
IZPLŪDES GĀZU
TEMPERATŪRAS DEVĒJI
UZBŪVE UN BOJĀJUMU SEKAS
Kāds auto īpašnieks saskārās ar nesaprotamu situāciju: braucot automašīnai pēkšņi iedegās “Check Engine” un dzinējs pārslēdzās avārijas režīmā. Cilvēks aizbrauca līdz mājām un nākamajā dienā grasījās automašīnu vest uz servisu. Pārsteidzoši, ka no rīta dzinējs darbojās kā parasti – bez jebkāda avārijas režīma.
Defekts bija pazudis pats no sevis? Kā izrādījās, problēma bija vienā no izplūdes gāzu temperatūras devējiem.
Darbības princips

Izplūdes gāzu temperatūras devēji − EGTS (exhaust gas temperature sensor) – ir diezgan vienkāršas ierīces, taču no tiem atkarīgs vairāk, nekā varētu šķist no pirmā acu uzmetiena. EGTS galvenais elements ir termorezistors, kura pretestība mainās atkarībā no temperatūras. No tā, kāds rezistors tiek izmantots, ir atkarīgs devēja veids – PTC (Positive Temperature Coefficient) vai NTC (Negative Temperature Coefficient). Palielinoties temperatūrai, PTC devējam pretestība palielinās, savukārt NTC devējam tā samazinās.
Automašīnās tiek izmantoti abu veidu devēji. Iepriekš izplatītākais veids bija PTC devēji, bet jaunās automašīnās arvien biežāk sastopami NTC tipa devēji, kas strādā precīzāk. Pēc darbības diapazona devēji mēdz būt dažādi: daži darbojas uzreiz pēc dzinēja iedarbināšanas, savukārt citiem jāsasilst līdz noteiktai temperatūrai.
EGTS daudzveidību nosaka lietošanas joma un uzstādīšanas vieta. Izplūdes gāzu temperatūras devēji tiek uzstādīti pirms un pēc turbīnas, pirms vai pēc katalizatora, savukārt dīzeļdzinējos – abās kvēpu filtra pusēs. Darbības princips ir vienkāršs: mainās izplūdes gāzu temperatūra – mainās arī termorezistora pretestība. Signāls tiek nosūtīts uz dzinēja vadības bloku. Elektronika novērtē ne tikai absolūtos temperatūras rādītājus, bet arī atšķirību: piemēram, ieejā un izejā no katalizatora vai kvēpu filtra – šādi tiek kontrolēta izplūdes attīrīšanas sistēmu pareiza darbība.
Absolūtie rādītāji ir svarīgi aizsardzībai pret pārkaršanu: tostarp temperatūras pārsniegšana ir bīstama gan turbīnai, gan katalizatoram, kuram vienkārši var sakust pildījums. Devējs pirms turbīnas var būt iestatīts uz 900 ºC , bet pirms katalizatora – uz 790−800 ºC. Ja temperatūra pārsniegs šo slieksni, devējs pados signālu un dzinēja vadības bloks ierobežos jaudu. Dažos modeļos dzinēja avārijas režīms paliek ieslēgts līdz kļūdas noņemšanai, bet dažos izslēdzas

pats, samazinoties temperatūrai. Dīzeļdzinējos ir vēl viena funkcija. Ja devējs pirms kvēpu filtra neapstiprinās, ka ir sasniegta nepieciešamā temperatūra (vairumā gadījumu ne zemāka par 600 ºC), DPF reģenerācijas process nesāksies.
informācija 64

Defektu cēloņi
EGTS kļūdu kodi var būt dažādi, un jebkurā gadījumā ir svarīgi saprast, kādēļ izplūdes gāzu temperatūra ir pārāk zema vai augsta. Piemēram, temperatūra zem normas izejā no cilindriem var liecināt par pārāk liesu darba maisījumu. Viens no šādas parādības iemesliem var būt gaisa piesūce ieplūdē. Temperatūras pārsniegšanas iemesli arī var būt dažādi, piemēram – nepareiza sprauslu darbība. Ja smidzinātājs neaizveras cieši, tad sprausla var pieliet. Tā rezultātā mainās darba maisījuma sastāvs, turklāt degviela var sadegt izplūdes sistēmā.
Protams, problēma var būt arī pašā devējā. Vienkāršākais veids, kā pārbaudīt EGTS, ir izmērīt tā pretestību. Šeit ir nianse: pretestība atkarīga no devēja temperatūras diapazona un tā veida: PTC vai NTC. Otrais ir īpaši
svarīgi, jo PTC un NTC devēju nominālās pretestības ir absolūti dažādas, un tas, kas vienam ir norma, otram būs kļūda. Piemēram, 20 ºC temperatūrā PTC tipa devēja pretestība ir aptuveni 250−290 Om, savukārt NTC – no 6 MOm. Augstā temperatūrā (piemēram, 900 ºC) situācija mainās: PTC pretestība būs augstāka nekā NTC: 800 Om pret 90 Om. Skaidrs, ka drošības apsvērumu dēļ šādā temperatūrā mērīt pretestību nav ieteicams – tikai pats fakts.
Resurss un nomaiņa
Izplūdes gāzu temperatūras devēji ir gana izturīgas ierīces, resurss var sasniegt 200–250 tūkst. km nobraukuma. Ja kāds no devējiem iziet no ierindas daudz agrāk, tad tas var būt iemesls aizdomāties par dzinēja komponentu stāvokli. Starp citu, problēma var nebūt pašā devējā, bet instalācijā. Devējam sabojājoties, ir tikai viens risinājums: nomaiņa. Šo procedūru labāk nenovilcināt, un kāpēc tā – to var paskaidrot, izmantojot cita autoīpašnieka piemēru.
Tātad automobilis – “VW Touareg”, nobraukums
ir nedaudz virs 200 tūkst. km. Kādā brīdī braucot displejā parādījās kļūda: “Engine fault: Workshop!”, elektronika sāka padot skaņas signālu (pīkstēt), un, nospiežot gāzi, sajūta bija tāda, ka turbīna nedarbojas. Diagnostika parādīja, ka izplūdes gāzu temperatūras devējā, kas uzstādīts pirms turbīnas, ir noticis īssavienojums. Īpašnieks nolēma devēju vēl nemainīt, bet noņemt kļūdu un pagaidām turpināt braukt tā, kā ir. Turklāt, lai noņemtu kļūdu, nevajadzēja katru reizi doties uz servisu: to atrisināja viena vienkārša ierīce un lietotne viedtālrunī.
Protams, ka laika gaitā situācija pasliktinājās, turklāt diezgan ātri: kļūdu nācās noņemt arvien biežāk. Kādā jaukā dienā dzinējs avārijas režīmā pārgāja pavisam nepiemērotā brīdī: uz šosejas, kad autoīpašnieks sāka apdzīt. Viss kārtībā, cilvēkam izdevās atgriezties savā joslā, taču šis gadījums skaidri parādīja, ka ar dažām lietām jokot nevajadzētu. Nākamajā dienā devējs tika nomainīts.
Noderīga informācija 65
JAUNS AIZSARDZĪBAS STANDARTS VISOS
FILTRON FILTROS

Visi FILTRON salona filtri ir aprīkoti ar tehnoloģiju PROTECT+, kas aptur alergēnus un novērš baktēriju un pelējuma attīstību uz filtra. Risinājuma apliecību apstiprina laboratorijas testi, kas veikti MPA institūtā Brēmenē (Vācija).



Mikrodaļiņu pārklājums PROTECT+ ir redzams ar mikroskopu.

ALERGĒNI BAKTĒRIJAS PELĒJUMS PARŪPĒJIETIES PAR KOMFORTU UN DROŠĪBU BRAUKŠANAS
LAIKĀ
FILTRON – TOTAL PRECISION www.filtron.eu








R a v e ns b e r g e r S c h m i e r s t o f f v e r t r i e b G m b H J ölle n b e c k e r S t r a ß e 2 • 3 3 8 24 We r t h e r / G e r ma n y Te le f o n: + 4 9 52 0 3 97 19 - 0 • Te le f a x: + 4 9 52 0 3 97 19 - 4 0 E - m ail: ko n t a k t @ r a v e n ol d e • ww w.r a v e n o l.d eIzdzivo , ,, ,, Zalo elli caur iztuRibu-un ilgtspejibu
CEĻŠ UZ LATVIJAS WRC POSMU 14 GADU GARUMĀ
SARUNA AR “TET RALLY LATVIA” ORGANIZATORU RAIMONDU STROKŠU
Šovasar Latvijā pirmoreiz paredzētais FIA pasaules rallija čempionāta (WRC) posms ir notikums, par kuru noteikti ir dzirdējuši ne tikai rallija entuziasti un līdzjutēji. Lai saprastu, cik plašs, Latvijas autosporta un arī pārējai sabiedrībai nozīmīgs būs šis pasākums, aicinājām uz sarunu “Tet Rally Latvia” organizatoru Raimondu Strokšu.
Teksts: Juris Dargēvičs
Foto: Dace Janova, publicitātes
Rallija līdzjutējiem Latvijā Raimonda Strokša vārds ir zināms jau krietnu laiku – sākotnēji Raimonds bija pazīstams kā ātrs un azartisks rallija pilots, vēlāk kā Talsu rallija organizators. Pateicoties Strokšam un viņa komandai, Latvijā ienāca gan FIA Eiropas rallija čempionāts, gan FIA pasaules čempionāts rallijkrosā. Šovasar Latvijā norisināsies FIA pasaules rallija čempionāta posms “Tet Rally Latvia”, kura pieminēšana vien liek nedaudz straujāk iepukstēties katra sevis cienoša “benzīngalvas” sirdij.
No Talsu rallija līdz pasaules rallija čempionātam
“Cik tas ir nereāli un šķietami neiespējami, kas patiesībā būs tas, kas te norisināsies – kā to izstāstīt cilvēkiem, es joprojām nesaprotu. Ja pirms gadiem četriem mēs runātu par iespēju sarīkot WRC Latvijā, visticamāk, tas tiktu uztverts labākajā gadījumā ar neticību.
Lai atvestu pasaules rallija čempionātu uz Latviju, man tas ir prasījis 14 gadus. Pirmo adrenalīnu kā rallija organizators es “noķēru” 2009. gadā, rīkojot savu pirmo Talsu ralliju. Tagad, pēc šiem visiem gadiem, esmu pieķēris sevi pie domas, ka visā, ko daru, es pret sevi esmu bijis ambiciozs un prasīgs, neko neesmu darījis tāpat vien. Pēc pirmā Talsu rallija sapratu, ka sarīkot ralliju ir gan aizraujoši, gan nereāli grūti. Veiksmīgi noorganizētais rallijs iedeva man to grūdienu un saprašanu, ka pie tā neapstāsimies. Tālāk Eiropas čempionāts rallijā, pasaules čempionāts rallijkrosā –viss kaut kā pa solim ir vedis uz WRC,” stāsta Raimonds Strokšs.
“Pēc 14 gadu pieredzes, kad tik daudz kas ir izdarīts, tu pieķeries WRC un saproti, ka visa tava pieredze ir bērna autiņos. FIA noteikumi, WRC organizatoru rokasgrāmata ir pamats, kam papildus veidojam savu operāciju plānu, kas ietver visu no A līdz Z, ne tikai rallija sportisko daļu, tas iedod saprašanu par visa pasākuma norises specifiku līdz sīkākajām detaļām. Mūsu darāmo darbu “ekselī” ir 800 pozīcijas, nemaz neskaitot visas mazās lietas.”
Ir skaidrs, ka šāda apjoma darbu viens cilvēks paveikt nevar un ir

nepieciešama spēcīga, uzticama komanda. Raimondam tāda ir, beidzamo trīs mēnešu laikā tā izaugusi no sešiem līdz 18 cilvēkiem ikdienā.
“Grūti izskaidrot, cik ļoti pasaules rallija čempionāta sacensību organizēšana atšķiras no visiem citiem līdz šim rīkotajiem pasākumiem. Varētu domāt, ka 180 kilometru ātrumposmos Eiropas čempionātā un te ir 300 kilometru – tātad rallijs vienkārši ir divreiz lielāks, bet tā tas noteikti nav.
Viens piemērs – Eiropas rallija čempionāta sacensību ietvaros mums
Valsts policiju patiesībā nemaz nevajag, 2023. gadā paņēmām palīgā viņus, lai izmēģinātu un uzsāktu sadarbību. Savukārt pasaules rallija čempionāta posma norises četrās dienās būs nepieciešami vairāki desmiti policijas ekipāžu (rallija norises dienās paredzēti teju 100 dažādi darba posteņi) tikai rallijam vien, un
Autosporta jaunumi 68


papildus tam policija piesaistīs savus resursus arī vispārējai satiksmes plūsmas organizēšanai.
Mums ir svarīgi, ka, pārvietojoties starp ātrumposmiem, visur laikā paspētu gan sportisti, gan skatītāji. Paredzams, ka ralliju četru dienu laikā apmeklēs 55 000 cilvēku, un, protams, mēs darīsim visu pēc labākās sirdsapziņas, tomēr esam gatavi arī sarežģījumiem. Aicināsim visus braukt savlaicīgi uz ātrumposmiem, izglītosim mūsu skatītājus. Es tās visas saucu par patīkamajām problēmām, es gribu, lai mums ir tie sastrēgumi, lai ir tas cilvēku daudzums un visi šie izaicinājumi.”
Tāpat organizatoriem ir plānā vairāki skatītājiem domāti jaunumi, kas tiks darīti zināmi nedaudz vēlāk. “Tas būs kaut kas satriecošs, vēl gan nevaram par to runāt, bet tas būs kas nebijis,” piebilst Strokšs.
Plānotā sacensību norise
Raimonds Strokšs ļauj mazliet ieskatīties arī “Tet Rally Latvia” norises plānos. Latvijā notiekošās pasaules rallija čempionāta sacensības ar 20 ātrumposmiem aptvers pusi valsts teritorijas no Rīgas līdz pat Liepājai. “Ceturtdien agri no rīta Liepājā būs iesildīšanās ātrumposms (“Shakedown”), un pēc tam sporta mašīnas dosies uz Rīgu, kur vakarā norisināsies svinīgā rallija atklāšana un pirmais ātrumposms Biķerniekos. Ceturtdien mašīnas “pārnakšņos” Rīgā, un no rīta sportisti dosies uz ātrumposmiem Tukuma un Talsu puses ceļos. Piektdienas vakarā sacensību dalībnieki atgriezīsies Liepājā, lai sestdien mērotos spēkiem ātrumposmos Dienvidkurzemes novadā, Kuldīgas pusē un ap Liepāju. Svētdien rallijs noslēgsies ar diviem ātrumposmiem, kas katrs tiks braukts divas reizes.”
“Tet Rally Latvia” direktors atklāj, ka ātrumposmu kartes tiks pakāpeniski publiskotas, sākot ar aprīli, un skatītāji varēs laikus sākt plānot savu maršrutu. “Ātrumposmi šajā rallijā ir labākais, kas mums Latvijā ir, esam izmantojuši visus ceļus, kas iespējami. Gatavojot rallija trasi, esam iegājuši katrā mājā, izrunājušies ar katru zemes īpašnieku, izbraukuši katru taciņu.”
Raimonds Strokšs rāda sacensību digitālo drošības plānu, un Liepājā, vietā pie Ziemeļu mola, vietā, kur atradīsies servisa parks, rallija centrs un mediju centrs, šobrīd vēl ir tukšs lauks. Tur tiks uzbūvēts servisa parks un “Ramirent” ofisa konteineros izvietots rallija un mediju centrs. Pasākuma apmeklētājiem un skatītājiem būs iespēja bez maksas apmeklēt servisa parku un pašiem tuvumā redzēt WRC komandas un to automašīnas.
Strokšam un viņa komandai ir iespaidīgi plāni ne tikai ātrumposmiem, bet arī rallija atklāšanai. “Es neatkāpšos no mūsu idejām, jo pilnīgi iespējams, ka šis WRC pasākums Latvijā būs vienīgais, un mums tas ir jāuztaisa grandiozs. Rallija automašīnas no Liepājas vedīs ar “Kurbada” evakuatoriem, un tās tiks novietotas Vecrīgā, kur plānots unikāls atklāšanas pasākums, pēc kura sacensību dalībnieki policijas eskorta pavadībā dosies uz Biķernieku trasi. Ceram, ka izskatīsimies labi un tas izskanēs arī pasaulē.”
Dalībnieki
Protams, skatītājus interesē, kādas ekipāžas startēs šajā visu laiku vērienīgākajā Latvijas autosporta pasākumā. Raimonds Strokšs norāda, ka pieteikšanās sacensībām sāksies maijā un beigsies jūnijā. “Tikai tad, kad redzēsim dalībnieku sarakstu, arī varēsim par to runāt. Ir pārliecība, ka dalībnieku saraksts būs ļoti labs. Organizatori ir saņēmuši arī zvanus no vairākiem Latvijas rallija pilotiem, kuri kādu laiku nav piedalījušies sacensībās un šobrīd izrāda interesi par iespēju startēt WRC rallijā.”
“Aizbraucu pie sava drauga Šveda uz Lietuvu (Vitauts Šveda, pazīstams Lietuvas rallija pilots, kas beidzamajos gados rallijos aktīvi vairs nestartē), un viņš saka: “Es braukšu to ralliju. Mans draugs rīko pasaules čempionāta
jaunumi 69
Autosporta
posmu, es visus tos ceļus zinu no galvas, un man nav svarīgs pat rezultāts, es vienkārši gribu tur būt!”
Es domāju, ka tādi būs daudzi, un ļoti ceru, ka viņiem viss izdosies, jo tas nav lēts prieks,” piebilst Strokšs.
Atbalsts
“Nav bijusi neviena reize, kad aizeju uz kādu tikšanos un cilvēki nezina, kas ir WRC – tur ir kāda maģija, kas pievelk cilvēkus. Man ir cerība, kas tas iedos kādu pozitīvu grūdienu Latvijas rallijam un palīdzēs arī nacionālajam čempionātam, jo lielāku satricinājumu par WRC mēs nevaram iedot. Un ja tas radīs jaunu vilkmi un interesi par ralliju, piesaistīs sponsorus mūsu ekipāžām, kā arī jaunus braucējus, tā mums būs labākā uzslava, un tāds arī ir mans personiskais mērķis,” atzīst Raimonds Strokšs.
Pasaules čempionāta posma Latvijā direktors ir priecīgs par cilvēku iesaisti pasākuma plānošanā un atbalstu tā organizatoriem. “Piemēram, policija – puiši ir iesaistījušies, viņi saprot tos apmērus, brauc uz Igauniju, lai gūtu pieredzi, norisinās tikšanās arī vadības līmenī. Mūsu policisti ir sazinājušies ar Lietuvas, Polijas, Somijas policiju un aicinās viņus šurp, lai palīdzētu strādāt ar savu valstu skatītājiem, kas būs atbraukuši uz Latviju, īpaši gadījumos, kad pasākuma laikā rodas valodas barjera.
Laba pieredze ir arī sadarbībā ar ugunsdzēsējiem, arī viņi lieliski saprot savas iesaistes nepieciešamību.

Piemēram, Tukuma pusē mēs slēgsim vairākus ceļus, kas nodrošina iedzīvotājiem ikdienas nepieciešamības. Ugunsdzēsēji jau plāno, kur un ko pārvietos, lai cilvēkiem sagādātu pēc iespējas mazāk sarežģījumu. Visi grib līdzdarboties un palīdzēt, un tā ir fantastiska sajūta.
Veidojot ralliju, cītīgi sastrādājamies ar igauņiem, viņi mums daudz palīdz, tāpat arī mēs dalīsimies ar saviem resursiem, kad pasaules rallija čempionāta posms notiks Igaunijā.”
Skatītāji
Apzinoties, ka šāda mēroga autosporta pasākums Latvijā līdz šim vēl nav norisinājies, un ņemot vērā to, ka rallijs ir aizraujošs, bet tajā pašā laikā
Iepriekšējo gadu “Rally Liepāja” uzvarētāji:
2013 Jari Ketomaa Ford Fiesta RRC
2014 Esapekka Lappi Škoda Fabia S2000
2015 Craig Breen Peugeot 208 T16 R5
2016 Ralfs Sirmacis Škoda Fabia R5
2017 Nikolay Gryazin Škoda Fabia R5
2018 Nikolay Gryazin Škoda Fabia R5
2019 Oliver Solberg Volkswagen Polo GTI R5
2020 Oliver Solberg Volkswagen Polo GTI R5
2021 Nikolay Gryazin Volkswagen Polo GTI R5
2022 Mārtiņš Sesks Škoda Fabia Rally2 evo
2023 Mārtiņš Sesks Škoda Fabia RS Rally2
arī ļoti bīstams sporta veids, likumsakarīgs šķiet jautājums par skatītājiem un to kultūru.
“Par mūsu ilggadējiem skatītājiem es nešaubos, viņi ir ārkārtīgi izglītoti. Tieši pretēji, mums vajadzēs viņu palīdzību, un es vērsīšos pie Latvijas skatītājiem, aicinot viņus būt par rīkotāja atbalstu ātrumposmos. Mani vairāk bažīgu dara vietējie sporta fani, kuri atbrauks uz ralliju varbūt pirmo reizi, un mani uztrauc ārzemnieki, tiesa gan, igauņi mazāk, jo arī viņi ir gana pieredzējuši.
Lai šis pasākums nebūtu vienreizējs, ir nepieciešams visu atbalsts. Ja redzi, ka tas skatītājs ātrumposma malā stāv tur, kur nedrīkst, palīdzi apsargam, ja notiek kāds


Autosporta jaunumi 70
incidents – visiem ir jāstrādā, lai tos cilvēkus dabūtu nost no trases, visu mūsu rokās ir tas, lai šis rallijs izdotos.
No savas puses esam daudz darījuši, lai veicinātu šī rallija pieejamību, izveidojām speciālās biļešu cenas, lai vari aiziet ar ģimeni, ir speciālas biļetes bērniem, jauniešiem. Pirmo reizi 14 gadu laika nesaņēmām nevienu negatīvu komentāru par cenām,” Strokšs ir gandarīts.
Iespēju sadegt ir tūkstotis
Raimonds Strokšs neslēpj, ka pieļauj –pasaules rallija čempionāta posms, kurā tiek ieguldīta milzīga enerģija, var būt ne tikai pirmais, bet arī pēdējais šāda mēroga pasākums Latvijā. “Apstākļu, kas var ietekmēt to, vai WRC Latvijā būs vēl kādu reizi, ir ļoti daudz. Ja godīgi, mēs par to šobrīd pat nedomājam. Vai tas patiks FIA, komandām, čempionāta rīkotājam, vai Latvijas valsts sapratīs, ka tik daudz cilvēku ierašanās mums ir izdevīgi valstiskā mērogā – to visu redzēsim pēc rallija.”
Papildu izaicinājumus rallija organizatoriem sagādā gan viesnīcu pieejamība, gan iespējamās komandu vēlmes attiecībā uz treniņu rīkošanu pirms rallija – to sagatavošanai un veiksmīgai norisei ir jāvelta milzums laika, turklāt vissaspringtākajā brīdī pirms paša rallija.
“Pat ja tas būs vienreizējs pasākums, apzinos, ka es to būšu izdarījis, būšu uzkāpis savā Everestā. Es esmu pilnīgi pārliecināts, ka jebkurā gadījumā mēs būsim paveikuši visu, kas ir mūsu spēkos,” sarunu noslēdz “Tet Rally Latvia” direktors.
FIA pasaules rallija čempionāta posms “Tet Rally Latvia” norisināsies no 18. līdz 21. jūlijam. Pasākums aptvers teritoriju no rallija pilsētas Liepājas līdz pat galvaspilsētai Rīgai, ātrumposmiem norisinoties arī Tukuma novadā, Talsos un Talsu novadā, Kuldīgas novadā un Dienvidkurzemes novadā. Šajā sezonā ir notikušas vairākas izmaiņas WRC komandu sastāvos.
Iepriekšējo divu gadu WRC čempions Kalle Rovanpera šogad plāno veikt daļēju sezonu. Pilnu sezonu brauks Elfins Evanss (Elfyn Evans) un Takamoto Katsuta. Sebastjēns Ožjē (Sebastien Ogier) arī brauks atsevišķos posmos.
Otts Tanaks no “M-Sport Ford” atgriezies “Hyundai”, kur startēja 2020.–2022. gadā. “Hyundai” pilnu sezonu brauks arī Tjerī Noivils (Thierry Neuville), kurš uzvarēja šīs sezonas pirmajā posmā Montekarlo rallijā. Ne visās sacensībās startēs Andreass Mikelsens, kurš pēdējo trīs gadu laikā divreiz kļuvis par WRC2 pasaules čempionu, un Esapeka Lapi. Vienā vai dažos rallijos plāno braukt veterāns Danijs Sordo (Dani Sordo).
“M-Sport” pametis arī Pjērs Luijs Lubē (Pierre-Louis Loubet), kurš šogad brauks WRC2, un “M-Sport Ford” startē ar jaunu sastāvu – Adrijēnu Furmo (Adrien Fourmoux) un Greguāru Munsteru (Gregoirie Munster).

Kopumā pasaules rallija čempionātā šogad notiks 13 posmi. «Rally Estonia» šogad atgriežas Eiropas čempionāta kalendārā, bet rallija direktors Urmo Āva (Urmo Aava) ir apstiprinājis, ka 2025. gadā rallijs būs atpakaļ WRC, Latvijā notiekošās sacensības būs 2024. gada sezonas astotais posms pēc kārtas.
No pašreizējiem “Rally1” klases pilotiem “Rally Liepāja” kā Eiropas rallija čempionāta posmā ir startējis divkārtējais pasaules rallija čempions Kalle Rovanpera – 2016. un 2017. gadā, kā arī Andreass Mikelsens 2021. gadā un Greguārs Munsters 2019. un 2020. gadā.
Par saviem plāniem startēt “Tet Rally Latvia” ir pavēstījis Mārtiņš Sesks/Renārs Francis, tāpat sacensībām gatavojas Matīss Mežaks/Arnis Ronis, kuri plāno braukt ar «Rally2» klases «Škoda Fabia», bet vēl komplektē budžetu un trenējas, aizvadot atsevišķas rallija sacensības.

Autosporta jaunumi 71
Uzziņai
ZIEMAS SEZONA LUTINA RALLIJA BRAUCĒJUS
Šogad ziema lutināja ar tai atbilstošiem laikapstākļiem, līdz ar to arī rallija braucējiem bijusi iespēja aizvadīt pilnvērtīgas ziemas sacensības. Janvāra otrajā pusē notikušais “Rally Alūksne” noslēdzās ar Emīla Blūma un Didža Eglīša pēdējā ātrumposmā burtiski izrautu uzvaru, bet februārī rallijā “Sarma” ātrākie bija viesi no Igaunijas – Egons Kaurs un Allans Birjukovs.

Teksts: Juris Dargēvičs
Foto: Dace Janova
Turpinoties sadarbībai starp kaimiņvalstīm, Alūksnes rallijs šogad atkal bija arī Igaunijas čempionāta atklāšanas posms. Uz starta izgāja gandrīz deviņi desmiti ekipāžu, un bija pārstāvētas ne vien visas Baltijas valstis, bet arī Polija, Somija, Turcija, Spānija un Ukraina. Pirmās sacensību dienas vakarā sportisti veica divus ātrumposmus pa tumsu, vēl astoņi notika nākamajā dienā, un kopējā rallija distance bija nepilni 93 kilometri.
Lai gan ar 1. numuru startēja igauņi Prīts Koiks (Priit Koik) un Kristo Tamms (Kristo Tamm), kuru rīcībā bija jaudīgā “Škoda Fabia Rally2 evo” automašīna, viņi par uzvaru necīnījās. Galvenā cīņa notika starp divām citām ekipāžām. Martins Samsons (Martynas Samsonas) un Ervins Snitks (Ervinas Snitkas) šīs sacensības aizvadīja ar “Hyundai i20 Proto” automašīnu un bija
kļuvuši par rallija līderiem pēc nakts ātrumposmiem, taču saņēma desmit sekunžu sodu par pāragru startu pirmajā dopā. Jau otrās sacensību dienas pašā sākumā lietuvieši vadību atkaroja, tomēr ātrumposmu pirmā apļa laikā tālu no Blūma/Eglīša ekipāžas aizbēgt neizdevās. Mūsu sportisti, kas startēja ar “Mitsubishi Lancer Evo IX”, pēc veiktiem sešiem ātrumposmiem bija tikai pussekundes atstatumā. Tad Samsona ekipāža spēja iekrāt 11 sekunžu pārsvaru, ko Blūms atlikušo trīs ātrumposmu laikā nodzēsa, pēdējos kilometros nodemonstrējot īpaši labu veikumu. Pašmāju ekipāžai tas pēdējā dopā ļāva izvirzīties sacensību kopvērtējuma vadībā un izcīnīt uzvaru ar nieka 0,63 sekunžu pārsvaru. Igauņu Patrika Enoka (Patrick Enok) un Silvera Simma (Silver Simm) ekipāža ar “Ford Fiesta Rally3” auto izcīnīja trešo vietu kopējā ieskaitē, uzvarētājiem pazaudējot gandrīz pusminūti. Startējot ar tādu pašu auto, ceturtie bija viņu tautieši Romets Jurgensons (Romet
Jurgenson) un Sīms Oja (Siim Oja), bet pirmo piecnieku noslēdza latviešu vecmeistari Jānis Vorobjovs ar Guntaru Zicānu – viņi šo sezonu uzsākuši ar “Mitsubishi Lancer Evo VIII”.
“Rallijs “Alūksne” noslēdzies uz ļoti pozitīvas nots,” pēc izcīnītās uzvaras sacīja Emīls Blūms. “Nevienā brīdī necentāmies ķert Martinu, braucām savā ritmā. Tā ir dāvaniņa manam stūrmanim, jo viņš visu nedēļas nogali bija slims ar temperatūru. Tie, kuri ir tuvāk rallijam, saprot, cik grūti ir koncentrēties, kad nejūties uz visiem 100. Ļoti forši, ka izdevās šāda nedēļas nogale. Paldies rallija organizatoriem un foršajiem atbalstītājiem!”
Arī atsevišķi Latvijas rallija čempionāta ieskaitē Blūmam/Eglītim uzvara gan absolūti, gan LRC5 grupā, kamēr Vorobjovs/Zicāns otrajā vietā, zaudējot 52 sekundes, bet tikai ar trīs sekunžu pārsvaru uzveicot Koika/ Tamma duetu, kuri kļuva par LRC2
72
Autosporta jaunumi



uzvarētājiem. Citās ieskaites grupās LRČ vērtējumā uzvaras Alūksnē sasniedza poļi Timoteušs Abramovskis (Tymoteusz Abramowski) un Sebastians Vaks (Sebastian Wach) (“Ford Fiesta Rally3”, LRC3), igauņi Karls Markuss Sei (Karl-Markus Sei) un Martins Leotūtss (Martin Leotoots) (“Peugeot 208 Rally4”, LRC4), Zigurds Kalniņš un Renārs Salaks (“BMW E46 Compact”, LRC6), kā arī Madars Dīriņš un Gints Lasmanis (“Honda Civic Type-R EP3”, LRC7).
Astoņu ātrumposmu ietvaros paralēli Alūksnē notika arī Latvijas rallijsprinta čempionāta un “Historic” jeb vēsturisko automobiļu kausa sezonas atklāšanas cīņas. Par absolūto un RSK8 ieskaites uzvarētāju kļuva turku pilota Kerema Kazaza (Kerem Kazaz) un spānietes Albas Sančesas Gonsalesas (Alba Sanchez Gonzalez) ekipāža ar “Ford Fiesta Rally2” auto. Otrie rallijsprintu noslēdza Miks Ķenavs un Gundars Berķis (“Mitsubishi Lancer

“Rallijs “Alūksne” noslēdzies uz ļoti pozitīvas nots,” pēc izcīnītās uzvaras sacīja Emīls Blūms.
Evo VI”), zaudējot 49 sekundes, kamēr trešie bija Vigo Rubenis/Kristaps Eglīte (“Subaru Impreza”). RSK9 grupā par uzvarētājiem kļuva viesi no Somijas – Isaks Hatanmā (Isak Hatanmaa) un Juho Koski-Lammi (Juho Koski-Lammi) (“Peugeot 208 Rally4”). Savukārt “Historic” kategorijā uzvarēja Kristaps Dzīvītis ar Mārtiņu Rudeviču (“Audi 80 Quattro”).
Ziemai atkāpjoties, šķita, ka leģendārais rallijs “Sarma” šogad varētu nenotikt, taču sacensību nedēļā gan
Gulbenes pusē, gan citviet Latvijā atkal parādījās mīnusi, uzsniga kārtīga sniega sega un ceļi kļuva pilnībā perfekti sacīkšu norisei. Rallijs “Sarma” bija Latvijas rallija čempionāta otrais un Baltijas jūras valstu čempionāta pirmais posms, vienas dienas laikā dalībniekiem mērojot sešus ātrumposmus, kuru distance bija nedaudz virs 90 kilometriem. Šoreiz uz starta stājās nepilni seši desmiti ekipāžu, tostarp no visām trim Baltijas valstīm, kā arī Polijas, Somijas, Turcijas un Ukrainas.
Autosporta jaunumi 73

Absolūti neuzveicami izrādījās igauņu sportisti Egons Kaurs (Egon Kaur) un Allans Birjukovs (Allan Birjukov), kas uz ralliju bija ieradušies ar “Hyundai i20 Proto” automašīnu un uzvarēja visos ātrumposmos. Kamēr pirmās vietas ieguvēji nebija apdraudēti, starp vietējām ekipāžām izvērsās spraiga cīņa par otro vietu. Sākotnēji otrajā pozīcijā atradās Vorobjovs/Zicāns (“Mitsubishi Lancer Evo VIII”), kuri pirmo apli arī noslēdza vicelīderu godā. Tomēr jau SS4 viņu apdzina Blūms/Eglītis, savukārt SS5 garām tika arī Matīss Mežaks un Miķelis Mežaks, kas “Sarmā” startēja ar “SRT PROTO 02”. Šīs divas ekipāžas noslēdzošajos kilometros spraigi cīnījās savā starpā, bet pārāks ar tikai 0,46 sekunžu pārsvaru izrādījās Blūms, liekot veterānam Mežakam piekāpties. Vorobjovs finišu sasniedza ceturtais absolūtajā ieskaitē, bet pirmo piecnieku noslēdza Kalvis Blūms ar Raimondu Zeiļuku (“Mitsubishi Lancer Evo VI”).
“Pirmajā ātrumposmā pats sataisīju ziepes – divreiz izbraucām ārpus trases, un, kā izrādās, otro un trešo ātrumposmu nobraucām faktiski bez viena amortizatora,” pēc sacensību finiša atzina Emīls Blūms. “Paldies “Rallyworkshop”, kuri aizdeva amortizatoru, ko samainīt servisa parkā. Otrajā aplī mēģinājām atgūt to, ko paši zaudējām pirmajā aplī. Paldies skatītājiem, kuru bija patiesi daudz, atbalstītājiem un organizatoriem! Cīņa daudzo skatītāju priekšā bija grūta, jo ātrumposmi bija gana līkumoti un sarežģīti. Bet savu uzdevumu izpildījām.”


Matīss Mežaks pēc rallija atzina, ka Blūma ekipāžu pārspēt neizdevās pašu vainas dēļ: “Otrajā aplī palielinājām tempu. Tās 0,46 sekundes... Protams, varam stāstīt, ka mums Miks Ķenavs patraucēja, kad bija iestidzis kupenā, bet patiesībā paši daudz vairāk pazaudējām dažādās trases vietās. Mums pašiem ir pie kā piestrādāt, lai tā nenotiktu. Bet bija ļoti labi, bija kaifs!”
Latvijas rallija čempionāta vērtējumā Blūms/Eglītis guva uzvaru gan kopējā vērtējumā, gan atsevišķi LRC5 grupā. Mežaku duets ieņēma otro vietu summā, bet uzvarēja LRC1 vērtējumā. Trešie šeit absolūtajā ieskaitē bija Vorobjovs/Zicāns. Savās ieskaites grupās uzvaras “Sarmā” sasniedza turki Kerems Kazazs un Ali Emre Jilmazs (Ali Emre Yilmaz) (“Ford Fiesta Rally2”, LRC2), Guntis Lielkājis un Vilnis Miķelsons (“Mitsubishi Lancer Evo X”,
LRC3), kuri atgriezās rallijā pēc ilgākas pauzes, somu sportisti Hantamā/ Koski-Lammi (“Peugeot 208 Rally4”, LRC4), Ralfs Sirmacis/Jānis Sokolovs (“BMW 330i E36”, LRC6) un Dīriņš/ Lasmanis (“Honda Civic Type-R EP3”, LRC7).
Latvijas rallijsprinta čempionāta otrā posma ietvaros dalībnieki veica četrus dopus, bet par absolūtās ieskaites un RSK8 grupas uzvarētājiem kļuva Kazazs/Emre Jilmazs, par 15 sekundēm uzveicot lietuviešus Ramūnu Čapkausku (Ramūnas Čapkauskas) un Žilvinu Jurši (Žilvinas Juršys) (“Mitsubishi Lancer Evo IX”), bet par gandrīz minūti – latviešu braucējus Elvisu Hermani/Dāvi Vāni (“SRT PROTO 01”). RSK9 vērtējumā ātrākie atkal bija Hantamā/Koski-Lammi, tikmēr starp “Historic” kausa dalībniekiem uzvarēja Dzīvītis/Rudevičs (“Audi 80 Quattro”).

Autosporta jaunumi 74
TIKAI TRĪS BURTI NODROŠINA AUGSTĀKO VEIKTSPĒJU
UN PRECIZITĀTI

AUGSTĀKĀS TEHNOLOĢIJAS NO NGK UN NTK
Uzticieties pārbaudītām tehnoloģijām, kas nodrošina maksimālu veiktspēju un precizitāti. NGK un NTK — populārie zīmoli aizdedzes tehnoloģijām un transportlīdzekļu elektronikai.
• Aizdedzes sveces
• Kvēlsveces
• Aizdedzes spoles
• Aizdedzes vadi un piederumi
• Skābekļa sensori
• Izplūdes gāzu temperatūras sensori
• MAP/MAF sensori
• Dzinēja ātruma un pozīcijas sensori
• Izplūdes gāzu recirkulācijas vārsti
• Izplūdes gāzu un diferenciālā spiediena sensori
Niterra EMEA GmbH Harkortstrasse 41 • D-40880 Ratingen
Autosporta jaunumi
TOMASS ŠTOLCERMANIS UZSĀK FORMULU PILOTA KARJERU
Aizvadījis vairākas spožas sezonas kartinga sacensībās, jaunais un talantīgais latviešu autosportists Tomass Štolcermanis piedzīvojis debiju formulu kategorijā. Pirmās cīņas ar sevi, trasi un konkurentiem jau aizvadītas, un arī pirmais lielais līgums ir kabatā – šosezon pilots pārstāvēs “Prema Racing”, kas junioru kategorijā ir viena no vadošajām komandām Eiropā.
Teksts: Juris Dargēvičs
Foto: F4 UAE un no T. Štolcermaņa privātā arhīva
Kartingā Tomass pirmo reizi iesēdās jau trīs ar pusi gadu vecumā, bet sešos gados izcīnīja pirmo pjedestālu. 2021. gadā nāca “Rotax Max Challenge Grand Finals” pasaules junioru čempiona tituls, bet pērn sasniegta godalgotā trešā vieta Eiropas kartinga čempionātā KZ2 klasē un ceturtā vieta OK kategorijā. Šobrīd sportistam ir 16 gadi un īstais brīdis, lai uzsāktu gaitas formulu sacensībās. Pirmās nopietnās mācību stundas trasē jau aizvadītas.
Gadsimta pirmajā desmitgadē bija vairāki latviešu jaunie braucēji, kas mēģināja sevi pierādīt formulu kategorijā – Tomasa krusttēvs Haralds Šlēgelmilhs nonāca pat līdz startēšanai GP2 klasē (mūsdienu F2), tāpat trasē bija redzami tādi piloti kā Otto Birznieks un Karlīne Štāla. Savulaik, vēl 2004. gadā, Lielbritānijas “Formula Ford” gatavojās startēt Tomasa tētis Mareks Štolcermanis, taču mērķi neizdevās īstenot smaga ceļu
satiksmes negadījuma dēļ, kas lielā mērā pārvilka svītru karjerai. Tagad ar jaunām cerībām savas gaitas formulu sacensībās uzsācis Tomass, un šis ir tikai sākums.
Tomasa Štolcermaņa talantu apliecina arī fakts, ka divus gadus pēc kārtas sportists ticis uzaicināts uz “Ferrari” jauno pilotu programmas skautu nometni Itālijā. Viņš ir vienīgais, kurš šādu iespēju saņēmis divreiz, lai gan līdz lielajam finālam aizcīnīties neizdevās. “Ferrari Driver Academy” ir viena no spēcīgākajām jauno pilotu attīstības programmām, kurā tiek vien izredzētie, un tā ir cieši saistīta ar “Formula 1” čempionātu. Caur šo programmu savulaik karjeru būvējuši tādi piloti kā Šarls Leklērs, Žils Bjanki, Lānss Strols, Serhio Peress un Miks Šūmahers. Lai gan pagaidām Tomasam tajā iekļūt nav izdevies, savā sastāvā jauno talantu uzņēmusi itāļu komanda “Prema Racing”, kas cieši sadarbojas ar “Ferrari” rūpnīcu.
Pirmo uzaicinājumu pārstāvēt komandu Štolcermanis saņēma pērn novembrī un izmantoja izdevību aizvadīt Dienvidaustrumāzijas “Formula 4” čempionāta posmu Sepangas trasē, kur savulaik notikušas arī

F1 sacensības. Lai gan šīs bija latviešu braucēja pirmās formulu sacīkstes dzīvē, viņš sevi uzreiz pierādīja kā vienu no vadošajiem braucējiem, bet pats galvenais – stabili progresēja. Sestā vieta pirmajā braucienā, ceturtā otrajā un jau trešā noslēdzošajā sacīkstē.
“No mana skatupunkta ļoti, ļoti solīda nedēļas nogale, ļoti laba debija,” sacīja Haralds Šlēgelmilhs, kurš palīdz savam krustdēlam treniņu procesā. “Visas nedēļas nogales garumā Tomass progresēja. Trešā sacīkste bija sarežģīta, bija ļoti slapja trase un izaicinoši apstākļi. Tomass tik galā ļoti labi. Pats svarīgākais, ka bija progress visa vīkenda garumā. Skaidrs, ka ir lietas, pie kurām pilnveidoties, uzlabot. Noteikti var vēl labāk! Es teiktu, ļoti labs sākums un jācer uz jaudīgu turpinājumu.”
76

T. Štolcermanis un “Prema Racing”.
Šogad Štolcermanis aizvadīs pilnu "Formula 4” sezonu, līdz ar to var teikt, ka šis viņam būs līdz šim svarīgākais gads sacīkšu braucēja karjerā. Jāapgūst ļoti daudz un paralēli jāmēģina sevi pierādīt no labākās puses. Pamats tam sarūpēts cienījams – kontraktu ar latvieti parakstījusi “Prema Racing” komanda, kas junioru formulu kategorijā saucama par vienu no spēcīgākajām. Tomass aizvadīs visus posmus prestižajā Itālijas F4 čempionātā, kur startējuši un panākumus guvuši tādi braucēji kā jau pieminētie Strols un Šūmahers, tāpat


Autosporta jaunumi 77
Guanju Žou un Lando Noriss. Viņa komandas biedri būs jaunie talanti Fredijs Sleiters, Alekss Pauvels, Kīns Nakamura-Berta un Rašids al Daheri – vieni no iepriekšējo gadu spēcīgākajiem pasaules kartinga braucējiem. Sezona startēs maijā, un kopumā tiks aizvadīti septiņi posmi. Tāpat Štolcermanis startēs “Euro 4” formulu seriālā, kas pirmo reizi notika vien pagājušajā gadā. Šis čempionāts sāksies jūnijā un notiks četru posmu ietvaros. Latviešu jauno sportistu šosezon redzēsim startējam tādās leģendārās trasēs kā Monca, Imola, Hungaroringa, Barselona, Mudžello, “Red Bull Ring” un citas.
“Kas gan var būt labāks kā uzsākt karjeru formulu sacīkstēs kopā ar tik augsta līmeņa komandu kā “Prema”? Nevaru vien aprakstīt vārdos, cik pateicīgs esmu par šo iespēju,” neslēpj Tomass Štolcermanis. "Debiju tās sastāvā jau esmu piedzīvojis un esmu ļoti apmierināts ar komandu. Nevaru vien sagaidīt nākamās sacīkstes un mūsu kopīgo ceļojumu 2024. gadā. Ar aizrautību uzsākšu savu debijas sezonu. Būs grūti sacensties ar ātrākajiem braucējiem pasaulē, bet esmu drošs, ka komanda man dos visu savu spēku un kopā piedzīvosim sekmīgu izaugsmi. Darīšu visu, ko spēšu."

Iesildīšanos Itālijas čempionātam Štolcermanis sācis ar dalību Apvienoto Arābu Emirātu F4 seriāla noslēdzošajos posmos. Sacensības Abū Dabī trasē izvērsās smagas, bet labu pieredzi nesošas. Pēc pirmajā braucienā piedzīvotās “taustīšanās” otrajā sacīkstē slapjā trasē jau bija

vērojams zīmīgs progress. Izdevās atgūt deviņas pozīcijas un finišēt 16. vietā. Jāņem vērā, ka uz starta stājās ļoti daudzi no šī brīža spēcīgākajiem F4 pilotiem, turklāt vairums no viņiem aizvadījuši vairāk sacīkšu par mūsu sportistu. Trešajā braucienā arī izdzīvota rūgtā izstāšanās garša, kad viens no konkurentiem neprata sadalīt trasi ar Tomasu.
“Pēc trīs mēnešu pauzes bija diezgan grūti ieiet ritmā, un ja vēl konkurenti ir braukuši sacensības pirms tam,” pēc sacensībām Abū Dabī atzina Tomass Štolcermanis. “Treniņi piektdien tika aizvadīti tikai ar progresu un trases mācīšanos. Sestdien bija divas kvalifikācijas, kur pirmajā trāpījās slikts riepu komplekts, bet otrajā bija diezgan sakarīgs rezultāts – 16. vieta. Pirmā sacīkste notika naktī, un braucām ar pirmās kvalifikācijas riepu komplektu – nevarēju saprast formulu. Svētdien otrā sacīkste tika aizvadīta ar ļoti lielu lietu, bet pa lietu jau bija neliela pieredze un atbraucu no 25. pozīcijas uz 16. Un trešajā sacīkstē pirmajā aplī 14. līkumā, nosedzot iekšmalu, bija par maz, un cits braucējs, nogriežot trasi, ieskrēja man sānos. Braucienu nevarēju turpināt. Gan pozitīvas, gan ne tik pozitīvas sacīkstes. Bet labs pieredzes guvums īstās sezonas sākumam Itālijā. Ir redzams, kur vajag attīstīties, un tie ir galvenie punkti.”
Uz pjedestāla F4 Sepangas trasē.
Autosporta jaunumi 78
T. Štolcermanis “F4 UAE” sacensībās Dubaijā.
Līdzunvairākpar
100000km
tīriunklusi

maksimālu klusumu braukšanas laikā.

Izmantojot Brembo nepārspējamās OE kvalitātes specifikācijas, jūs iegūstat sirdsmieru, zinot, ka jūsu bremzes ir vislabākajā kārtībā un aizsargātas pret rūsu jebkuros apstākļos, jebkurā braucienā līdz 100 000 km un vēl tālāk.
Tas ir speciāli izstrādāts vadošajiem automašīnu ražotājiem un autovadītājiem visā pasaulē, kuri vienmēr pieprasa vairāk par ierasto.
BREMBO OE KVALITĀTE
MAZĀK TROKŠŅA
AIZSARDZĪBA PRET
KOROZIJU
SPECIFISKS BEYOND EV KIT
EV
GADA NOTIKUMS F1 PASAULĒ: HAMILTONS PIEVIENOJAS “FERRARI”
Cīņa par čempiona titulu, bez šaubām, ik gadu ir galvenā intriga “Formulā 1”, tomēr šogad to pārspēt varētu nesen notikušais darījums pilotu tirgū – sezonas beigās Lūiss Hamiltons (Lewis Hamilton) pametīs “Mercedes” komandu, lai jau 2025. gadā startētu “Ferrari” sastāvā. Šobrīd tas jau zināms pilnīgi oficiāli.
Teksts: Juris Dargēvičs
Foto: depositphotos.com
Red Bull Content Pool;

Noslēdzoties pērnā gada sezonai, šķietami daudz intrigu nebija. “Red Bull” komanda neuzvarēja tikai vienā no 22 posmiem, bet Makss Verstapens (Max Verstappen) trešo sezonu pēc kārtas kļuva par pasaules čempionu, sasniedzot 19 no šīm uzvarām. Tieši tik liels bija talantīgā holandiešu autosportista pārspēks pār visiem, ieskaitot komandas biedru Serhio Peresu (Sergio Perez), kurš kopvērtējumā ierindojās otrajā vietā, bet atpalika 290 punktus. Tās ir gandrīz 12 uzvaras, kas šķīra čempionu no vicečempiona! Ne viens vien nodēvējis Verstapenu par visu laiku labāko F1 pilotu, līdz ar ko noteikti esam liecinieki vēsturiskai ērai. Lai gan pilotu tirgū intrigas bija, beigās viss atrisinājās iespējami vienkāršākajā veidā – tie, kam līgumu uz nākamo sezonu vēl nebija, tos parakstīja. Līdz ar to šī ir pirmā reize visā F1 vēsturē, kad divas sezonas pēc kārtas visas komandas startēs nemainīgos sastāvos.
Tiesa gan, daudziem braucējiem, tostarp vadošajiem, saistības ar savām komandām bija (un daļai aizvien ir) vien līdz 2024. gada izskaņai, kas solīja, ka šogad pilotu tirgū varētu notikt ļoti interesantas pārejas. Intrigu krietni samazināja septiņkārtējais F1 čempions Hamiltons, pēc ilgas vilcināšanās noslēdzot jaunu līgumu ar savu ilggadējo komandu “Mercedes” līdz 2026. gadam. Pavisam nesen pie jauniem ilgtermiņa kontraktiem tika arī Šarls Leklērs (Charles Leclerc) (“Ferrari”) un Lando Noriss (Lando Norris) (“McLaren”), tāpēc lielākie skeptiķi jau sāka bažīties, ka nekas liels šajā jomā tomēr arī šogad nav gaidāms. Tomēr tad nāca negaidītais.
Lai gan par Hamiltona iespējamo pāriešanu uz “Ferrari” baumas klīdušas jau gadiem, pienāca diena, kad, reti kuram nojaušot, leģendārā itāļu vienība paziņoja par titulētā britu pilota nolīgšanu jau uz 2025. gada sezonu.
Tas nozīmē, ka ne tik sen noslēgtā vienošanās ar “Mercedes” tiks lauzta gadu pirms termiņa beigām, bet Karloss Sainss (Carlos Sainz) savu vietu Maranello vienības sastāvā zaudēs. Nav šaubu, ka par šo notikumu runas klīdīs visa gada garumā, un, ja sezona izrādīsies ne tik aizraujoša, ļoti iespējams, tam būs lemts kļūt par gada galveno notikumu.
Jau tagad sākusi velties baumu lavīna ap to, kurš aizvietos Hamiltonu gluži pievilcīgajā vakancē “Mercedes” komandā, un šajā sakarā tiek pieminēti daudzi. Arī F1 ekspertiem un bijušajiem braucējiem ir dažādi viedokļi. Viens no tiem vēsta, ka jau nākamgad “Mercedes” rindas varētu papildināt Fernando Alonso (Fernando Alonso). Savos 42 gados būdams vecākais no čempionāta braucējiem, spānis pērn pierādīja, ka savu pulveri vēl nepavisam nav izšāvis, un “Aston Martin” sastāvā, no snieguma viedokļa, iespējams, aizvadīja savu
Autosporta jaunumi 80

labāko sezonu. Visai uzticami avoti ziņo, ka “Mercedes” vadība ar Alonso jau aprunājusies un, iespējams, būtu gatava pieņemt sportistu savās rindās, taču vispirms vēlas palūkoties, vai arī gaidāmajā sezonā veterāns spēs sevi parādīt tikpat spoži kā iepriekš. Vēl ir versija, ka “Mercedes” un tās vadītājs Toto Volfs (Toto Wolff) varētu spert drosmīgu soli un Hamiltonu aizvietot ar savu protežē – jauno talantu Andrea Kimi Antonelli (Andrea Kimi Antonelli), kurš tikai šogad debitēs “Formulā 2”. Sainss, Estebans Okons (Esteban Ocon), Daniels Rikjardo (Daniels Ricciardo) un Alekss Albons (Alex Albon) arī iekļauti šajā potenciālo “Mercedes” pilotu sarakstā.
Tikmēr jaunā sezona vairs nav aiz kalniem, komandas jau viena pēc otras prezentē savas jaunās mašīnas un to krāsojumus. Februāra beigās Bahreinā trīs dienu garumā norisinājās oficiālie testi, savukārt jau 2. martā turpat

Sahiras trasē startēja F1 čempionāta pirmais posms. Šis būs rekorda gads, jo pirmo reizi vēsturē notiks 24 posmi. No tiem sešos risināsies sprinta sacensības, kas tiek rīkotas jau pāris gadus. Jaunas trases klāt nav nākušas, bet atgriezies posms Šanhajā un Imolā. Ķīnas “Grand Prix” izcīņa pandēmijas dēļ nav notikusi kopš 2019. gada, bet Emīlijas-Romanjas “Grand Prix” pērn atcēla reģionā esošo plūdu dēļ.
Lai gan visi piloti saglabājuši savas līdzšinējās vietas sastāvos, vairākās komandās notikušas būtiskas izmaiņas. No F1 čempionāta aizgājusi “Alfa Romeo”, kas iepriekš bija “Sauber” titulsponsors, vienībai nesot Itālijas autorūpnīcas vārdu. Tagad par tās galvenajiem sponsoriem kļuvušas divas savā starpā saistītas kompānijas, līdz ar ko komandas jaunais nosaukums būs “Stake F1 Team”. Savukārt šasija būs nosaukta “Kick” vārdā. Tas gan tikai pārejas posma laikā, jo jau 2026. gadā, kad spēkā stāsies jaunie tehniskie noteikumi, šī pārtaps par “Audi” rūpnīcas komandu. Arī “Red Bull” piederošā “AlphaTauri” vienība mainījusi savu veidolu. Pateicoties jaunajam sponsoram, šosezon tā sauksies “Visa Cash App RB F1 Team”. Daži to paspējuši nodēvēt par sliktāko komandas nosaukumu visā F1 vēsturē.
Savukārt amerikāņu komanda “Haas”, pērn paliekot pēdējā vietā Konstruktoru kausā, no amata atbrīvojusi vadītāju Ginteru Steineru (Gunther Steiner). Šis ir daudzu līdzjutēju iemīļots personāžs viņa krāšņās valodas dēļ un bija trešais visilgāk savā amatā strādājošais F1 komandas vadītājs aiz Kristiana Hornera (Christian Horner) (“Red Bull”) un Toto Volfa (“Mercedes”).
Ir grūti prognozēt spēku samērus, lai gan vairums nešaubās, ka šis būs vēl viens “Red Bull” dominances gads. Tā noteikti varētu būt, bet ar interesantiem izteikumiem nācis klajā komandas galvenais sacīkšu auto dizainers Adrians Ņūvijs (Adrian Newey). Viņš apgalvo, ka jaunais sacīkšu auto faktiski ir 2022. gada modeļa uzlabota versija. Lai gan pērn šāds solis, nebūvēt jauno auto no nulles, izrādījās negaidīti sekmīgs, šogad, pēc Ņūvija vārdiem, tas varētu izrādīties pārāk konservatīvs risinājums. Citas komandas, bez šaubām, vēro, ko tehniskajā frontē dara vadošā F1 vienība, un mēģina rast līdzvērtīgus risinājumus. Vai tas būs izdevies, redzēsim jau pavisam drīz. Ja vien nenotiek negaidītais, lielākie konkurenti “Red Bull” būs “McLaren”, “Ferrari” un “Mercedes”, kā tas bija jau 2023. gada sezonas noslēgumā.
jaunumi 81
Autosporta
Autosporta jaunumi
LEĢENDĀRAJAM SAINSAM VECUMS NAV ŠĶĒRSLIS
UZVARAI DAKARAS RALLIJĀ


Autosporta leģenda Karloss Sainss (Carlos Sainz) 61 gada vecumā izcīnījis savu ceturto uzvaru Dakaras rallijā un pirmo “Audi Sport” komandai, kas līdz ar šo panākumu atvadās no rallijreida. Saūda Arābijā notikušās sacensības sarūpēja visdažādākās intrigas, bet pāris dienas pirms finiša no cīņas par uzvaru izkrita Sebastjēns Lēbs (Sebastien Loeb), kuram kārtējo reizi sapnis par galvenās balvas izcīnīšanu jāatliek vēl uz gadu.
Teksts: Juris Dargēvičs
Foto: Red Bull Content Pool; A.S.O.
Dakaras rallijs šogad notika jau 46. reizi un piekto gadu pēc kārtas risinājās Saūda Arābijas smilšu plašumos. Šoreiz sacensības startēja oāzes pilsētā Alulā, vēlāk dalībnieki šķērsoja milzīgo Rubelhālī tuksnesi, tad devās atpakaļ rietumu virzienā un pēc vairāk nekā divas nedēļas ilgušajām cīņām finišēja Sarkanās jūras piekrastes pilsētā Janbu. 15 dienu laikā tika veikts prologs un 12 ātrumposmi. Sestais posms bija jauns un unikāls,
risinoties divas dienas, kad 48 stundu laikā sportistiem bija jāveic noteikta distance, nakšņojot teltīs un iztiekot bez tehniskās palīdzības no savām komandām. Rallija kopējā distance bija gandrīz 8000 km, no kuriem ap 4700 km tika veikti ar laika kontroli. Kopumā startēja 345 tehniskās vienības – 136 motocikli, 10 kvadricikli, 73 automašīnas, 43 “Challenger” bagiji, 36 SSV bagiji, kā arī 47 smagās mašīnas. Vēl 80 ikdienā vairs ne tik bieži ieraugāmi braucamrīki izgāja uz starta klasisko spēkratu kategorijā.
Automobiļu ieskaitē par būtisku intrigu bija parūpējies iepriekšējo divu gadu Dakaras uzvarētājs Nasers al
Atija (Nasser Al-Attiyah), kurš daudzus gadus ar panākumiem startēja “Toyota” rūpnīcas vienībā, bet šogad pārgāja uz "Prodrive” nometni, kas pagaidām vēl šajā rallijā ne reizi nav uzvarējusi. Katariešu pilota mērķi ir tālejoši, jo jau 2025. gadā “Prodrive” kļūs par “Dacia” rūpnīcas komandu un tajā startēs gan viņš, gan ilggadējais šīs vienības braucējs Lēbs. Tā kā “Audi” rūpnīca 2026. gadā debitēs F1 čempionātā, šis tai bija pēdējais Dakaras rallijs – elektrisko auto pilotēja Sainss, kā arī Stefans Petransels (Stephane Peterhansel) un Matiass Ekstroms (Mattias Ekstrom). Pēc al Atijas aiziešanas vājākā sastāvā šogad brauca “Toyota” nometne, lai
82



gan sevi labi spēja apliecināt jaunais talants Sets Kvintero (Seth Quintero), tāpat komandu pārstāvēja šajā rallijā iepriekš vienreiz uzvarējušais Žinels de Viljē (Giniel de Villier), arī Lukass Moraess (Lucas Moraes) un Saūds Variava (Saood Variawa). Arī “Overdrive”


komanda, kas startē ar “Toyota” automašīnām, allaž spēj būt starp līderēm – tās sastāvā arī šogad brauca spēcīgais Jazīds al Radži (Yazeed Al-Rajhi), tāpat Giloms de Mēviuss (Guillaume de Mevius), Huans Kruzs Jakopīni (Juan Cruz Yacopini), Gerlēns
Šišerī (Guerlain Chicherit) un vēl vairāki piloti. Pirmo reizi Dakarā piedalījās “M-Sport” rūpnīcas vienība ar “Ford” mašīnām – viens no pilotiem bija panākumiem bagātais Nani Roma (Nani Roma), kurš atgriezies sacensībās pēc smagas slimības uzveikšanas.
Autosporta jaunumi 83


Sacensību sākumā vadībā pabija gan Ekstroms, gan de Mēviuss, pēc trešā posma līderos bija izvirzījies Sainss, bet pēc tam trīs dienas pirmo pozīciju turēja al Radži. Pirms maratonposma līderus šķīra pavisam maz. Lēbs bija saņēmis sodu par kontrolpun kta izlaišanu un tobrīd atpalika jau virs 40 minūtēm. Tomēr, kā tas bija gaidāms, lielas korekcijas ieviesa “48H Chrono” posms, kas notika divas dienas. Jau pirmajā dienā avāriju piedzīvoja sacensību līderis al Radži, bet otrajā dienā cerības uzvarēt pazaudēja uzreiz divi no vadošajiem braucējiem. Dakaras titulētākais pilots Petransels jau pirms tam bija zaudējis laiku plīsušu riepu un navigācijas kļūdu dēļ, bet tehniskas problēmas ar hidrauliku lika pazaudēt vēl vairākas stundas. Al Atija pirms tam sacīkšu kopvērtējumā atradās vien deviņas minūtes aiz līdera, bet pēc al Radži negadījuma saglabāja labas izredzes pārņemt vadību. Tomēr maratonposma otrajā dienā arī viņu piemeklēja tehniska ķibele – salauzts stūres mehānisms lika pazaudēt vairākas stundas un arī cerības trešo gadu pēc kārtas kļūt par Dakaras čempionu. Pēc notikušā par līderi kļuva Sainss, bet uz otro vietu pacēlās Ekstroms, kurš savukārt septītajā posmā bija spiests palikt tuksnesī ar salauztu aizmugurējo piekari. Tā visa rezultātā sākās duelis starp divām leģendām. Lēbs nonāca otrajā vietā un vajāja līderi, divus posmus pirms finiša esot vairs tikai 13 minūšu atstatumā. Diemžēl cīņa izšķīrās jau priekšpēdējā dienā, kad Lēbs pamanījās piecas reizes caurdurt riepas un vēl arī saskārās ar bojājumiem



piekarē. Sainss pārliecinoši aizbrauca līdz finišam, kamēr de Mēviuss pacēlās uz otro vietu un to noturēja, lai gan uzvarētājam pazaudēja 1 stundu un 20 minūtes. Lēbs pamanījās finišēt trešais, vēl deviņas minūtes tālāk.
“Šī uzvara man nozīmē ļoti daudz, “Audi” vienmēr ticēja šai īpašajai mašīnai, un mēs nekad nepadevāmies,” sasniedzot finišu, atzina Karloss Sainss. “Lai manā vecumā atrastos šajā līmenī, pirms tam sagatavošanās procesā ir jāizdara ļoti daudz. Tas nenāk tāpat vien. Tomēr tas tikai parāda, ka, ja tu smagi strādā, parasti tas atmaksājas. Nepietiek tikai ar to, ka esi jauns, jo sevi ir jāpierāda.”
Sainss kļuvis par vecāko Dakaras rallija uzvarētāju, lai gan rekords, ko viņš pārspējis, jau līdz šim piederēja pašam spāņu veterānam. Sportistam, kurš savulaik divas reizes kļuva par pasaules rallija čempionu, Dakarā šī ir jau ceturtā uzvara. Iepriekšējo reizi viņš pirmo vietu izcīnīja 2020.
gadā “X-Raid Mini” komandas sastāvā, bet vēl pirms tam uzvarēja arī 2018. gadā ar “Peugeot” un 2010. gadā ar “Volkswagen” rūpnīcas mašīnām.
Arī šogad prāvā skaitā Dakarā startēja lietuvieši, bet automobiļu klasē bija divi izteikti spēcīgi piloti, kas pēdējos gados vienmēr cenšas pretendēt uz pirmo desmitnieku. Tā tas bija arī šajā reizē, taču mērķi izdevās sasniegt tikai vienam no viņiem. “Toyota Gazoo Racing Baltics” komandas pilots Benedikts Vanags (Benediktas Vanagas) brauca ekipāžā ar igauņu stūrmani Kuldaru Siku (Kuldar Sikk), un kopīgiem spēkiem tika gūta astotā vieta. Vanagam ilgus gadus mērķis bija beidzot finišēt “Top 10”, vairākkārt viņš bijis ļoti tuvu tam, tostarp guvis 11. vietu 2019. gadā un 12. vietu 2021. gada sacensībās. Rallija pirmajā pusē ekipāža turējās otrajā desmitniekā, pēc septītā posma ielauzās starp vadošajām desmit ekipāžām, bet īpaši labi aizvadīja pēdējos posmus, desmitajā pat sasniedzot trešo
Autosporta jaunumi 84





vietu. Finišā astotais rezultāts, kas Dakaras rallija vēsturē Baltijas valstu sportistiem ir augstākais sasniegums automobiļu kategorijā. Vaidots Žala (Vaidotas Žala) uzskatāms par līdzvērtīga līmeņa pilotu un šogad startēja “X-Raid Arijus” komandā, saņemot spēcīgu tehnisko atbalstu. Viņa līdz šim augstākie sasniegumi bija 11. vieta 2022. gadā un 12. vieta 2019. gadā. Aizvadot ļoti labas sacensību pirmās dienas, pēc pieciem posmiem Žala ar līdzbraucēju, portugāli Paulo Fiuzu (Paulo Fiuza) atradās jau septītajā vietā kopvērtējumā. Diemžēl, līdzīgi kā vairākiem līderiem, arī viņiem liktenīgs izrādījās maratonposms. Šķērsojot vienu no kāpām, gadījās iebraukt bedrē, pret kuru mašīna atdūrās, un tika salauzts amortizators. Tā kā to nomainīt uzreiz neizdevās, tika zaudēts ļoti daudz laika. Finišu gan Žala sasniedza, bet vien otrajā simtniekā. “Challenger” klasē par uzvarētāju kļuva spāniete Kristina Gutjeresa (Cristina Gutierrez), kas par 36 minūtēm

pārspēja Miču Gatriju (Mitch Guthrie). Lietuvai panākumi arī šeit, jo augsto trešo vietu izcīnīja Roks Baciuška (Rokas Baciuška). Uzvarētājai tikai zaudēta nepilna stunda. SSV ieskaitē francūzis Havjērs de Sultrē (Xavier de Soultrait) tikai par nieka divām ar pusi minūtēm pēc divu nedēļu cīņas pārspēja Žeromu de Sadelēru (Jerome de Sadeleer). Devītajā vietā finišēja lietuviešu pilotes Emilijas Gelažninkienes (Emilija Gelažninkienė) ekipāža. Klasisko mašīnu kategorijā, kur cīņas nenotika uz laiku, bet punktiem, kā uzvarētājs finišu sasniedza spāņu pilots Karloss Santaolalla (Carlos Santaolalla) ar “Toyota Land Cruiser”.
Kā allaž ļoti spraigas cīņas noritēja motociklu kategorijā. Lai gan vairākiem favorītiem sacensības noslēdzās ar kritieniem un dažiem arī ar traumām,
otro reizi karjerā uzvaru guva amerikānis Rikijs Brabeks (Ricky Brabec) no “Honda” vienības. Tikai aptuveni 11 minūtes viņam zaudēja Ross Brančs (Ross Branch) no “Hero” rūpnīcas nometnes, bet trešais šajā gadā bija Brabeka komandas biedrs Adrijēns van Beverens (Adrien Van Beveren), kuram līdz uzvarai pietrūka virs 12 minūtēm. Pirmo piecnieku noslēdza KTM braucēji Kevins Benjavidess (Kevin Benavides) un Tobijs Praiss (Toby Price). Starp kvadriciklu braucējiem argentīnietis Manuels Anduhars (Manuel Andújar) ar astoņu minūšu pārsvaru uzveica Aleksandru Žirū (Alexandre Giroud). Lietuvas sportists Laisvids Kancjus (Laisvydas Kancius) guva ceturto vietu, bet Antans Kanopkins (Antanas Kanopkinas) – piekto.
Autosporta jaunumi 85
AUTOMĀTISKO PĀRNESUMKĀRBU
eļļas filtri
Purflux laiž klajā savu jauno automātisko pārnesumkārbu filtru klāstu, kas sastāv no pilniem komplektiem ar 2 dažādiem piedāvājumiem atbilstošiem
pārnesumkārbu veidiem
EXPERT KITS
BASIC KITS
EKSPERTU KOMPLEKTS

PAMATKOMPLEKTS

✦ PAMATKOMPLEKTS
PX TKxxx
Sastāv no filtra un blīves
✦ EKSPERTU KOMPLEKTS
PX TEKxxx
Sastāv no filtra, blīves, eļļas noliešanas skrūves, eļļas kartera skrūvēm, magnētiem un citām blīvēm.
PURFLUX AUTOMĀTISKO PĀRNESUMKĀRBU FILTRU KOMPLEKTI
Piedāvā pilnu komplektu optimālai filtra nomaiņai. Ir svarīgi nomainīt visas saistošās daļas pārnesumkārbas filtra maiņas laikā (blīves, skrūves, eļļas noliešanas skrūvi…), lai nodrošinātu pareizu transmisijas sistēmas darbību un izvairītos no eļļas noplūdes un priekšlaicīga nodiluma riska.
Lai nodrošinātu pareizu transmisijas sistēmas darbību un palielinātu tās kalpošanas laiku, ieteicams nomainīt automātiskās pārnesumkārbas filtru un eļļu vidēji ik pēc 60 000 kilometriem vai vismaz reizi 5 gados*
* Skatiet sava transportlīdzekļa ražotāja ieteikumus
NEPIECIEŠAMS PILNĪGAM PIEDĀVĀJUMAM
60% jauno automašīnu tagad ir aprīkotas ar automātiskajām ātrumkārbām
Vairāk nekā 35 komplekti, kas aptver galvenās tirgū pieejamās automašīnas
Pilnīgi komplekti pareizai apkopes veikšanai
OE piegādātāja eksperta garantija
www.purflux.com

Tehniskais atbalsts un detalizēta informācija – vehicleaftremarket.skf.com ® SKF is a registered trademark of the SKF Group. | © SKF Group 2021 SKF piedziņas ķēdes komplekts
Pārdomāti komplektu risinājumi
KONDICIONIERA SPIEDIENA DEVĒJI “NISSENS” INFORMĀCIJA
“Nissens” regulāri palielina produkcijas sortimentu neatkarīgajam rezerves daļu tirgum. Starp neseniem jaunumiem – 40 jaunas pozīcijas aukstuma aģenta spiediena devēju līnijā, kas aptver 160 oriģinālos artikulus. Kompānijas speciālisti stāsta, kāpēc ir svarīga šo devēju darbība un kāpēc to atteices gadījumā elektronika var neatļaut ieslēgt formāli darbderīgu kondicionētāju.
Kā norāda nosaukums, devējs pārveido spiediena rādītāju analogā elektriskā signālā. Aukstuma aģenta spiediena devēji konstrukcijas ziņā var būt dažādi, taču darbības princips ir aptuveni vienāds. Piemēram, shēmā ar 3 kontaktu devējiem ir 5 voltu bāzes vads, signāla vads un zemējuma vads. Elektronika salīdzina signāla vada sprieguma vērtību ar 5 voltu bāzes spriegumu un, pamatojoties uz to, aprēķina spiedienu sistēmā.
Zems spiediens
Zema spiediena devējs neļauj kompresoram ieslēgties, ja sistēmā nav aukstuma aģenta vai tā nav pietiekami daudz. Tā ir sava veida nodrošināšanās: aukstuma aģents caur sistēmu pārvada eļļu, kas ir kompresora smērviela. Ja aukstuma aģenta ir maz, tad nepietiek arī eļļas, un kompresors, darbojoties tādā režīmā, ātri iziet no ierindas. Spiediena devējs bieži vien iedarbojas, kad spiediens pretējā maģistrālē (no iztvaicētāja uz kompresoru) nokrītas zem 0,7 atmosfērām − dažādām automašīnām šis parametrs var atšķirties. Ja devēja atteices vai ķēdes pārrāvuma dēļ sistēma tikai neieslēdz kompresoru, tad tas nav sliktākais scenārijs: sliktāk ir tad, ja devējs darbojas nekorekti. Elektronika vai nu neļaus ieslēgt kompresoru pat ar pilnībā uzpildītu sistēmu, vai

Protams, ka klimata sistēmā bez spiediena devējiem ir arī citi devēji. Piemēram, kondicionētāja darbībai ir svarīgi, lai neapsaltu iztvaicētājs: to kontrolē temperatūras devējs. Ja šis devējs darbojas nekorekti, tad simptomi var būt dažādi: no kondicionētāja nepārtrauktas darbības ar pilnu jaudu līdz kompresora atslēgšanai. Mūsdienīgākiem automobiļiem sistēmā var būt vēl viens devējs, kas kontrolē dzesēšanas šķidruma temperatūru. Vecās konstrukcijas automašīnām šāda devēja var nebūt. Šis devējs dod komandu atslēgt kondicionētāju, ja antifrīza temperatūra pakāpjas virs 110−120 grādiem.
neatslēgs sistēmu spiediena trūkuma gadījumā, tādēļ kompresors darbosies nesaudzīgā režīmā.
Augsts spiediens
Augstspiediena devējs parasti neļauj ieslēgt kondicionētāju, ja spiediens spiedvada maģistrālē
(no kompresora uz termoregulējošo ventili vai iztvaicētāja cauruli) sasniedz 25 atmosfēras. Dažos automobiļos sistēma pieļauj īslaicīgu spiediena maksimumu līdz 30 atmosfērām. Ir daudz iemeslu, kāpēc spiediens var kļūt pārāk liels. Viens no šiem iemesliem ir savu laiku nokalpojis sausinātājs, kas vairs nespēj
Ražotāju informācija 88



Ja augstspiediena devējs neļauj ieslēgt kondicionētāju, tad tas nav sliktākais variants, sliktāk ir tad, ja šis devējs nedarbojas. Šajā gadījumā iespējams tāds nepatīkams un dažreiz pat biedējošs pārsteigums kā aukstuma aģenta avārijas izvade. Tas var izpausties šādi: blīkšķis no pārsega apakšas, pēc kura no turienes sāk izplūst tvaiks. Izvade parasti notiek caur speciālu vārstu (sk. attēlu). Gadās, ka arī šis vārsts neiedarbojas, tad spiediens var pārraut kādu maģistrāli vai kondicionētāja radiatoru (kondensoru).
uzsūkt mitrumu. Sistēmā esošais mitrums var sasalt un aizsprostot maģistrāli. Šajā gadījumā spiediens, protams, strauji pieaug. Vispār jau sausinātāju pēc noteikta laika ieteicams nomainīt, taču šis ieteikums diemžēl ne vienmēr tiek ievērots.
Vēl viens iespējamais iemesls ir dzinēja dzesēšanas ventilatora problēma. Kad ieslēdzas kondicionētājs, tad automātiski pirmajā ātrumā ieslēdzas arī ventilators – tas nepieciešams kondensorā ienākošā gāzveida aukstuma aģenta dzesēšanai. Kondensorā atdziestot aukstuma aģents pārvēršas šķidrā stāvoklī, proti − kondensējas (starp citu, tieši tāpēc šo radiatoru sauc par kondensoru). Ja kāda iemesla dēļ dzinēja dzesēšanas ventilators neieslēdzas, tad, visticamāk, sistēma neļaus ieslēgties arī kompresoram. Spiediens var paaugstināties arī nepareizas izplešanās caurules darbības dēļ: piemēram, tā vienkārši ir aizsērējusi ar nolietota kompresora skaidu daļiņām. Starp citu, vēl viens pārāk augsta spiediena iemesls ir gluži vienkārša pārmērīga uzpilde: sistēmā ir pārāk daudz aukstuma aģenta.
Kļūdu kodi un nomaiņa
Spiediena devēju atteices vai strāvas pazušanas gadījumā var iedegties “Check Engine”, turklāt diagnostikas skeneris var parādīt šādus kļūdu kodus:
● P0530 – Spiediena devēja ķēdes defekts;
● P0531 – Nepareizi devēja rādījumi/devējs nav noregulēts;
● P0532 – Devēja ķēdē zems ieejas signāla līmenis;
● P0533 – Devēja ķēdē augsts ieejas signāla līmenis.
Ja problēma ir pašā devējā, tad risinājums ir tikai viens: nomaiņa, turklāt svarīgi ir pareizi izvēlēties devēju atbilstoši tā tipam − strikti pēc kataloga. Lieta tāda, ka devējs var būt slēdzis vai rezistīvā ierīce. Gadās, ka viens un tas pats devējs kontrolē augstu un zemu spiedienu. Piemēram, kombinētais devējs-slēdzis var darboties saskaņā ar šādu algoritmu. Saņemot komandu ieslēgt kondicionētāju, devējs pārbauda: ja spiedvada maģistrālē ir 2 bāru spiediens, tad kompresora ieslēgšanas ķēde noslēdzas un ventilators ieslēdzas pirmajā ātrumā. Palielinot spiedienu līdz 15−17 bāriem, noslēdzas
Saistītie faktori

Klimata sistēmu apkopes speciālisti zina vienu ne pārāk izplatītu, nedaudz āķīgu, bet tajā pašā laikā diezgan tipisku situāciju: kondicionētājs dažreiz darbojas, bet dažreiz izslēdzas pats no sevis. Sistēma it kā ir kārtībā, sausinātājs – jauns, iztvaikotājs neapsalst. Kas par lietu – niķojas augstspiediena devējs? Ne vienmēr. Iemesls var būt pavisam kas cits: radiatora komplekts (dzinēja radiators un kondensors) ir aizsērējis ar netīrumiem. Dzesēšana ir nepietiekama, spiediens pieaug, un spiediena devējs izslēdz kompresoru. Problēmas risinājums var būt radiatora komplekta skalošana, ko, starp citu, ieteicams veikt regulāri − aptuveni reizi gadā.
ventilatora ieslēgšanas otrajā ātrumā ķēde. Sasniedzot iepriekš minēto kritisko 25−30 bāru spiedienu, kompresora ķēde atvienojas.
Mūsdienu automašīnās bieži tiek izmantoti nevis slēdži, bet gan rezistīvie devēji, kas vienmērīgi maina pretestību. Šādās sistēmās ventilatoram parasti nav fiksētu ātrumu: vadības elektronika tikpat vienmērīgi maina ventilatora apgriezienus. Vairumā gadījumu viena veida devēju nav iespējams aizstāt ar citu.
“Nissens” piedāvā pilnu komponentu spektru klimata sistēmām: kompresori, radiatori, ventilatori un daudz kas cits: sortimentā ir vairāk nekā 3600 pozīciju, tostarp 450 artikulu hibrīda modeļiem un elektromobiļiem. Sīkāka informācija par produkciju un izmantotajām tehnoloģijām un arī tiešsaistes katalogs ir pieejams resursā www.nissens.com.
Ražotāju informācija 89
HEPA SALONA FILTRI
UN BREMŽU FILTRI
“MANN-FILTER” IZSTRĀDES
Pirms kāda laika uzņēmums MANN+HUMMEL prezentēja salona filtrus, kas nosaka jaunus gaisa tīrības standartus automašīnas salonā, kā arī nodemonstrēja perspektīvu risinājumu būtiskai cieto daļiņu izmešu samazināšanai bremzējot.
Mēs esam pieraduši par tīru uzskatīt tādu gaisu, kurā nav redzama piesārņojuma, piemēram – putekļu. Tomēr putekļi nav pati briesmīgākā lieta: cilvēka organismā ir savas filtrācijas sistēmas. Šī sistēma veiksmīgi aiztur un izvada relatīvi lielas daļiņas. Bīstamākas ir sīkās daļiņas, turklāt – jo sīkākas tās ir, jo dziļāk iekļūst organismā, ir grūtāk izvadāmas un nodara lielāku kaitējumu. Piemēram, par 10 mikroniem mazākas daļiņas spēj iekļūt dziļi plaušās un tajās nogulsnēties. Vēl kaitīgākas ir daļiņas, kuru diametrs ir mazāks par 2,5 mikroniem, kas spēj pārvarēt aerohematisko barjeru un nonākt tieši asinsrites sistēmā.
Hroniska smalku cieto daļiņu iedarbība palielina sirds un asinsvadu, respiratoro un citu slimību attīstības risku. Saskaņā ar dažādu pētījumu rezultātiem, vairāk nekā 90% cilvēku uz planētas dzīvo vai regulāri uzturas vietās, kur gaisa tīrību nevar saukt par absolūti drošu veselībai. Saskaņā ar statistiku, vairāk nekā 4 milj. cilvēku gadā cieš no dažādām gaisa piesārņojuma izraisītām slimībām, un vienlaikus daudz lielāks cilvēku skaits izjūt netīrā gaisa tā sauktās slēptās sekas: tonusa pazemināšanos, palielinātu nogurumu utt.
Autovadītāji ir riska grupā, jo ceļš ir dažādu kaitīgo vielu koncentrācijas vieta: no riteņu paceltiem putekļiem līdz izplūdes gāzēm, kas satur ogļūdeņražu daļiņas un tiem radniecīgas vielas – aldehīdus, benzopirēnus, kvēpus utt. Īpaši bīstams ir CO – oglekļa monoksīds, bezkrāsaina, ārkārtīgi toksiska gāze bez garšas un smaržas, vieglāka par gaisu, kā arī slāpekļa oksīdi – neorganiski bināri slāpekļa savienojumi ar skābekli. Protams, ka tas viss tiecas iekļūt automašīnas salonā, bet vai iekļūs vai nē – tas ir atkarīgs no salona filtra.
Filtrācijas parametri
MANN-FILTER sortimentā jau ir vairāki risinājumi, kā gaisu salonā padarīt tīrāku un drošāku, un nesen tiem tika pievienots vēl viens. Tostarp jau diezgan sen ir zināmi līniju “FreciousPlus” un “FreciousPlus2” salona filtri. “FreciousPlus” filtrs spēj aizturēt 10 mikronu lielas daļiņas, kā arī atsijāt līdz 90% 2,5 mikronu izmēra daļiņas un 80% supermazas daļiņas 1 mikrona lielumā. Salīdzinājumam, 1 mikrons – tas ir apmēram 700 reižu mazāk nekā cilvēka mata diametrs. Šādu parametru nodrošināšanai tiek izmantots filtrējošs materiāls, kas sastāv no nanošķiedrām, kuras ir 100 reižu tievākas par tām, kas tiek izmantotas standarta filtrējošajos materiālos.

Uzlabotajam “FreciousPlus2” ir tādi paši filtrējošie parametri, taču izde vīguma ziņā atšķiras no sava priekš gājēja, ja runa ir par gāzu un smaku aizturēšanu. Ir uzlabota sēra dioksīda un ozona saistīšana, un slāpekļa oksīdu gadījumā var runāt par gandrīz pilnīgu atsijāšanu. Salīdzinot ar iepriekšējo modeli, “FreciousPlus2” spēj absorbēt vairāk nekā 200 reižu vairāk amonjaka. Šīs filtrs arī labāk pasargā no gaistošiem organiskiem savienojumiem, piemēram, formaldehīda, kas var izdalīties no autosalona materiāliem. “FreciousPlus2” turklāt ļoti augstā līmenī filtrē baktērijas, aiztur alergēnus un novērš pelējuma veidošanos.
Iepriekš minētās filtrēšanas iespējas izskatās iespaidīgi, tomēr tā nav galējā robeža: orientējoties uz jau tuvāko nākotni, MANN-FILTER prezentē salona filtrus, kas vēl efektīvāk aiztur supermazas daļiņas: 1 mikrona lielumā un mazākas.
HEPA
Abreviatūra HEPA nav zīmols, tas ir filtrācijas tehnoloģijas nosaukums, kas atšifrējams kā High Efficiency
Particle Absorption – augsti efektīva cieto daļiņu absorbcija. Pati par sevi tehnoloģija ir sen zināma: 1940. gados ASV HEPA filtri tika izmantoti radioaktīvo daļiņu uztveršanai kodolrūpniecības uzņēmumos. Tolaik tamlīdzīgi filtri bija ļoti sarežģīti
Ražotāju informācija 90

apkārtējā gaisa tīrība. Šādus filtrus dēvē par “absolū tas tīrības filtriem”.
HEPA salona filtri pagaidām vēl nav masveida parādība, taču “Tesla” elektromobiļos tādi jau tiek izmantoti. Šādi filtri paredzēti darbam intelektuālo daudzpakāpju filtrācijas sistēmu sastāvā.



Ražotāju informācija 91
Ražotāju informācija
HEPA salona filtri vēl nav masveidā izplatīti, bet jau ir sērijveida automašīnas ar šādiem filtriem: tāda ir “Tesla”. “YouTube” var atrast video, kurā parādītas šāda filtra iespējas. Vai parastam automobilim standarta salona filtru var nomainīt ar HEPA filtru? Diemžēl vairumam automašīnu pagaidām tas nav iespējams: klimatiskā sistēma nav paredzēta tik augstas efektivitātes filtra uzstādīšanai. HEPA filtra esamība konstrukcijā paredz, ka tas kopā ar priekštīrīšanas filtru atrodas atsevišķā sistēmā – parasti ārpus gaisa kondicionēšanas sistēmas.

Domājams, ka HEPA filtrs darbosies intelektuālo daudzpakāpju gaisa attīrīšanas sistēmu sastāvā. Sistēma analizē gaisa kvalitāti un, pamatojoties uz iegūtajiem datiem, izlemj, caur kādu filtru laist āra gaisu. Citiem vārdiem sakot, HEPA filtrs aktivizējas tikai tad, kad tas nepieciešams, piemēram – tuneļos, sastrēgumos un citās situācijās, kad apkārtējais gaiss ir stipri piesārņots. Šāds risinājums ļauj saglabāt samērā sistēmas kompakto lielumu un pagarina HEPA filtra kalpošanas laiku.
MANN+HUMMEL portfolio ir arī citas perspektīvas izstrādes, kas demonstrē principiāli citu filtrācijas līmeni, starp tām – bremžu filtrācijas sistēmas (sk. iesprau dumu), daudzpakāpju gaisa tīrīšanas sistēmas komerctrans portam un vēl daudz kas cits. Iespējams, ka daži risinājumi izskatās nedaudz futūristiski. Tomēr mūsdienās tehnoloģiju attīstības ātrums ir visai liels, un tāpēc pastāv uzskats, ka pavisam drīz daudzas no minētajām izstrādēm tiks masveidā izmantotas sērijveida automašīnās. Sīkāka informācija par MANN+HUMMEL sortimentu un tehnoloģijām pieejama resursā www.mann-filter.com.
Saskaņā ar Vācijas Apkārtējās vides aizsardzības aģentūras datiem, tikai Vācijā ik gadu veidojas aptuveni 8000 tonnu bremžu putekļu. Pēc provizoriskām analīzēm tādās valstīs kā Anglija vai Francija skaitļu secība būs līdzīga, Amerikā ciparu droši var reizināt ar vismaz trīs, bet, piemēram, Ķīnā – ar pieci. Ja apkopotu visu valstu datus, tad sanāktu, ka visā pasaulē gadā veidojas vismaz 100 000 tonnu bremžu putekļu, un mēs to visu elpojam. Vai situāciju ir iespējams kaut kā uzlabot? Jā, un uz to ir vērsta viena no perspektīvākajām MANN+HUMMEL izstrādēm – bremžu putekļu filtrs ar neaustām metāla šķiedrām.
Ierīces uzdevums – uztvert putekļus no bremžu klučiem. Filtrs tiek uzstādīts tieši uz suporta, ir piemērots jebkurai esošai montāžas telpai un var tikt pielāgots dažādiem bremžu izmēriem un koncepcijām. Uzņēmuma portfolio ir arī bremžu sistēmas putekļu filtra aktīvā versija: sistēma savāc putekļus no katra riteņa klučiem un transportē tos uz centrālo rezervuāru, izmantojot vakuuma sūkni. Tamlīdzīgi risinājumi ļauj samazināt cieto daļiņu emisijas bremzēšanas laikā ja ne līdz nullei, tad līdz visai nenozīmīgām vērtībām. Kā bonuss ir tas, ka diski vienmēr paliek tīri. Ņemot vērā arvien stingrākas ekoloģiskās prasības, tiek uzskatīts, ka tuvākajā nākotnē šādas ierīces parādīsies sērijveida automašīnās.

Starp citu, bremžu putekļu filtri izstrādāti sadarbībā ar “Hitachi Astemo” –jaunu globālo spēlētāju neatkarīgajā rezerves daļu tirgū.
 Bremžu mehānismu filtri
Bremžu mehānismu filtri
92








UZLABOTAS EĻĻAS
HIBRĪDAUTOMOBIĻIEM
Iekšdedzes dzinēju darbības specifika hibrīdsistēmās nosaka ārkārtīgi augstas prasības izmantojamajām eļļām. “TotalEnergies” skaidro, kādēļ attiecībā uz smērvielām ir svarīgi
ievērot hibrīdautomobiļu ražotāju ieteikumus.


Vēlreiz jāatgādina, ka esam konstatējuši acīmredzamu intereses pieaugumu par hibrīdautomobiļiem. Gan autosalonos, gan otrreizējā tirgū ar šādu piedziņu aprīkotu automobiļu pārdošanas apjomi palielinās. Pircēji augstu novērtē zemo degvielas patēriņu pilsētas ciklā, taču ne tikai to. Hibrīdautomobiļi tiek uzskatīti arī par uzticamiem un tādiem, kuriem tikpat kā nav nepieciešama apkope. “TotalEnergies” mums atgādina, ka šādiem automobiļiem ārkārtīgi svarīga ir motoreļļas kvalitāte. Iekšdedzes dzinēja darbības specifika nozīmē, ka eļļai tiek noteiktas ārkārtīgi augstas prasības – faktiski tikpat augstas kā motoru sportā automobiļu dzinējiem. Svarīgi atzīmēt, ka, jo modernāks ir hibrīds, jo augstākas ir prasības.
Hibrīda ABC
Hibrīdautomobilī ir iebūvēts viens no diviem atšķirīgiem piedziņas motoriem. Moderno automobiļu gadījumā tas ir iekšdedzes dzinēja (parasti benzīna) un elektromotora apvienojums ar mazāku vai lielāku enerģijas krātuvi. Vislētāko vieglo hibrīdu gadījumā iekšdedzes dzinējs darbojas nepārtraukti, bet mazjaudas elektriskais nodalījums ar mikroskopisku akumulatoru tiek izmantots tikai enerģijas rekuperācijai bremzēšanas laikā un lai pastiprinātu dzinēja darbību paātrinoties. Ar vides aizsardzību saistītu apstākļu dēļ visi šobrīd pārdotie jaunie automobiļi ir mikrohibrīdi. Šāda sistēma padara iespējamu, piemēram, dzinēja izslēgšanu, gaidot pie luksofora, un tai sekojošu vienmērīgu ieslēgšanu, nospiežot gāzes pedāli. Mikrohibrīda galvenā priekšrocība, salīdzinot ar standarta automobili, ir mazāks izmešu daudzums pilsētas ciklā. Pilnīgos hibrīdautomobiļos elektromotora jauda un tā akumulators ļauj braukt tikai elektriskā režīmā, bet vilces akumulatora ierobežotās jaudas dēļ tas attiecas tikai uz novietošanas manevriem stāvvietā, braukšanu sastrēgumos un iekšdedzes dzinēja


darbības veicināšanu paātrinājuma laikā. Dārgākajos hibrīdautomobiļu modeļos (“plug-in” tipa) elektriskā piedziņa ļauj jums veikt bezizmešu režīmā līdz pat vairākiem desmitiem kilometru – gluži kā ar elektromobili. Vilces akumulatori, tāpat kā lētākajos hibrīdos, tiek uzlādēti, bet tos var uzlādēt arī no ārējā avota.
Eļļas izaicinājums
Iespējams, ka pēc šī ievada izlasīšanas daži lasītāji varētu nojaust, kas ir hibrīdautomobiļu lielākais eļļas izaicinājums. Protams, tas attiecas uz ļoti biežu iekšdedzes dzinēja iedarbināšanu un izslēgšanu – gadījumos ar visu veidu hibrīdiem – un iekšdedzes dzinēja darbību zemas temperatūras diapazonā. Iekšdedzes dzinējs pietiekami neuzsilst, jo parasto īso darba ciklu laikā tam parasti nepietiek laika, lai sasniegtu optimālo darba temperatūru. Pilnīgos hibrīdautomobiļos un, vēl vairāk, “plug-in” hibrīdos ir arī problēma, kas saistīta ar pēkšņu apgriezienu palielināšanos pilnībā aukstam dzinējam. Tā notiek situācijā,
informācija 94
Ražotāju

VAIRĀK

kad automobilis no stāvvietas izbrauc elektriskā režīmā, iekļaujas satiksmes plūsmā un “sāk darbību”, pārvietojoties ar 50–60 km/h. Jāatceras, ka daži dzinēji hibrīdos ir ar turbopūti, tomēr pēkšņa šāda motora izslēgšana, kas darbojies ar 3–4 tūkstošiem apgr./min, ievērojami noslogo turbīnas gultņus.
Eļļas hibrīdautomobiļiem
Eļļas ražotāji izmanto tehnoloģiski vismodernākos risinājumus, lai šādos nelabvēlīgos apstākļos nodrošinātu optimālu eļļošanu. Lai līdz minimumam samazinātu laiku, kas nepieciešams, lai auksta eļļa izplatītos cauri eļļas kanāliem, nepieciešama attiecīgi zema viskozitāte un augsta plūstamība. Tikai tādā gadījumā tiek līdz minimumam samazināts bloka “sausais” darba periods. Tas ir galvenais iemesls, kādēļ 0W-20 viskozitāte šādiem dzinējiem ir standarts un dažiem modeļiem pat nepieciešama eļļa ar 0W-8 viskozitāti. Hibrīdeļļām jābūt arī attiecīgām pretnodiluma piedevām, kas būs aktīvas arī relatīvi zemākā eļļas darba temperatūrā. Galu galā parastā darba ciklā daļa nesadegušo degvielu saturošo ekoloģisko piedevu nokļūst eļļā. Eļļai jābūt ar tām saderīgai un
noturīgai pret paaugstinātu oksidāciju vai želēšanu. “TotalEnergies” eļļu piemēri, kas atbilst iekšdedzes dzinēju prasībām hibrīdpiedziņās: Quartz 9000 XTRA 0W-8; Quartz 9000 XTRA FUTURE XT 0W-16, Quartz Ineo XTRA EC6 0W-20, Quartz 9000 FUTURE GF-6 0W-20 un Quartz Ineo XTRA DYNAMICS 0W-20 utt.
Kā redzat, eļļas izvēle hibrīdautomobilim ir ārkārtīgi svarīga, un pat pēc garantijas perioda beigām ir stingri jāievēro dzinēja ražotāja ieteikumi. Iespējams, daudzi hibrīdu lietotāji tagad ir pārsteigti, jo mūsu tirgū pieejamajiem vispopulārākajiem hibrīdiem zem pārsega ir viegli ekspluatējami benzīna motori bez turbopūtes, kas pirmajā acu uzmetienā šķiet “mazprasīgi”. Tomēr, pateicoties to darbības specifikai, atbilstošas piemērotas klases eļļas izmantošana saskaņā ar ražotāja ieteikumiem ir ļoti svarīga. Dažreiz ir arī labi uz ceļa “uzsildīt” iekšdedzes dzinēju, lai iztvaikotu šādos nelabvēlīgos darba apstākļos sakrātā kondensāta degvielas vai ūdens nogulsnes.
Adams Husiatinskis (Adam Husiatyński), “TotalEnergies” Tehniskais departaments
par hibrīda piedziņām un “TotalEnergies” eļļām varat uzzināt, noskatoties mūsu video. Tēmas svarīguma dēļ hibrīdiem ir veltītas veselas trīs sērijas. Tajās visās jūs sastapsieties ar mūsu sūtņiem – Patriku Mikičuku (Patryk Mikiciuk) un Adamu Klimeku (Adam Klimek)



Ražotāju informācija 95
NĀKOTNES UN TAGADNES MOBILITĀTE “SCHAEFFLER GROUP” INOVĀCIJAS
Sekojot mūsdienu tendencēm, “Schaeffler Group” aktīvi attīsta elektromobiļu un hibrīdu virzienu. Starp neseniem jaunumiem ir vairāki interesanti risinājumi, kuru uzdevums ir pagarināt elektromobiļa nobraukuma rezervi. Interesanti, ka runa it nemaz nav par akumulatoriem.

Kā palielināt elektromobiļa nobraukumu ar vienu uzlādi, nepalielinot baterijas kapacitāti? Atbilde ir acīmredzama: ekonomiskāk patērēt enerģiju. Autovadītāji bieži vien taupa uz komforta rēķina, piemēram – neieslēdz klimata iekārtu, spoguļu apsildi utt. “Schaeffler” inženieri piedāvā ekonomēt citādi – nekaitējot komfortam, izmantojot augstākas tehnoloģijas mezglus.
Gultņi
Berzes zudumi ir neizbēgama parādība jebkurā transportlīdzeklī. Attiecīgi berzes zudumu samazināšana – piemēram, gultņos – ir reāls ietaupījums. Viens no “Schaeffler” risinājumiem ir

augstas efektivi tātes transmisijas gultņi, kas ļauj ietaupīt aptuveni 50 W enerģijas, salīdzinot ar tradicionālajiem gultņiem. Minētie 50 W – tas ir aptuveni tik, cik daudz vidēja elektromobiļa akumulatora uzlādes tiek tērēts stūres vai spoguļu apsildei. “Schaeffler EV” transmisijas gultņi ir speciāli adaptēti lieliem elektrotransmisijas ieejas vārpstu griešanās ātrumiem, tiem ir liels resurss, un tie nodrošina optimālu slodzes sadalījumu.

“Schaeffler TriFinity” trīsrindu rumbu gultņi līdz 67 % samazina berzes zudumus, iztur par 20 % lielāku slodzi un vienlaikus sver par 10 % mazāk nekā tradicionālie divrindu gultņi.
Vēl viens risinājums no šīs sfēras –energoefektīvi “TriFinity” rumbu gultņi, kas samazina berzes zudumus līdz pat 67 %, salīdzinot ar parastajiem gultņiem. Tas nozīmē vairāk nekā 200 W ekonomiju, kas atbilst aptuveni 20 kilometriem nobraukuma rezerves krosoveram ar pilnībā uzlādētu 120 kWh kapacitātes akumulatoru. Aukstā laikā šos papildu 200 W alternatīvi var izmantot vadītāja un pasažiera sēdekļu apsildei, nezaudējot nobraukuma rezervi.
Ražotāju informācija 96

“TriFinity” trīsrindu rumbu gultnis sver aptuveni par 10 % mazāk nekā standarta tāda paša izmēra divrindu gultnis. Vienlaikus trīsrindu gultnim kravnesība ir par 20 % lielāka, kas ļauj izturēt lielākas ass slodzes vai demonstrēt lielāku resursu, ja pārējie apstākļi ir līdzīgi.
Termoregulēšana
Temperatūras režīma vadīšana pa ver lielas iespējas nobraukuma rezer ves palielināšanai: šī ir joma, kurā “Schaeffler” strādā jau apmēram 15 gadus. Kopš 2011. gada OEM ražotājiem “Schaeffler” piegādā temperatūras režīma vadīšanas risinājumus. Viens no jaunumiem šajā virzienā – elektriskā ass “4 in 1”. Izplatītā elektriskās ass moduļa konstrukcija paredz trīs komponentu kombināciju: elektrodzinēja, transmisijas un spēka elektronikas. “Schaeffler” inženieri šo
Jaunais pētniecības centrs
“Schaeffler” nepārtraukti paplašina savu globālo darbību progresīvu mobilo risinājumu izstrādē. Tā ietvaros uzņēmums atvēra jaunu izstrādes centru Kisucē Slovākijā. Centra specializācija ir produkti un komponenti elektromobiļiem un hibrīdiem, kā arī šasiju sistēmas automašīnām, kas aprīkotas ar automātiskām vadīšanas sistēmām. Būvdarbi sākās 2021. gadā, tika investēti aptuveni 20 milj. eiro. Četru līmeņu izmēģinājumu centrs aizņem ap 8000 kvadrātmetru – aptuveni futbola laukuma platību. Puse platības atvēlēta tieši projektu izstrādes nodaļām, vēl puse – laboratorijām un stenda izmēģinājumu telpām. Pirmie darbinieki centrā sāka strādāt 2023. gadā, bet līdz 2025. gadam darbam pie nākotnes mobilitātes “Schaeffler” plāno piesaistīt vēl 500 speciālistu.

komplektu ir papildinājuši ar ceturto komponentu – termoregulēšanas sistēmu.
Augsti integrētai kompleksai sistēmai ir nepieciešams ievērojami mazāk vietas nekā neintegrētiem risinājumiem. Turklāt mazāk enerģijas tiek patērēts kā siltums, jo var atteikties no nevajadzīgām šļūtenēm un kabeļiem. “4 in 1” sistēmas galvenā priekšrocība ir optimizēta atsevišķu apakšsistēmu mijiedarbība. Vienkāršāk sakot, lieko siltumu no elektrodzinēja un spēka elektronikas var izmantot salona vai akumulatora apsildei – gan viens, gan
rezerves palielināšanos. Starp citu, aukstā laikā iesildīts akumulators arī ātrāk uzlādējas. Papildu priekšrocības efektivitātes un ekoloģiskuma uzlabošanas jomā tiek panāktas, izmantojot jauno siltumsūkni, kas darbojas ar dabīgu aukstuma aģentu – ogļskābo gāzi.
Iepriekš aprakstītie un daudzi citi risinājumi tika nodemonstrēti 2023. gada beigās izstādē “IAA Mobility”, kur izraisīja gan autoīpašnieku, gan arī autokoncernu pārstāvju interesi. Sīkāka informācija par “Schaeffler Group” inovācijām un izstrādēm pieejama resursā www.schaeffler.com

Elektriskās ass modulī “4 – 1” automobiļa termoregulēšanas sistēma, kas tradicionāli tiek uzskatīta par atsevišķu komponentu, apvienota ar piedziņas komponentiem: elektrodzinēju, transmisiju un spēka elektroniku. Tas novērš nepieciešamību izmantot papildu šļūtenes un kabeļus, tādējādi samazinot enerģijas zudumus.
Ražotāju informācija 97
MELNIE BREMŽU DISKI TRW INFORMĀCIJA
No plašā bremžu disku sortimenta, ko ZF TRW piedāvā neatkarīgajā rezerves daļu tirgū, pēdējā laikā ļoti pieprasīti ir melnie diski. Kāpēc šie diski ir melnie?
Melnais pārklājums katrā ziņā piešķir diskiem spilgtu ārējo izskatu, taču tas nav galvenais iemesls. Diski ir pārklāti ar īpašu melnu krāsu, radot izturīgu aizsargbarjeru pret koroziju. Vēl viena odziņa – melnie diski ir iepakoti pretkorozijas VCI papīrā, kas novērš mitruma iekļūšanu. Tas nozīmē, ka pirms iepakošanas diskus nevajag pārklāt ar smērvielu vai korozijas inhibitoru, savukārt pirms uzstādīšanas nav jātērē laiks šī sastāva nomazgāšanai. Diskus vienkārši izņem no kastes un uzstāda.
Tāpat kā pārējie ZF TRW bremžu diski, melnie diski tiek izgatavoti no kvalitatīva augstoglekļa čuguna, atbilstot pielaidēm GG20 / G15HC. Uzņēmums ZF TRW ir viens no nedaudziem, kas patstāvīgi izstrādā OEM ražotāju apstiprinātu bremžu disku testēšanas aprīkojumu un programmatūru. Izstrādājumi tiek izmēģināti ne tikai laboratorijās, bet arī reālos gaitizmēģinājumos, tostarp uz kalnu ceļiem. Melnie diski demonstrē augstu izturību pret deformācijām. Testa rezultāti liecina, ka pat pēc ilgstošām un asām bremzēšanas sērijām nogāzēs mešanās nepārsniedz 30 mkm, bet diska biezuma izmaiņas (DTV) − 12 mkm (0,012 mm).
Starp citu, par DTV (Disc Thickness Variation): kāpēc šis parametrs bieži tiek minēts disku un kluču piestrādes kontekstā un kāpēc tas ir svarīgs? Situācija: uzstādīti jauni, it kā kvalitatīvi diski un kluči, sākumā viss ir labi, bet pēc kāda laika autoīpašnieks sūdzas, ka bremzējot
parādījusies mešanās. Kāds ir iemesls? Visticamāk, ka diski un kluči nebija pienācīgi piestrādāti. Pirmajos 200−300 km nav ieteicams strauji bremzēt un pieļaut ABS iedarbošanos. Lieta tāda, ka bremzējot kluču materiāls ne tikai nodilst, bet zināmā mērā tiek pārnests arī uz disku virsmu.
Sasniedzot noteiktu temperatūras robežu vai intensīvi izmantojot nepiestrādātus klučus un diskus, materiāls tiek uzklāts nevienmērīgi. Tur, kur materiāla ticis vairāk, disks kļūst nedaudz biezāks. Rodas paaugstinātas berzes laukumi, un arī temperatūra tur,


Melnais pārklājums piešķir ne tikai pievilcīgu ārējo izskatu: tā galvenais uzdevums ir aizsardzība pret koroziju. Papildus tam melnie diski ir iepakoti īpašā pretkorozijas papīrā.
protams, ir augstāka. Sasniedzot 650 °C, notiek šo laukumu cementācija: tie kļūst cietāki. Rezultātā nevienmērīgs diska biezums arī kļūst par mešanās cēloni. Diska biezuma nevienmērīgumu var noteikt diezgan vienkārši: jāizmēra astoņās vietās – proti, ik pēc 45 grādiem, tāpat 10 mm attālumā no diska malas. Tad no lielākās vērtības tiek atņemta mazākā vērtība. Vairumā gadījumu DTV robeža ir lielums 0,015 mm (15 mkm). Ja starpība ir lielāka – disks ir jānomaina.
TRW melnie bremžu diski tiek piegādāti gan atsevišķi, gan arī komplektos – tostarp ar rumbām un gultņiem, kur iekļauti nepieciešamie stiprinājumi. Sīkāka informācija par ZF TRW produkciju pieejama resursā www.trwaftermarket.com, savukārt “ZF Group” “YouTube” kanālā video sērijā “Noderīgi zināt” var smelties daudz noderīgas informācijas par bremžu sistēmas apkopi.
Ražotāju informācija 98

AMORTIZATORI SAJŪGI un


VIEGLAJIEM AUTO Sachs
Pārbaudīts darbībā Radīts, lai kalpotu ilgi
Izcila OE kvalitāte. Optimāla uzticamība. Ilgs kalpošanas laiks. SACHS amortizatori un sajūgi vieglajām automašīnām. Labāk darbnīcai un labāk klientiem. Izvēlieties izcilību katrā detaļā. Uzziniet vairāk vietnē a f ter mar ke t . z f.c om /s ac h s /pr oduc t s
MILD
GSM SIKSNAS SPRIEGOJUMA PĀRBAUDEI
“CONTINENTAL” JAUNUMI
48 voltu MHEV hibrīdi kļūst arvien izplatītāki. Saskaņā ar ACEA asociācijas datiem, jaunu automobiļu tirgū šie modeļi pārdošanas apjomu ziņā šobrīd jau ieņem otro vietu pēc parastajām benzīna automašīnām. Attiecīgi, arvien biežāk MHEV apkope tiek veikta neatkarīgos autoservisos. Reaģējot uz pēcpārdošanas apkopes tirgus pieprasījumu, koncerns “Continental” nepārtraukti paplašina siksnas piedziņas komponentu sortimentu šiem modeļiem. Lūk, daži piemēri.

var griezties uz abām pusēm. Turklāt slodze uz siksnu ir ievērojami augstāka nekā tradicionālajā shēmā. Minētajā 6PK1822 komplektā iekļauts tieši rievsiksnas pārvads, spriegošanas un apvades rullīši, kā arī nepieciešamie stiprinājumi (skrūves utt.). Vēl viens jaunums – komplekts 6PK1179 EXTRA
K1 “Ford” modeļiem ar 1,0 litru dzinēju “EcoBoost MHEV”. Uz Eiropas ceļiem ir aptuveni 270 000 šādu automobiļu.

Komplekts 6PK1179 EXTRA K1
rievsiksnas pārvada nomaiņai 1,0 litru “Ford” “EcoBoost MHEV” dzinējā.
Piedāvājumi “Renault”, “Dacia” un “Ford”
Starp nesenajiem jaunumiem ir rievsiksnas pārvada komplekts
6PK1822 EXTRA K1 hibrīdiem MHEV “Renault”/”Dacia”, kas der aptuveni
500 000 automobiļiem visā Eiropā. Vārds EXTRA nosaukumā nav tāpat vien: MHEV konstrukcija siksnām izvirza īpašas prasības. Kā zināms, viena no galvenajām 48 voltu hibrīda iekārtas atšķirībām ir tāda, ka siksna
GSM komplekti
VW dīzeļdzinējiem
Mēs visi labi zinām dzinēju sēriju VW EA 288: šie kopš 2012. gada ražotie turbodīzeļi pašlaik darbojas zem ļoti daudzu “VW Group” modeļu pārsegiem. Līnijā ietilpst 1,4 l 3 cilindru motori, kā arī 1,6 un 2,0 l tilpu ma dzinēji. Pēc moderni zācijas dzinēju sēriju no dēvēja par EA288 evo. Viena no atjaunināto
Komplekts
6PK1120 EXTRA
GSM siksnas nomaiņai
2,0 TDI “Mild Hybrid” dzinējā.
motoru galvenajām atšķirībām – kopš 2019. gada tie ir sagatavoti MHEV tehnoloģiju izmantošanai. EA288 evo dzinējus var uzstādīt gan parastiem dīzeļdzinēju modeļiem, gan arī 48 voltu hibrīdiem. Tādējādi GSM siksnas maiņas komplektu sortiments VW ar šādiem motoriem ir diezgan plašs, un tajā ir iekļauti šādi piedāvājumi.


HIBRĪDU SIKSNAS UN VIEDTĀLRUNIS
Ražotāju informācija 100



















EA288 evo bez MHEV tehnoloģijas:
- 6PK1033;
- 6PK1033K1;
- VD1076.
EA288 evo ar MHEV tehnoloģiju:
- 6PK1120 EXTRA;
- 6PK1120 EXTRA K1.
EA288 evo ar MHEV tehnoloģijas un bez tās:
- CT1218;
- CT1229;
- CT1229K1;
- CT1229K2PRO;
- CT1229WP1;
- CT1229WP2PRO;
- WP6140;
- WPS7015.
Ne tikai hibrīdi
Aktīvi attīstot zemsprieguma un augstsprieguma hibrīdu virzienu, “Continental” neaizmirst arī par automobiļiem ar tradicionālajiem dzinējiem. No šī segmenta jaunumiem ir
vērts atzīmēt GSM siksnu komplektus ar artikuliem CT1237K2PRO un CT1230 WP1. CT1237K2PRO komplekts paredzēts 1,6 litru CRDI dzinējiem ar turbopūti, ar ko tiek komplektēti daudzi “Hyundai”/”Kia” modeļi. Eiropā ir aptuveni miljons automašīnu ar šādiem dzinējiem. Komplektā ietilpst ne tikai GSM siksna ar rullīšiem un stiprinājumu, bet arī eļļas sūkņa siksna – šo siksnu ieteicams mainīt kopā ar GSM siksnu.
Otrais jaunums ir CT1230 WP1: GSM siksnas komplekts ar ūdens sūkni – paredzēts PSA 1,5 Hdi dzinējam. Kopš 2017. gada, proti – kopš “Opel” pievienojās PSA koncernam, ar šo dzinēju tiek aprīkoti arī vācu zīmola modeļi. Kopumā Eiropā šobrīd ir aptuveni 2,6 miljoni automašīnu ar šādu dzinēju.
Protams, šie ne tuvu nav visi jaunumi: “Continental” sortiments regulāri paplašinās – turklāt ne tikai siksnas piedziņas komponentu jomā.
Sīkāka informācija par jaunajiem produktiem pieejama www.continental-engineparts.com


GSM siksnas spriegojuma pārbaude, izmantojot viedtālruni
Tas nav nekāds joks: pirms kāda laika “App Store” un “Play Store” kļuva pieejama bezmaksas lietotne “ContiDrive Europe”, kas patiešām ļauj novērtēt siksnas spriegojumu. Procedūra tiek veikta ar izslēgtu dzinēju, un tās būtība ir vienkārša: siksna jāparauj ar pirkstu, siksna izdos skaņu, ko uztvers viedtālruņa mikrofons, un lietotne novērtēs šīs skaņas frekvenci. Protams, jānorāda automobiļa dati un dzinēja modelis. Lai iegūtu precīzākus mērījumus, procedūru var atkārtot vairākas reizes. “Continental Aftermarket” “YouTube” kanālā videoklipā parādīts, kā tiek veikts šāds mērījums, saite uz šo video ir pieejama jau minētajā resursā www.continental-engineparts.com. Protams, siksnas spriegojuma mērīšana pēc vibrācijas skaņas diez vai jāuzskata par patiesību pēdējā instancē, tomēr šāda procedūra bieži vien palīdzēs izdarīt provizoriskus secinājumus par siksnas piedziņas stāvokli.
Ražotāju informācija 102
CT1230 WP1 – GSM siksnas komplekts ar ūdens sūkni PSA 1,5 Hdi dzinējam. Kopš 2017. gada šis dzinējs tiek uzstādīts dažiem “Opel” modeļiem, jo kopš tā brīža “Opel” kļuva par daļu no PSA.

EKOLOĢISKĀS BREMZES
ATE INFORMĀCIJA
“Continental” grupā ietilpstošais zīmols ATE regulāri paplašina bremžu sistēmas sortimentu, turklāt ņemot vērā pašreizējās ekoloģiskās tendences un elektromobiļu un hibrīdu segmenta izaugsmi. Produkcija ekoloģiskajā segmentā tiek piedāvāta ar abiem zīmoliem.
Uzskatāms
Par vienu no ieguldījumiem bremzēšanas ekoloģiskumā var uzskatīt keramiskos klučus, kurus ATE ražo jau vairāk nekā 10 gadus. Šie izstrādājumi jau sen ir ieguvuši labu reputāciju vairāku to priekšrocību dēļ. Pirmkārt, klučiem bija ilgāks kalpošanas laiks: tie gan paši lēnām nodilst, gan saudzīgāk izturējās pret diskiem. Otra svarīga priekšrocība – zems putekļu līmenis: tas ir labi gan ekoloģijai, gan arī gandrīz nesasmērējas riteņu diski. ATE “Ceramic” kluči ir ieguvuši daudzas balvas – tostarp balvu par inovācijām REIFEN izstādē Esenē, tie iekļauti ekoloģisko produktu “Zaļajā katalogā” izstādē “Automechanika” u.c. Pirms pāris gadiem ATE “Ceramic” kluči ieņēma pirmo vietu ADAC bremžu testā sacensībās ar pieciem citiem zīmoliem, ieskaitot vienu oriģinālu produktu. Keramisko kluču sortiments aizvien paplašinās, un šobrīd tie tiek piedāvāti plašam modeļu spektram.
Ņemot vērā perspektīvo standartu “Euro 7”, kas tostarp nosaka cieto daļiņu emisijas normu bremzējot, “Continental” piedāvā trumuļu bremzes VW I.D. saimes elektromobiļiem, kā arī citu ražotāju elektriskajiem
ATE keramisko kluču darba rezultāts. Testa braucieni tika veikti ar parastu automašīnu – vispirms ar tradi cionālajiem, bet pēc tam ar keramiskajiem klučiem. Izmēģinājumu garums – ap 2000 km pa pilsētu un maģistrāli, braukšanas režīms – diezgan aktīvs. Pēc disku tīrības pakāpes ar neap bruņotu aci redzams, cik daudz mazāk putekļu rada keramiskie kluči.



modeļiem. Tā nav drukas kļūda: VW I.D. aizmugurē patiešām ir trumuļu bremžu mehānismi (priekšējās ir disku bremzes). Vēl nesen uzskatīja, ka trumuļu bremzes ir tikai vecām
automašīnām un šim virzienam perspektīvu gandrīz nav, tad kāpēc gan tās atkal sāka izmantot ultramodernos elektromobiļos? Iemesli ir vairāki. Pirmkārt, rekuperācijas sistēmas
Ražotāju informācija 104

esamība nozīmē, ka bremzes tiek izmantotas mazāk – īpaši aizmugurējās, jo galvenā slodze gulstas uz priekšējiem bremžu mehānismiem. Retāka lietošana palielina korozijas tieksmi, savukārt trumuļu mehānismi slēgtās konstrukcijas dēļ šajā ziņā nav tik kaprīzi. Otrs un svarīgākais iemesls ir tas, ka trumuļu bremzēm ir mazāka cieto daļiņu emisija: putekļi no kluču noberšanās paliek mehānisma iekšpusē un no turienes tiek likvidēti plānotās servisa apkopes laikā.
Viena no perspektīvām izstrādēm ir tā dēvētais “zaļais suports”, kas tiek prezentēts ar “Continental” zīmolu,
Ražotāju informācija

Jaunais un vieglais “Green Caliper” suports nodrošina augstu bremzēšanas efektivitāti ar mazāku svaru (mīnus 15–20%) un tajā pašā laikā ievērojami samazina atlikušo bremzēšanas momentu – vienkāršāk sakot, kluči no diska attālinās ātrāk un lielākā attālumā.
un jauns “zaļais” bremžu šķidrums ar ATE zīmolu – jaunuma prezentācija paredzēta izstādē “Automechanika 2024”, kas rudens sākumā notiks Frankfurtē. Zaļo suportu (“Green Caliper”) var uzskatīt par vienu no elektromobiļu nobraukuma rezerves palielināšanas elementiem. Tas viss saistīts ar svara samazināšanu: konstrukcija ļauj ietaupīt līdz diviem kilogramiem svara uz katru bremžu suportu un vēl arī līdz trīs kilogramiem uz katru bremžu disku. Neskatoties uz atvieglošanu un izmēru samazināšanu, palēnināšanas efektivitāte ir tikpat laba kā tradicionālās konstrukcijas bremžu mehānismiem.
“Green Caliper” var izmantot arī parastajās automašīnās, taču tas tika izstrādāts vispirms jau elektromobiļiem. Ja palēninājums ir aptuveni līdz 0,3 g – komfortablas bremzēšanas diapazonā – elektromobilim parastās bremzes praktiski nav vajadzīgas. Uz
to pamatojoties, arī tika projektēta konstrukcija: pats suports ir no čuguna, maksimāli kompakts, kluči – gabarītu ziņā mazāki, taču biezāki. Tā kā suports ir mazāks – var uzstādīt lielāka diametra un turklāt plānāku bremžu disku – tā arī tiek panākta svara samazināšana. Turklāt, lai samazinātu kinētiskās enerģijas zudumus, zaļais suports pēc katras bremzēšanas nodrošina aktīvu bremžu kluču ievilkšanu. Tas samazina atlikušo bremzēšanas momentu starp klučiem un disku līdz līmenim zem 0,2 Nm, kas nozīmē darbību gandrīz bez zudumiem. Vēl viena inovācija konstrukcijā garantē, ka gaisa sprauga starp kluci un disku būs lielāka, un tā ir vienmērīgi sadalīta bremžu abās pusēs – tas nodrošina labāku dzesēšanu, kas nozīmē mazāku deformācijas risku un lielāku resursu.
Sīkāka informācija par ATE un “Continental” zīmolu jaunumiem ir pieejama resursā www.ate-info.de un www.continental-aftermarket.com
105
VW AMORTIZATORI UN EKOLOĢISKĀ EĻĻA KYB JAUNĀKĀS ZIŅAS
Starp neskaitāmiem KYB sasniegumiem izceļas divi notikumi. Pirmais – “KYB DCC
Pro” amortizatori ar elektronisku vadību, ko “Volkswagen Group” pieņēmusi jauno “Tiguan”, “Passat Variant” un citu modeļu, kā arī “Škoda Superb” un “Kodiaq” aprīkošanai. Turklāt KYB inženieri izstrādājuši revolucionāru, ekoloģiski tīru hidraulisko šķidrumu amortizatoriem.

“VW Group” automašīnās amortizatoru sistēma ar elektronisko vadību tiek saukta gandrīz tāpat kā oriģinālā: “DCC Dynamics
Chassis Control”. Sistēma adaptējas ceļa apstākļiem un arī
nodrošina iespēju izvēlēties režīmu: “Eco”, “Comfort”, “Sport” utt.
nepārtraukti automātiski tiek regulēti, paceļot automobiļa komfortu un vadāmību pilnīgi jaunā līmenī.
Dynamics Chassis Control
DCC (“Dynamics Chassis Control”) Pro sistēmās tiek izmantoti divvārstu amortizatori neatkarīgai stiepes un kompresijas svārstību vadīšanai. Amortizatori reaģē uz ceļa apstākļiem un braukšanas režīmu, bet elektronika aktivizē attiecīgos solenoīdus. Reakcijas laiks ir dažas milisekundes. Slāpēšanas raksturlielumi
Daudzi izmēģinātāji, kuri testēja sistēmu, teica, ka ar “DCC Pro” rodas tāda sajūta, it kā automašīna nebrauc, bet peld virs ceļa – triecieni, braucot pāri nelīdzenumiem, gandrīz netiek pārnesti uz salonu, vienlaikus automašīna saglabā augstu kursa stabilitāti un precīzi reaģē uz stūres darbībām. Turklāt sistēma ļauj regulēt iekšējo spiedienu amortizatoros, izvēloties iestatījumus atbilstoši vadītāja vēlmēm: no komfortabla līdz skarbam sporta režīmam. VW Group modeļi ar jauno KYB sistēmu ir pieejami tirgū, sākot ar 2024. gada pirmo ceturksni.
KYB un “VW Group” sadarbojas jau vairākus gadus, viens no šīs

sadarbības rezultātiem ir “Audi RS” sporta balstiekārta. Pašreizējais solis ir daļa no KYB politikas, lai turpinātu stiprināt partnerību ar Vācijas ražotāju. Paveiktais kopīgais darbs ļāva piedāvāt “DCC Pro” tehnoloģiju masveida modeļiem – iepriekš tamlīdzīgas sistēmas tika piedāvātas galvenokārt augšējā cenu segmenta automašīnām. Amortizatorus ar elektronisku vadību KYB ražo gan Āzijā, gan arī Eiropā, tostarp Spānijas rūpnīcā KAMS, kuras kopējā ražošanas jauda ir gandrīz 1,5 milj. amortizatoru gadā.
Organiskā eļļa
Kā zināms, svarīga amortizatora sastāvdaļa ir hidrauliskā eļļa. Šīs eļļas mēdz būt dažādas, bet tām ir viena kopīga iezīme: naftas bāze. Rūpju par ekoloģiju un naftas atkarības
Ražotāju informācija 106


mazināšanu mūsdienu tendenču ietvaros KYB ir izstrādājis amortizatoriem oglekļa neitrālu hidraulisko eļļu, kas nodēvēta par “SustainaLub”. Šīs eļļas bāze ir organiska. Gan bāze, gan piedevu sastāvs ir otrreiz pārstrādājami: bioloģiskās noārdīšanās spējas pakāpe ir vairāk nekā 60 %, ko apstiprina “Eco Mark” (OECD301) sertifikāts.
Tāpat kā jebkurš jaunums, “SustainaLub” eļļa tika pakļauta vairākiem stenda testiem KYB Izstrādes centrā Japānā, kā arī braukšanas apstākļos. Amortizatori ar organisko eļļu tika uzstādīti ūdeņraža prototipam –bagijam “Lexus ROV”. “SustainaLub” šķidrums tika arī testēts skarbos autosporta apstākļos: KYB komanda, kas Japānas rallija čempionātā AJRC piedalījās JN-2 klasē, savās automašīnās izmantoja amortizatorus ar organisko eļļu, sākot no sacensību sestā posma. Veikto izmēģinājumu sērija parādīja, ka organisko eļļas bāzi var izmantot, nekaitējot amortizatoru parametriem, un turklāt šie parametri var pat uzlaboties, pateicoties berzes kontroles tehnoloģijas izmantošanai – apmēram tā, kā tas notiek “KYB Prosmooth” amortizatoros.
Pēc provizoriskām aplēsēm, naftas eļļas nomaiņa pret jauno hidraulisko šķidrumu KYB amortizatoros ļaus ietaupīt līdz 16,6 miljoniem litru eļļas gadā. Galarezultātā KYB šo tehnoloģiju plāno izmantot visiem hidrauliskajiem
Sortimenta

Organiskā hidrauliskā eļļa “SustainaLub”, kas radīta tradicionālās naftas eļļas nomaiņai amortizatoros, tika testēta ūdeņraža bagijā “Lexus ROV”, kā arī KYB komandas sacīkšu automobiļos Japānas rallija čempionātā AJRC.

produktiem. Amortizatoru ar “SustainaLub” eļļu masveida ražošanas uzsākšana plānota 2026. gadā. Vairāk informācijas par KYB jaunumiem un tehnoloģijām pieejama resursā www.kyb-europe.com.

2024. gada sākumā KYB katalogs neatkarīgajam rezerves daļu tirgum tika papildināts ar jauniem produktiem – vairāk nekā 30 amortizatoru artikuliem, gandrīz 70 atsperu artikuliem un 9 balsta gultņu artikuliem. Sortimentā jaunas pozīcijas paredzētas daudziem Eiropas, Amerikas un Āzijas ražotāju modeļiem un aptver vairāk nekā 27 milj. automašīnu uz Eiropas ceļiem.
paplašināšana
Ražotāju informācija 107
Kā “MotoRad” termostati var nodrošināt labāku veiktspēju jūsu transportlīdzekļiem.
Tiem, kas rūpējas par saviem trans portlīdzekļiem, vajadzība pēc pre cīzām un uzticamām dzesēšanas sistēmām ir svarīgāka nekā jebkad agrāk. Dzinēju tehnoloģijai attīstoties, termiskā vadība ir kļuvusi arī sarežģī tāka un daudzos gadījumos ietver vairāk sastāvdaļu. Pat ja tehnoloģija ir mainījusies, joprojām dzesēšanas sistē mas pamatā ir pareizi strādājošs termostats.
“Efektīva dzinēja darbība, samazi not degvielas patēriņu, samazina arī piesārņojošo vielu emisijas, un dzinēja komponentu saglabāšana ir atkarīga no pareizas darba temperatūras uztu rēšanas. Tas nekad nav bijis tik svarīgi kā mūsdienu augsti optimizētajos un tehnoloģiski progresīvajos dzinējos,” stāsta “MotoRad” Centrāleiropas un Austrumeiropas tirdzniecības vadītājs Artjoms Davidovs.
“MotoRad” ir vadošais progresīvu dzinēju un termovadības risinājumu ražotājs un piegādātājs transporta līdzekļu ražotājiem un pēcpārdošanas tirgum kopš 1958. gada, un joprojām tam ir vadoša vieta jaunu iekšdedzes dzinēju, kā arī hibrīdu un visu veidu elektroauto attīstībā un nodrošināšanā. “MotoRad” ir oriģinālo rezerves daļu piegādātājs auto ražotājiem VW, “Audi”, BMW, “Mercedes”, GM, “Stellantis” un daudziem citiem, un to produktu klāsts aptver vairāk nekā 90% no Eiropas autoparka.

“MotoRad” pārstāvis turpina: “Termostatam ir izšķiroša loma temperatūras saglabāšanā vajadzīgajā diapazonā, nevis tikai pārkaršanas novēršanā. Jauno modeļu iekšdedzes dzinēji un elektromotori ir izstrādāti ar īpaši šauriem darba temperatūras diapazoniem, lai nodrošinātu optimālu veiktspēju. Lielākā daļa pēcpārdošanas termostatu ir paredzēti darbībai ar +/- 2 grādu pēc Celsija novirzi, salīdzinot ar OE
aprīkojumā uzstādītajiem. Uzņēmumā “MotoRad” mēs izstrādājam termostatus ar novirzes diapazonu +/- 1 grāds pēc Celsija, lai nodrošinātu efektīvu dzinēja veiktspēju ar vislabāko atbilstību oriģinālā aprīkojuma prasībām.”
Šī temperatūras kontroles optimizācija nodrošina iekšdedzes dzinēju, hibrīdu un elektrisko transportlīdzekļu veiktspēju un efektivitāti aukstos un karstos laikapstākļos. Aukstā laikā ļoti precīzs termostats ļaus dzesēšanas šķidruma temperatūrai ātri sasniegt un uzturēt ieteicamo diapazonu. Siltā laikā augstas kvalitātes termostats pastāvīgi uzturēs temperatūru maksimālās
Šī termiskās efektivitātes optimizācija var būtiski ietekmēt degvielas vai enerģijas patēriņu un emisiju
Pēcpārdošanas rezerves termostats bieži tiek ignorēts kā svarīgs efektīvu, degvielu un enerģiju taupošu un veselīgu transportlīdzekļu veicinātājs. “MotoRad” ļoti nopietni uztver termostata lomu un nodrošina optimālu veiktspēju apvienojumā ar nozares plašāko piedāvājumu un pieejamību.
Plašāka informācija par ražotāju pieejama www.motorad.com
NODROŠINIET SAVU TRANSPORTLĪDZEKĻU EFEKTIVITĀTI, IZMANTOJOT PRECĪZU TERMOVADĪBU
Ražotāju informācija 108































Elring - pilnīgs piegādātājs, kas piedāvā visu, kas nepieciešams
tehnoloģiju jomā mēs esam jūsu uzticams par tneris.
Lai atbalstītu mūsu tirdzniecības un darbnīcu par tnerus, mēs piedāvājam praktiskus uzstādīšanas videoklipus ar noderīgiem padomiem un trikiem profesionāliem tehniķiem. Mūsu
Elring-YouTube kanālā jūs atradīsiet visus uzstādīšanas video.

Ja nevēlaties palaist garām nevienu jaunu
instalāciju video, abonējiet mūsu
Elring-YouTube kanālu!









ww w.elr ing.com Yo u Tub e E lr i ng – D as O r igin a l U zs t ād īš anas v ideo k l i p i i r p ieeja m i t ie
šs a ist ē
ElringKlinger AG | A ermarket division ser vice@elring.com | www.elring.com
HERMĒTIĶI NO “ELRING”
VISS, KAS TIEŠĀM NEPIECIEŠAMS
DARBNĪCĀ MOTORU ZONĀ
“Elring” ražo hermētiķus jau kopš 1930. gadiem. Tolaik bija nepieciešams šķidrs hermētiķis, ar ko papildus hermetizēt šajā laikā pieejamos blīvēšanas materiālus. “Elring” produkta nosaukums bija “Curil”, kas tiek izmantots arī mūsdienās.
Toreiz tas bija cietējošs hermētiķis, kas bija izturīgs pret benzīnu un dīzeļdegvielu. Mūsdienās šis agrāk iemīļotais hermētiķis ir pieejams jaunā versijā, turklāt “Elring” hermētiķu klāstu ir papildinājuši vēl vairāki produkti.
“CurilTM T2” – tiešām universāls hermētiķis
Atšķirībā no priekšgājēja līdzeklim “CurilTM T2”, kas nesatur šķīdinātājus un ir pieejams tirdzniecībā tikai kopš 2021. gada pavasara, nav nepieciešams apžūšanas laiks, proti, montāžas laikā nav jāgaida noteikts laika intervāls, tāpēc darbs tiek paveikts ātrāk. Tā kā produkts nesatur šķīdinātāju, tas neiztvaiko, un tas savukārt nozīmē, ka materiāls nesarūk. Tādējādi blīvēšanas spraugā vairs neveidojas plaisas, un var noblīvēt līdz pat 0,2 mm platas blīvēšanas spraugas. “CurilTM T2” ilgstoši paliek plastisks, proti, tas nesacietē, tāpēc tam piemīt paaugstināta izturība lietojumos, kas pakļauti vibrācijas iedarbībai. Šī īpašība nodrošina arī vieglu demontāžu.

“CurilTM T2” ir teicami piemērots materiālu pāriem metāls/metāls, metāls/plastmasa un plastmasa/
plastmasa. To var nevainojami izmantot arī mīksto materiālu blīvējumos, piemēram, eļļas savācējtvertnes vai ūdenssūkņu blīvējumos. Izmantošanas temperatūras diapazons ir iespaidīgs: no –55 °C līdz +270 °C.
Turklāt jaunais “CurilTM T2” ir izturīgs pret minerāleļļām (arī ar piedevām), sintētiskajām eļļām, konsistentajām smērvielām, dzesēšanas līdzekļiem, aukstu un karstu ūdeni, sālsūdeni, tīrīšanas līdzekļiem, vājām skābēm un sārmiem, benzīnu un dīzeļdegvielu!
Tā uzglabāšanas ilgums ir 36 mēneši, un produkts nav marķēts kā bīstama prece.


“DirkoTM HT” – silikona hermētiķis
Silikona hermētiķus izmanto daudzās motora vietās. Ar tiem blīvē vārstu vākus, sadales mehānisma karteri, eļļas savācējtvertnes, kā arī daudzas pārvada vietas.
“Elring” silikona hermētiķis “DirkoTM HT” sacietē, mijiedarbojoties diviem komponentiem – gaisa mitrumam un skābeklim. Reakcijas ātrums standarta apstākļos, t. i., 23 °C temperatūrā un 50 % gaisa



Ražotāju informācija 110


mitrumā, ir 2 mm 5 stundās. Tomēr praksē “DirkoTM HT” var izmantot jau pēc dažām minūtēm ar tā dēvēto mitrās montāžas metodi. Jāatzīmē arī, ka “DirkoTM HT” ir piemērots vidēji lielām blīvēšanas spraugām līdz 2 mm platumam un ka to var izmantot arī uz lakotām virsmām. Būtiska produkta īpašība ir augstā 315 °C karstumizturība, ko silikona hermētiķis iztur 24 stundas.
Tomēr ir arī noteikti izmantošanas ierobežojumi. Silikons nav izturīgs pret benzīnu un dīzeļdegvielu, taču tā lietošanas diapazons tik un tā ir ļoti plašs. “DirkoTM HT” ir izturīgs pret minerāleļļām, sintētiskajām eļļām, konsistentajām smērvielām, dzesēšanas līdzekļiem, UV starojumu, sālsūdeni, tīrīšanas līdzekļiem, vājām skābēm un sārmiem.
Anaerobie hermētiķi “EL-Liq 73” un “EL-Liq 74”


Nozīmīga motoru hermētiķu grupa ir anaerobie hermētiķi. Kā liecina produkta nosaukums, ķīmiskā reakcija notiek bezskābekļa vidē – otrs komponents ir pilnas virsmas saskare starp divām metāla virsmām. Tikai pēc tam sākas reakcija un veidojas
cietējoša blīvēšanas plēvīte, kam piemīt izturība pret agresīvu vidi un termiskā izturība. Temperatūras diapazons, kurā anaerobie hermētiķi nodrošina hermetizēšanu, ir no –55 °C līdz +180 °C. Tradicionālā lietošanas joma ir vārstu vāku hermetizēšana savienojumā pie cilindra galvas. Produktu var izmantot arī uzticamai sadales mehānisma kartera, izciļņvārpstas balsta, atloku savienojumu, korpusa un gultņu vāku hermetizēšanai. Tā kā nav nepieciešams apžūšanas laiks, hermētiskums tiek nodrošināts uzreiz. Optimālā apstrādes temperatūra ir +23 °C. Virsmas hermētiķi “EL-Liq” ir izturīgi pret agresīvu vidi, ko veido minerāleļļas, sintētiskās eļļas, degviela un dzesēšanas līdzekļu piedevas. Abu blīvēšanas līdzekļu maksimālā blīvējamā blīvēšanas sprauga ir 0,35 mm. Abi “Elring” piedāvātie produkti “EL-Liq” savstarpēji atšķiras ar to, ka “ELLiq 73” līmspēja ir apmēram divreiz lielāka nekā “EL-Liq 74”.
Profesionāla blīvēšana ar tīru sirdsapziņu
Paplašinot un uzlabojot hermētiķu klāstu, “Elring” īpašu uzmanību pievērsa arī tam, lai hermētiķi būtu viegli lietojami un nekaitīgi videi.
“Dirko” melnā, bēšā un pelēkā krāsā ir tā dēvētie oksīmu silikoni, kam raksturīgs ātrs sašūšanas laiks, lieliska saķere un saderība ar metāliem. Tomēr oksīmu silikoniem
ir arī vājā vieta. Sašūšanas procesā izdalās 2-butanona oksīms, ko sauc arī par metiletilketona oksīmu jeb saīsināti MEKO. Tas var izklausīties pēc svarīgas informācijas ķīmiķiem, taču tam ir ļoti liela nozīme personu grupām, kas ikdienā strādā ar šīm vielām, – gan darbnīcā, gan darbojoties ar savu auto, jo MEKO, iespējams, ir kaitīgs veselībai. Šī iemesla dēļ jau kopš 2013. gada septembra Vācijā izmantotajām ķīmiskajām vielām ir noteikta aroda ekspozīcijas robežvērtība 1 mg/m3 gaisā. Šīs stingrās vadlīnijas izpildīja arī “Elring DirkoTM” priekšgājējs, kura ķīmiskais sastāvs atbilda norādītajai minimālajai robežvērtībai. Tomēr, turpinot “DirkoTM HT” izstrādi, tika pieņemts lēmums izveidot hermētiķi, kas nesatur nekādas kaitīgās vielas, un tādējādi kopš 2020. gada februāra tiek piedāvāts “DirkoTM” oksīmu silikona klāsts bez MEKO. Tas ļauj “Elring” klientiem strādāt vidē bez veselībai kaitīgām vielām. Tā ir liela “Elring” silikonu priekšrocība, kas no pirmā acu uzmetiena nav pamanāma.
Arī jauno anaerobo hermētiķu un jaunā “CurilTM T2” receptūra ir veidota ar skatu nākotnē. Šīs hermētiķu grupas tagad nesatur videi kaitīgas vielas, par ko liecina zaļā ikona “ecofriendly”. Turklāt anaerobie hermētiķi ir pildīti praktiskās gofrētās pudelēs ar koniskiem skrūvējamiem vāciņiem (angliski “twist-cap”) – tāpēc tos var precīzi uzklāt un viegli atvērt un aizvērt arī ar vienu roku.
Ražotāju informācija 111
DIGITĀLI UN EFEKTĪVI: STARTERU ATJAUNOŠANA “BOSCH” MODERNAJĀ RŪPNĪCĀ
KRAKOVECĀ
“Bosch” Krakovecas ražošanas platforma atrodas netālu no Ļvivas pilsētas Ukrainas rietumos. Ukrainas un Polijas robeža atrodas tikai 800 metru attālumā. Tas vienkāršo starptautiskos loģistikas sakarus. Vienlaikus atrašanās vieta nelielās Krakovecas pilsētas nomalē atstāj daudz vietas ražošanas platību paplašināšanai nepieciešamības gadījumā.

“Bosch” Krakovecā: atjaunošanas speciālists Ukrainā
“Bosch” rūpnīca Krakovecā, kas specializējusies starteru atjaunošanā, tika dibināta un uzcelta 2003. gada augustā. Sākotnēji uzņēmums piederēja Dānijas uzņēmumam “Holger Christiansen A/S”, kas kopš 2008. gada ietilpst “Bosch” koncernā. Līdz 2022. gadam rūpnīcā bija atjaunoti 4 miljoni starteru. Pašreizējais ražošanas apjoms pārsniedz 300 000 vienību gadā. Plašajā produkcijas sortimentā iekļauti aptuveni 750 dažādi tipi – tie ir starteri vieglo automašīnu dzinējiem, komerctransportam un arī specializētajai smagajai tehnikai.
Rūpnīca Krakovecā produkciju galvenokārt piegādā caur “Bosch eXchange” – apmaiņas programmu “Bosch Aftermarket”. Turklāt autoražotāji starterus no “Bosch Krakovec” iepērk arī


savām rezerves daļu programmām, jo rūpnīcai ir nepieciešamie sertifikāti. Tostarp atjaunošanas procesa efektivitāti un caurskatāmību apstiprina IATF16949 sertifikāts.
Maza, bet jaudīga: saudzīgā ražotne Krakovecā
Uzņēmuma platība ir aptuveni 4000 m2, rūpnīcā strādā 170 cilvēku.
Vairāk nekā pusei šo augsti kvalificēto darbinieku ir 15−20 gadu darba pieredze mezglu un agregātu atjaunošanas sfērā. 2010. gadu sākumā tika būtiski pārskatīts ražošanas operāciju algoritms, un tā rezultātā atjaunošanas process sāka aizņemt 2–3 reizes mazāk laika, vienlaikus uzlabojoties kvalitātei. Tas, protams, pozitīvi iespaidoja efektivitāti un veiktspēju.
Ražotāju informācija 112
Viens no gatavās produkcijas kvalitātes pārbaudes procesa posmiem. Katrs atjaunotais starteris tiek testēts pēc 200 parametriem uz iekārtas, kas imitē tā darbību automašīnā.

Katrs atjaunotais starteris piedalās programmā “Bosch eXchange”. Šajā universālajā programmā ir iekļauti dažādu ražotāju starteri un ģeneratori, kas aptver lielu skaitu vieglo automašīnu un komercauto. Atjaunotās produkcijas funkcionālie izmēģinājumi un kvalitātes pārbaude tiek veikta pēc tādiem pašiem standartiem kā oriģinālajām detaļām.
Mūsdienīgs un efektīvs darba process, pateicoties digitalizācijai

Starteru atjaunošana “Bosch Krakovec” rūpnīcā: ražošanas procesi atbilst ekoloģiskās drošības standartam ISO14001. Atjaunošanas procesa būtība ir sen zināma: no mezgla faktiski paliek korpuss, bet nolietojamie elementi jānomaina pret jauniem. Starterī tiek nomainītas sukas, bukses, gultņi utt. “Bosch Krakovec” rūpnīcā šo detaļu noliktavas sortimentā dažādu zīmolu starteriem ir vairāk nekā 15 000 produkcijas artikulu. Metālietilpīgākais mezgls ir korpuss, un tāpēc atjaunošana ļauj ietaupīt līdz pat 85% materiāla, salīdzinot ar jaunu mezglu ražošanu.

Lai ietu kopsolī ar laiku, rūpnīcas procesi aizvien tiek pilnveidoti. Lai gan “Bosch Krakovec” nav liels uzņēmums, tas ir stingri apņēmies būt vienā līmenī ar “Bosch” etalona rūpnīcām, ja runa ir par digitalizāciju. Kopīgi ar “Bosch Smart Production” uzņēmums ir izstrādājis savu programmatūru, kuras kompleksā un sistēmiskā pieeja aptver lielāko daļu ražošanas un administratīvo procesu.
Jaudīgā lietojumprogramma ļauj ātri reaģēt uz ražošanas uzdevumiem un operatīvi saņemt detalizētu tiešsaistes informāciju no visiem posmiem.
Digitālā apmācība un “Bosch” kontrolētā kvalitāte
Pirms kāda laika tika restrukturizētas un digitalizētas arī darbinieku tehniskās apmācības un regulāra papildu izglītība. Visu veidu darba
instrukcijas un ražošanas dokumentācija no papīra formāta pārveidota digitālā formātā. Informācija regulāri tiek atjaunota, tā vienmēr ir aktuāla un tiešsaistē pieejama ikvienam darbiniekam.
2023. gadā tika ieviesta jauna, pilnībā neatkarīga atjaunošanai saņemto starteru un komponentu pārbaude uz vietas – tas procesu padarīja elastīgāku. Visa atjaunotā produkcija tiek pakļauta daudzpakāpju kvalitātes kontrolei. Daudzi izmēģinājumu stendi (tāpat kā arī ražošanas līnijas) tika izstrādāti un izgatavoti rūpnīcas teritorijā.
Gadu gaitā uzņēmumā ir izveidojusies saskaņota un profesionāla komandu, kas ātri reaģē uz tirgus prasībām, un tāpēc atjaunojamās produkcijas portfolio nepārtraukti palielinās. Detalizētāka informācija par rūpnīcu Krakovecā un citiem “Bosch” uzņēmumiem, kas specializējušies mezglu un agregātu atjaunošanā, pieejama resursā www.boschaftermarket.com.
“Bosch” uzņēmums Krakovecā.
Ražotāju informācija 113
“ABE PERFORMANCE” BREMŽU GARĀS DISTANCES
TESTS
Eksperti no Tehniskās ekspertīzes un apmācību biroja (BETiS) pārbaudīja “ABE Performance” bremžu diskus un klučus uz “Seat Leon”. Testi tika veikti 50 000 km garā distancē dažādos apstākļos. Testu laikā tika novērtēts lietošanas komforts, bremzēšanas veiktspēja un nodiluma rādītāji.

Bremžu komplekta tehniskais stāvoklis pēc testiem
Pēc 50 000 km nobraukuma, galvenokārt pa automaģistrālēm, “ABE Performance” bremžu komplektam nav pārmērīga nodiluma pazīmju. Nodiluma veids un diapazons, iegūtās biezuma vērtības un bremžu diska nobraukuma pielaides

ļauj turpināt bremžu komplekta testēšanu aptuveni 10 000 km garā distancē. Bremžu klučiem ir dabisks nolietojums, kas atbilst veiktajam attālumam. Nav pārkaršanas, nevienmērīga nodiluma vai plaisu pazīmju.

Bremzēšanas efektivitāte un lietošanas komforts

Mēs pārbaudījām testēto “ABE Performance” bremžu disku un kluču komplektu 2018. gada “Seat Leon ST” ar 1.6 TDI dzinēju.
Komplekts tika intensīvi lietots 7 mēnešus 50 000 km garā distance.
Pilna bremzēšanas veiktspēja tika sasniegta pēc 200 km, kas ir standarta bremžu komplekta piestrādes periods.
Bremzēšanas spēka veiktspēja bija laba visos ekspluatācijas apstākļos – neatkarīgi no tā, vai bremžu sistēma bija auksta vai silta.
Pārbaudīto bremžu disku fotogrāfijas. Ražotāju informācija 114



“Seat Leon” C3S012ABE-P Pēc 50,000 km Nodiluma ierobežojums –nepieciešama
Z.2.1 Z.2.2 Z.2.1 Z.2.2 22 mm biezums [mm] 25,01 25,01 24,75 24,75 sākotnējā mešana [mm] 0,02 0,02 0,05 0,03 mešana pēc uzstādīšanas [mm] 0,03 0,03
nomaiņa
spēju. Tas pats attiecās uz konkurentu
Ražotāju informācija 115
ABE – bremžu produkti prasīgiem lietotājiem


uz Maini Yuasa!

www.yuasa.com
PASAULES VADOŠAIS AKUMULATORU RAŽOTĀJS
“SIEVIEŠU RALLIJĀ” DĀMAS NEJOKO

















Izklaide 118










VAI MĒS STRĀDĀJAM LABĀK PIE LIELĀKAS SLODZES?








Jā. DENSO dīzeļdegvielas komponenti nodrošina nemainīgu augstspiediena degvielas piegādi precīzā daudzumā, īstajā laikā. Mūsu inžektori, sūkņi un vadības vārsti satur pasaulē jaunākās novatoriskās tehnoloģijas, lai vienlaikus nodrošinātu efektivitāti, veiktspēju un uzticamību, samazinot atgāzu daudzumu līdz minimumam. Tā ir prātīga izvēle.
IZVĒLIES DENSO. Atbrīvo prātu citām domām.
w w w .denso-am.eu
STARPTAUTISKĀ IZSTĀDE “AUTO 2024”
SOLA INTERESANTUS
PĀRSTEIGUMUS
Ķīpsalas hallē šogad jau 28. reizi durvis vērs Baltijā jaudīgākā starptautiskā auto industrijas izstāde “Auto 2024”. Izstāde būs skatāma no 19. līdz 21. aprīlim, un līdztekus dažām Eiropas mēroga pirmizrādēm redzēsim arī sensacionālu jaunumu – ķīniešu autobūves gigants
“Great Wall Motors” prezentēs Baltijas tirgū jaunu elektromobiļu zīmolu “Ora”.
Izstāde, kā tradicionāli ierasts, apvienos trīs tematiskās sadaļas – jauno automobiļu un komerctransporta sadaļu “Jauni auto”, kurā Eiropas un Baltijas pirmizrādes piedzīvos vairāki auto, sadaļā “Auto mehānika” apmeklētāji varēs iepazīties ar jaunumiem auto apkopes jomā, savukārt apmeklētāju īpaši iecienītajā sadaļā “Auto Exotica” būs skatāmi retro automobiļi, sporta un dragreisa spēkrati, arī automašīnas, kurām enerģiju dod saules paneļi. Vairāki no šiem auto ceļu uz Rīgu mērojuši no Somijas, Zviedrijas un Igaunijas. “Auto” projekta vadītājs Gints Šāvējs stāsta, ka

būs arī unikāls, līdz šim Rīgā neredzēts moto kaskadieru šovs, ko demonstrēs viesi no Skandināvijas. Savukārt ģimeņu izklaidei darbosies “Active Park” bērnu kartings, “VR Gaming” auto simulatori, virtuālās realitātes turnīrs, atrakcijas un arī citas izklaides.
Rīgas auto izstāde ir uz viļņa Šī gada izstāde “Auto 2024” ievērojama arī ar to, ka savā ziņā esam “izgriezuši pogas” lielākajām Eiropas auto izstādēm. Piemēram, savulaik par nozares Meku uzskatītā izstāde “Ženēvas autosalons”, kura pēc trīs gadu pārtraukuma un viesizrādes Katarā 2023. gada oktobrī šogad atkal vēra durvis, salīdzinot ar pirmspandēmijas laiku, pulcēja trīsreiz mazāk apmeklētāju, bet vairāki autoražotāji, tostarp lielais vācu trijnieks, tajā nemaz nepiedalījās. Kamēr vēl nesenā pagātnē ietekmīgo autoizstāžu rīkotāji meklē investorus, ikgadējā autoizstāde Ķīpsalā par intereses un apmeklētāju trūkumu žēloties nevar. Trīs izstādes dienās atrast vietu sava
auto novietošanai Ķīpsalas halles tuvumā ir teju neiespējamā misija. Atbildot uz jautājumu, vai arī šogad var prognozēt, ka apmeklētāji halli “gāzīs riņķī”, Gints Šāvējs saka – vienmēr ir gāzuši, ja vien nav kādi mistiski ārēji apstākļi, kā, piemēram, kovids un tā ierobežošanai noteiktie pasākumi, un viss liecina, ka liela interese būs arī šajā gadā.
Redzēt, sajust, aptaustīt un apskatīt dabā
Izstādē varēs iepazīt jaunākos auto modeļus, mobilitātes risinājumus, komerctransportu, uzlādes stacijas, spilgtus hobija auto un sporta spēkratus, kā arī autopiederumus un servisa aprīkojumu. Kā ik gadu, lielu daļu ekspozīcijas aizņems degvielas, auto piederumu, pakalpojumu un citu ar auto tieši vai netieši saistītu uzņēmumu veikums. Notiks arī “Auto mehānika” sadaļas dalībfirmu profesionālie semināri transporta nozarei un “Inter Cars Latvija” tehniskās apmācības un profesionālie semināri.
Izklaide 120

Tomēr galvenajā lomā, protams, būs auto, iespēja labi pavadīt laiku dažādu spēkratu sabiedrībā un noskatīt sev jaunu, uzticamu transportlīdzekli. Kā norāda Gints Šāvējs: “Tagad var daudz ko redzēt digitāli un apskatīt internetā, bet tam gala lēmumam tomēr ir vajadzīgs parunāt un pakonsultēties ar cilvēkiem, kuri ir attiecīgajā stendā, un pašam redzēt, sajust, aptaustīt, apskatīt dabā, kāda tā mašīna ir. Izstāde tam ir neatsverams palīgs, kur var apskatīt dažādu auto modeļus, izzināt to stiprās un vājās puses un tikai tad pieņemt lēmumu.”
Ja šķiet, ka ar paša zināšanām un izpratni ir par maz, tad sestdien, svētdien hallē būs sastopams autožurnālists Normunds Avotiņš, kurš visos stendos autotirgotājiem uzdos āķīgus jautājumus. Interesenti var pastaigāt viņam līdzi un uzzināt daudz jaunas un objektīvas informācijas par tajos izstādītajiem automobiļiem.


Jauni auto – jauni pārsteigumi
Sadaļā “Jauni auto” solās būt tiešām daudzpusīgs automobiļu klāsts, tostarp “premium” zīmoliem “Maserati” un “Audi”. Tāpat būs apskatāmi arī jaunākie “Volkswagen”, “Škoda”, “Renault”, “Dacia”, “Cupra”, “Nissan”, “Hyundai”, “Citroen”, “Peugeot”, “KGM”, “Opel”, “Suzuki”, “Isuzu” un citi modeļi. Īpaši jāatzīmē, ka šogad izstādē atgriežas vairāki sen neredzēti autozīmoli, piemēram, “Subaru” un “Honda”. Būs skatāmas dažas Eiropas mēroga pirmizrādes, tostarp jaunie “Škoda Kodiaq” un “Škoda Superb”, kā arī pilnībā jaunais “VW Tiguan”, atjauninātais “T-Cross” un elektromobilis “Volkswagen ID7”.
“Škoda Kodiaq”, kurš no šī pavasara ir arī Latvijas tirgū, pirmo reizi vēsturē

pieejams kā “plug-in” hibrīds ar kopējo jaudu 204 ZS, un pilnībā elektriskajā režīmā ar to iespējams nobraukt vairāk nekā 100 km. Kā “Škoda Superb” modeļu galvenās priekšrocības tiek minētas reprezentativitāte, komforts, iespaidīgs salons un bagāžas nodalījums, piemērotība visai ģimenei. Jauno “Superb” un “Kodiaq” cenas tiks izziņotas tieši izstādē! Šos auto, tāpat
Izklaide 121



kā atjauninātos “Kamiq”, “Scala” un “Octavia”, redzēsim “Škoda” importētāja “Auto 100” stendā.
Savukārt “Moller Auto” stendā varēsim apskatīt jauno “VW Tiguan”, kurš tiek pieteikts kā daudzpusīgs apvidus automobilis, un pirmo pilnībā elektrisko vidējā izmēra sedanu “Volkswagen ID7”. Šis auto ar vienu uzlādi var nobraukt līdz 700 kilometriem. Redzēsim arī atjaunināto “T-Cross” un kulta pikapa “Amarok” jaunāko izlaidumu.
“Audi” pārstāvji izstādē startēs ar īpašiem “Q8 e-tron” un “Q4 e-tron” piedāvājumiem, bet par sensacionālu jaunumu būs parūpējies izstādēs sen neredzētais “Īle Auto”. Proti, Latvijas tirgū ienāk ķīniešu giganta “Great Wall Motors” elektromobiļu zīmols “Ora”. Jāatzīmē, ka neatkarīgais institūts Euro NCAP, kurš testē Eiropas tirgum paredzēto jauno automobiļu drošību, “Ora” atzina par labāko mazizmēra ģimenes auto modeļu klasē. “Ora 03”, kas pazīstams arī kā “Ora Funky Cart”, bāzes versija aprīkota ar 48 kWh LFP bateriju un motoru, kas nodrošina 126 kW un 250 Nm jaudu, ļaujot tai
ieskrieties līdz 100 km/h 8,3 sekundēs. Lēnā uzlāde (Type 2) ir 11 kW, bet ātrā (CCS2) – 64 kW. Pēc WLTP datiem, “GWM Ora 03” ar mazo bateriju var nobraukt līdz 310 km ar vienu uzlādi.
Tāpat izstādē būs pārstāvētas Ķīnas auto markas, kuras prezentēs “Auto Rings Group”. Izstādes apmeklētāji varēs iepazīties ar jaudīgo darba zirgu 4x4 pikapu “JAC 8 PRO”, moderno un komfortablo krosoveru “BAIC X55”, sportisko “FORTHING 5”, kā arī eleganto un ērto ģimenes auto “FORTHING 4”. Vēl uzņēmums iepazīstinās ar robotizēto automazgātavu tīklu “LaserWash 360®” un īpašo automašīnām paredzēto grīdas segumu “Swisstrax”. Auto zīmolu pārstāvji “Auto 2024”
apmeklētājiem sola īpašas izstādes cenas. Interesenti varēs konsultēties arī par elektroauto valsts atbalsta mehānismiem un to ekspluatācijas priekšrocībām.
Neparasto auto parāde –“Auto Exotica”
Šī jau tradicionāli ir izstādes neparastākā un krāšņākā sadaļa, kurā vienmēr ir redzami arī īpaši pārsteigumi. Ne velti Gints Šāvējs saka: ““Auto Exotica” ir mašīnas, kuras ikdienā neredzēsi.”
Hobija auto kustība – interesanti pārbūvēti vai kvalitatīvi restaurēti auto savam priekam un brīvdienām – joprojām ir aktuāla. Šādi auto kuplā skaitā, tāpat arī jaudīgi un tūnēti sporta auto būs redzami eksotisko auto sadaļā. Redzēsim Baltijā būvētu hiperauto sacīkšu trasēm. Savukārt Igaunijas sadarbības partneri sola atgādāt sporta auto, kas darbojas tikai ar saules enerģiju. Kā ierasts, izstādē norisināsies arī konkurss “Auto Exotica Awards”, kurā noskaidros un apbalvos labākos šīs sadaļas eksponātus.
Šajā sadaļā paredzēti arī tādi izklaides notikumi kā jau minētais moto kaskadieru šovs, bet pirms tā nepalaidiet garām “Auto moto un dejas”, par kurām parūpēsies deju grupa “Bachata Ladies”.
No 19. līdz 21. aprīlim Ķīpsalas hallē Baltijā lielākajā auto industrijas izstādē “Auto 2024” būs ko redzēt gan lieliem, gan maziem. Nepalaidiet garām!

Izklaide 122
Lai kāds būtu spēka pārvads, GKN Automotive tam ir risinājums

GKN Automotive piedāvā pilnu pusasu un nemainīga leņķiskā ātruma šarnīru risinājumu sortimentu, atvieglojot atbilstošā risinājuma uzstādīšanu visu veidu vieglajiem pasažieru automobiļiem: hibrīda, elektriskajiem vai ar iekšdedzes dzinēju aprīkotajiem.
Mūsu Countertrack® nemainīga leņķiskā ātruma šarnīros tiek izmantotas pretējas sliedes, kas labāk līdzsvaro iekšējos spēkus, samazinot berzi un uzlabojot efektivitāti un NVH. Rezultātā GKN Automotive risinājumi ļauj automobiļiem piedāvāt virkni dažādu spēka pārvadu un dzinēja jaudu paleti, kas ļauj saglabāt ierastos balstiekārtas ģeometrijas rādītājus un izmērus.
Iekšdedzes dzinējs, hibrīds vai elektromotors; priekšējā, aizmugurējā vai visu riteņu piedziņa: detaļas ir svarīgākas nekā jebkad iepriekš. GKN Automotive tam ir risinājums.
GKN Automotive ir vislielākais pēcpārdošanas tirgus sortiments
elektriskajiem automobiļiem un hibrīdautomobiļiem
GKN elektrisko automobiļu/hibrīdautomobiļu IAM programma:
Automobiļu veidi
Ekspluatācijā esoši automobiļi
Pusasu sistēmas hibrīdautomobiļiem un elektromobiļiem
Elektrifikācija nosaka jaunas tehniskās prasības elektromobiļu pusasīm. GKN Automotive piedāvā virkni risinājumu, no lielākiem šarnīru leņķiem līdz adresātu iepakojumu izmaiņām, līdz paaugstinātai stingrībai, lai nodrošinātu labāku svārstību kontroli, un augstāka efektivitāte, kas nodrošina akumulatoru izmaksu ietaupījumus.

GKN Automotive pieredze moduļu risinājumu un piedziņu sistēmu projektēšanas jomā parūpējas par detaļām, kas rada pievienoto vērtību. Tādēļ mēs arī esam līderi hibrīda un elektrisko spēka pievadu jomā.
www.gknautomotive.com
3 3 7 4 13 8 9 0 14 2
PAGALVJI AUTOMAŠĪNĀ: KĀPĒC TIE IR NEPIECIEŠAMI, UN KĀPĒC TIE NE VIENMĒR PALĪDZ
Trieciens no aizmugures ir viens no visizplatītākajiem
CSN veidiem: aptuveni 50% no kopējā skaita, saskaņā ar visas pasaules statistiku. Zināms, ka pat no ne pārāk spēcīga sitiena pa mašīnas aizmuguri var gūt visai nelabu kakla traumu galvas straujas atliekšanās dēļ. Tieši šādu nepatikšanu profilaksei uz automašīnu sēdekļiem parādījās pagalvji, taču to esamība pati par sevi nav panaceja.


Ātruma paradoksi
Ar kādu ātrumu trieciens tiek uzskatīts par bīstamu – tas ir katra cilvēka individuāls jautājums. Eksperti saka, ka nozīme nav tik daudz ātruma lielumam skaitļos, cik automašīnu ātrumu starpībai: tās, kas ietriecas, un tās, kurā ietriecas. Saskaņā ar statistiku, lielākā daļa traumu tiek gūtas, ja ātrumu starpība ir 16 km/h un vairāk. Kas attiecas uz ātruma absolūto lielumu, tad ar mazu ātrumu autovadītāji traumas gūst ne retāk kā lielā ātrumā, lai cik paradoksāli tas arī neizklausītos. Tas izskaidrojams ar to, ka mazā ātrumā cilvēks bieži vien ir atslābinājies, savukārt
lielā ātrumā – koncentrējies: kakla muskuļi nevilšus ir sasprindzināti, un trieciena gadījumā tie uzņem ievērojamu daļu slodzes.
Slepenā slimība
Visizplatītākā parādība trieciena no aizmugures gadījumā ir mugurkaula kakla daļas pātagas cirtiena trauma. Šī trauma ir mānīga tālab, ka to uzreiz var nepamanīt vai nepievērst uzmanību – gadās, ka kādu laiku pēc sitiena cilvēks nemaz nejūt nekādus nepatīkamus simptomus vai arī kakls nedaudz pasāp, kam daudzi nepievērš uzmanību – tā sakot, tāpat pāries. Ja sāpes nepāriet, bet kļūst stiprākas, tad labāk neielaist.
Izklaide 124


Nākamā stadija var būt miega traucējumi vai redzes pasliktināšanās. Tāpat arī pātagas cirtiena traumu dažreiz neizdodas kvalificēt kā apdrošināšanas gadījumu, jo to ir grūti diagnosticēt – rentgena uzņēmumos mugurkaula locītavu izaugumu mikroplaisas bieži vien nav redzamas.
Pagalvju rašanās
Kā zināms, diezgan ilgu laiku automašīnu sēdekļiem pagalvju nebija. Mūsdienu pagalvja prototips tika izveidots 1960. gadu beigās, izstrādātājs bija inženieris Bela Bareni. Tas ir tas pats cilvēks, kurš pirmais noformulēja automašīnas
pasīvās drošības metodiku pamatus: tieši viņš izdomāja koncepciju par virsbūves spēka režģi un deformācijas zonām, stūres statni, kas salokās sadursmes gadījumā, un daudz ko citu.
1968. gadā pagalvji tiek iekļauti “Mercedes-Benz” automašīnu standarta aprīkojumā. 1969. gadā Amerikas valdības autoceļu drošības asociācija NHTSA ieteica uzstādīt pagalvjus visās ASV pārdotajās automašīnās, savukārt trīs gadus vēlāk tika izstrādāts pirmais standarts, kas reglamentēja pagalvja minimālo izmēru. Trīspadsmit aktīvas lietošanas gados tika apkopota statistika, un 1982. gadā NHTSA

Par auto pagalvja izgudrotāju tiek uzskatīts Bela Bareni: inženieris ar ungāru saknēm, kurš deva lielu ieguldījumu automašīnu pasīvās drošības attīstībā. Bareni strādāja uzņēmumos “Daimler-Benz”, “Steyr”, “Adler”, “Austro-FIAT”, “Tatra” un citos. Viņa kontā ir vairāk nekā 2000 patentu, 1994. gadā viņš tika uzņemts Automobiļu slavas zālē, bet 1999. gadā bija viens no 26 pretendentiem, kas nominēti “Gadsimta autoinženiera” titulam.
publicēja pētījumu rezultātus, kuros teikts, ka vieglajos automobiļos trieciena no aizmugures gadījumā pagalvji kā pagarinātas sēdekļu atzveltnes kakla traumu risku samazina par 17%, bet regulējamie pagalvji – par 27%.
Pagalvju standarti ir pārskatīti vairākas reizes, palielinājās to izmērs, un arvien biežāk sāka izmantot tādu risinājumu kā aktīvie pagalvji. Kādā brīdī pagalvji kļuva par obligātiem elementiem. Aizmugures triecienos gūto traumu skaits tiešām samazinājās, taču dažos gadījumos pagalvji izrādījās nederīgi. Kāpēc?
Izklaide 125
Pareiza pozīcija
Pasargāties no pātagas trieciena traumas ir ļoti vienkārši: jo augstāks ir pagalvis un jo tuvāk tas atrodas galvvidum – jo mazāka iespēja gūt traumu. Ir dažādi formulējumi saistībā ar pareizu pagalvja pozīciju, piemēram – pagalvja vidum jāatrodas ausu ļipiņu vidus līmenī. Ne gluži vienmēr izdodas pagalvi uzstādīt tā, kā tiek ieteikts, taču – jo tuvāk šai pozīcijai, jo labāk. Dažos gadījumos noderīgi izrādās speciāli papildus uzliekami spilveni. Kopumā ņemot, jo īsāku attālumu līdz pagalvim veic galva aizmugures trieciena gadījumā un jo mazāks ir atliekšanās leņķis, jo drošāk. Vai visās automašīnās pagalvji ir pareizi noregulēti? Tas attiecas uz jautājumu par to, kāpēc dažos gadījumos pagalvji nepasargā no traumas vai neaizsargā pietiekami.
Ne gluži vienmēr izdodas pagalvi uzstādīt tā, kā tiek ieteikts, taču – jo tuvāk galvvidum, jo labāk. Dažos gadījumos noderīgi izrādās speciāli papildus uzliekami spilveni.

Jo tuvāk galvvidum atrodas pagalvis, jo labāk. Citiem vārdiem sakot – jo īsāku attālumu veic galva aizmugures trieciena laikā un jo mazāks ir atliekšanās leņķis –jo mazāks ir pātagas cirtiena traumas gūšanas risks.
Aktīvie pagalvji
Mūsdienās pastāv daudz aktīvo pagalvju konstrukciju, tostarp ar elektroniku vadāmo, tomēr diezgan efektīva izrādās pat vienkārša mehāniska shēma. Vienkāršāk sakot, krēsla atzveltnē ir svira. Aizmugures trieciena gadījumā vadītāja mugura tiek iespiesta sēdeklī un nospiež sviras apakšējo galu. Tiek aktivizēts svārstīklai līdzīgs mehānisms, tuvinot pagalvi vadītāja galvai vēl pirms tās atliekšanās. Pēc sadursmes
pagalvji atgriežas sākumstāvoklī. Aktīvie pagalvji parāda labus rezultātus mazā un vidējā ātrumā, tomēr arī tiem ir jābūt pareizi noregulētiem.
Starp citu, prakse liecina, ka stipri un trenēti kakla un muguras muskuļi dažreiz diezgan labi pasargā kakla skriemeļus, protams, ne tā kā pagalvis, taču traumas iespējamība tomēr samazinās. Tātad fizkultūra un sports ir labs papildu profilakses veids. Skan banāli, bet tas ir fakts.

Izklaide 126
NOx SENSORI
TRANSPORTLĪDZEKĻU
ELEKTRONIKA
Saistībā ar arvien pieaugošajām ekoloģijas prasībām transportlīdzekļu izmešiem tiek pievērsta arvien lielāka uzmanība. Stingrāks regulējums pieprasa arvien uzlabotākas izmešu kontroles tehnoloģijas. Nox sensori ir jaunākais papildinājums mūsu izmešu sensoru kontroles klāstā. Vēl vairāk, tie liecina par mūsu kopīgo apņemšanos veidot tīrāku un ilgtspējīgāku nākotni
OE PRECIZITĀTE KLĀSTA PAPILDINĀŠANA SERVISA PALĪDZĪBA
Izgatavoti pēc stingrākajiem orģinālaprīkojuma standartiem, nodrošinot nevainojamu un atbilstošu darbību
Piedāvājums nosedz jau vairāk nekā 70 miljonu pasažieru un komerctransporta vajadzības visā Eiropā
No diagnostikas līdz tehniskajam atbalstam... Mēs atradīsim risinājumu!






ATPŪŠAMIES KOPĀ
AR “INTER CARS”.
AIZRAUJOŠA NEDĒĻA
ITĀLIJAS ALPOS
Jau deviņpadsmitā gadsimta otrajā pusē Madonna di Kampiljo (Madonna di Campligio) bija iecienīta Austrijas muižnieku un turīgo buržuā iecienīta atpūtas vieta – tās viesu vidū bijis arī Austrijas imperators Francis Jozefs un valdzinošā Bavārijas princese Sisī, kura vēlāk kļuva par Austroungārijas imperatori. No 10. līdz 17. martam šeit slēpošanas priekus baudīja gada akcijas “Strādā vai atpūties ar Inter Cars!” uzvarētāji.


Akcija ilga no pagājušā gada 1. janvāra līdz 31. decembrim, un tie klienti, kuri bija izpildījuši konkrētu iepirkumu apjomu, bija iespēja izvēlēties – saņemt servisa iekārtas vai instrumentus no
“Inter Cars Latvija” sortimenta 1500 eiro (bez PVN) vērtībā, vai arī ielūgumu vienai personai pilnībā apmaksātai aktīvai atpūtai Alpos pavasara pirmajā mēnesī martā. Iespēju doties uz Madonna di Kampiljo slēpošanas kūrortu izmantoja 63 klienti, savukārt iekārtas izvēlējās 42 “Inter Cars Latvija” klienti.
Sniegs un saule. Lieliski!
“Inter Cars Latvija” mārketinga departamenta vadītājs Armands Umbraško stāsta, ka Madonna di Kampiljo priekš slēpošanas un dēļošanas ir tiešām ļoti pārdomāts, ērts un plašs kūrorts, kurā tur pavadītās nedēļas laikā varēja ik dienas slēpot citās trasēs. Ikvienam gribētājam bija iespēja pilnveidot savas slēpošanas prasmes instruktoru pavadībā un ne viens vien to arī izmantoja savu spēju un iemaņu uzlabošanai.

Paraksts INTER CARS aktualitātes 128


Taujāts, kāda bija sajūta atrasties šai Alpu kalnu kūrortā pēc ziemas izskaņā pelēcīgās un drēgnās Rīgas, Armands atbild: “Lieliski! Laiks bija fantastisks, katru dienu spīdēja saulīte un arī sniega bija daudz.”
Tāpat bija padomāts par daudzveidīgu pasākuma programmu –sacensībām milzu slalomā un tām sekojošu uzvarētāju apbalvošanu, kā arī veldzi viesnīcas SPA kompleksā.
Savs laiks slēpošanai, savs – izklaidei
Kūrorta relaksētā un vieglā atmosfēra vienlīdz piesaista gan Itālijas, gan citu valstu viesus. Mājīga un komfortabla ir arī “Carlo Magno Hotel SPA Resort4” viesnīca, kura izvēlēta kā grupas apmešanās vieta. Var teikt, ka divas tās trešdaļas šajā nedēļā piederēja tikai baltiešiem, jo līdztekus latviešiem uz Madonna di Kampiljo devās arī 60
“Inter Cars” gada akcijas dalībnieki no Lietuvas un 40 – no Igaunijas.
Jāsaka, ka šis ir pats skaļākais reģiona kūrorts ar aktīvu apres-ski jeb “pēc slēpošanas” dzīvi. Jo, lai arī galvenajā lomā ir ziemas aktīvās atpūtas baudīšana, netrūkst arī citu izklaides iespēju. Kūrorta centrā ir kvartāls ar daudzveidīgajām kafejnīcām, restorāniem, bāriem un dažādiem veikaliem katrai gaumei un budžetam, ir kino, sporta centri, baseini, boulinga zāles, slidotavas un iespēja izbraukt suņu pajūgos, kā arī termu centrs.
Madonna di Kampiljo savu popularitāti arī vasarā – tā atrašanās vieta ir ideāli piemērota pārgājieniem, velobraucieniem un kalnu riteņbraukšanai. Pateicoties Brentas Dolomītiem, apkārtējā ainava līdzinās filigrāni izstrādātai pastkartei. Madonna di Kampiljo ir vieta, kurp noteikti vērts atgriezties!

Ledāju ieskautā “Dolomītu pērle”
Madonna di Kampiljo atrodas pašā Val Rendenas kalna sirdī, iespaidīgā ielejā starp Brentas Dolomītiem un Adamello un Presanella ledājiem. Šī nelielā kūrortpilsēta ar aptuveni 800 iedzīvotājiem izvietojusies 1550 metru augstumā virs jūras līmeņa, un ir viena no slavenākajām visā Trentino reģionā. Paši itāļi to mēdz dēvēt arī par “Dolomītu pērli”. Šī kalnu kūrorta galvenā pievilcība joprojām ir neskartā daba un iespēja baudīt patiesi krāšņas ainavas –majestātiskos, sniegotos kalnus, ezerus, ielejas, strautus, kā arī tuvumā esošo Adamello-Brentas dabas parku ar kalnu takām, egļu un lapegļu mežiem. Taču galvenais magnēts, kurš ik gadus uz šejieni velk neskaitāmus ziemas aktīvās atpūtas cienītājus, ir slēpošanas zona ar 57 pacēlājiem un dažāda līmeņa trasēm ar kopējo garumu 150 km, kā arī 40 km garu distanču slēpošanas trasi. Katrs var izvēlēties savām spējām piemērotāko trasi – puse no tām ir tā saucamās “zilās trases” ar zemu sarežģītības līmeni, 30% ir sarkanās jeb vidēji sarežģītās, bet ekstrēmu sajūtu cienītājiem domātas melnās, jeb visgrūtākās trases, tādu ir 20%. Tieši šeit, “3 Tre” nogāzē, notiek Pasaules kausa izcīņas sacensības kalnu slēpošanā slalomā.
INTER CARS aktualitātes 129
PASAULES ČEMPIONĀTS HOKEJĀ UN ČEHIJA GAIDA!
VĒL VAR PASPĒT PIEDALĪTIES
“INTER CARS” AKCIJĀ
Arī šogad turpinās “Inter Cars Latvija” iedibinātā tradīcija kopā ar klientiem, kuri izpildījuši akcijas nosacījumus, klātienē vērot lielo hokeju un just līdzi mūsu valsts hokeja valstsvienībai. Čehijas pilsētas Ostravas “Ostravar Arena” vērosim Latvijas spēli pret Polijas un Francijas izlasēm un, protams, turēsim īkšķus par savējiem!

“Inter Cars Latvija” klienti, kuri no šī gada 1. janvāra līdz 30. aprīlim piedalīsies ražotāju LIQUI MOLY, OSRAM, EXIDE, TUDOR un DETA akcijā un izpildīs tās noteikumus, 10. maijā Rīgā sēdīsies komfortablā, kompānijas sarūpētā autobusā, lai kopā ar “Inter Cars Latvija” pārstāvjiem dotos uz pasaules čempionātu hokejā Čehijā, Ostravā.
Akcijas noteikumi ir vienkārši –uz Čehiju dosies:
10 klienti, kuri akcijas periodā būs nopirkuši EXIDE, DETA, TUDOR produktus


par vismaz 500 EUR (bez PVN) un uzrādīs lielāko pirkumu apjoma pieaugumu pret pagājušā gada analoģisko periodu (no 2023. gada 1. janvāra līdz 30. aprīlim).
10 klienti, kuri akcijas periodā būs iegādājušies LIQUI MOLY produktus par vismaz 500 EUR (bez PVN) un uzrādīs lielāko apjoma pieaugumu pret iepriekšējiem 4 mēnešiem (no 2023. gada 1.septembra līdz 31. decembrim).
Izklaide 130
Visi akumulatoru ražotāji apgalvo, ka piedāvā labāko produktu tirgū.



Mūsu akumulatori to pierāda tad, kad tas ir patiešām svarīgi.
exidegroup.com

 Inovācijas Ilgtspējība Uzticamība Augsta veiktspēja
Nākotnes radīšana – Exide stilā:
Inovācijas Ilgtspējība Uzticamība Augsta veiktspēja
Nākotnes radīšana – Exide stilā:

10 klienti, kuri akcijas periodā būs iegādājušies OSRAM produktus par vismaz 500 EUR (bez PVN) un uzrādīs labākos pirkuma pieaugumus pret analogu periodu pērn (no 2023. gada 1. janvāra līdz 30. aprīlim).
Tāpat PČ hokejā klātienē varēs vērot klienti, kuri no “Inter Cars Latvija” būs iegādājušies jebkurus balstiekārtas produktus vismaz 300 eiro (bez PVN) vērtībā. Balvu saņems TOP 5 lielāko pirkumu kopsummu sasniegušie klienti un 15 klienti, kuri no šā gada 1. janvāra līdz 30. aprīlim būs uzrādījuši lielāko pirkuma apjoma pieaugumu, salīdzinot ar analoģisku periodu pagājušajā gadā. Aprēķinot akcijas rezultātus, vērā tiks ņemtas tikai juridiskas personas.
Abu akciju uzvarētājiem būs iespēja vērot Latvijas izlases spēles pasaules čempionātā – 11. maijā ar Polijas valstsvienību, bet dienu vēlāk redzēsim, kā mūsu hokejisti mērosies spēkiem ar Francijas izlasi.
Latiņa pacelta augstu. Vai spēsim to noturēt?

nūjas ar Slovākiju, bet apakšgrupu turnīru noslēgs 21. maija pēcpusdienā ar cīņu pret ASV. Laikam gan nevienam nebūs jāatgādina, ka pagājušā gada pasaules čempionātā Latvijas hokejisti “Tampere Deck Arena” Somijā papildlaikā pārspēja ASV valstsvienību ar 4:3 un izcīnīja Latvijai bronzu. Tā ir augsta latiņa, kuru noturēt nebūs viegli.
10. pozīcijā, Polija ir ranga
22. vietā, savukārt Francijas hokeja izlase IIHF rangā ir 13. pozīcijā, un pēdējos gados tās labākais sniegums PČ bija 2014. gadā izcīnītā 8. vieta.
Tradīcija turpinās
Latvijas izlase spēlē A apakšgrupā, mačus aizvadot Ostravā. Saskaņā ar Ostravas grupas spēļu kalendāru, pēc mērošanās spēkiem ar Polijas un Francijas hokeja izlasēm 14. maijā latvieši cīnīsies pret Kazahstānu, 15. maijā pret Vācijas izlasi, bet 18. maijā Latvija uz ledus kāps pret Zviedrijas komandu, 19. maijā krustos
Cīņā pret poļiem Latvijas hokejistiem var nākties krietni pasvīst, jo pagājušā gada pasaules čempionātā Polijas valstsvienībai pirmo reizi kopš 2002. gada izdevās iekļūt PČ elites divīzijā pēc tam, kad tā Lielbritānijas pilsētā Notingemā pasaules čempionāta 1A divīzijas turnīrā ar 6:2 pieveica Rumāniju. Šis lēciens var būt par nopietnu stimulu, lai poļi cīnītos patiešām spīvi.
Latvijas izlase pēc pērn PČ izcīnītās bronzas Starptautiskās hokeja federācijas (IIHF) rangā ierindojusies
PČ hokejā klātienē “Inter Cars Latvija” klienti vērojuši 2019. gadā Bratislavas Ondreja Nepela ledus hallē, 2020. gadā Šveicē plānotais pasaules hokeja čempionāts Covid-19 pandēmijas dēļ tika atcelts, bet gadu vēlāk lielo hokeju pašu mājās klātienē nevarējām skatīties epidemioloģiskās drošības prasību dēļ. Toties 2022. gadā “Inter Cars Latvija” klienti Latvijas hokeja izlases spēles pret Austriju un Čehiju klātienē skatīja “Tampere Deck Arena” Somijā, bet pērn mūsu hokeja izlases spēlēm pret Kanādas un Šveices komandām klātienē jutām līdzi “Arēnā Rīga”. Tagad braucam uz trešo lielāko Čehijas pilsētu Ostravu.
Izklaide 132



Oficiālais sponsors –“Škoda Auto”
Šī gada PČ hokejā būs jau 88. pasaules čempionāts. Tas norisināsies no 2024. gada 10. maija līdz 26. maijam Čehijas galvaspilsētā Prāgā un Ostravā. Kopš 1992. gada IIHF hokeja pasaules čempionātu sponsorē Čehijas autoražotājs “Škoda”. Pirmajā gadā kā mobilitātes partneris, pēc tam jau kā PČ galvenais oficiālais sponsors. 2017. gadā “Škoda Auto” iekļuva Ginesa rekordu grāmatā par ilgāko galvenā sponsora goda saglabāšanu pasaules čempionātā sporta vēsturē. 2022. gadā “Škoda Auto” ar IIHF parakstīja līgumu vēl uz pieciem gadiem, tātad līdz 2027. gadam lielā hokeja un “Škoda” partnerība ir garantēta.
Arēna ar “atmosfēru”
“Ostravar Arena” ir ne vien Čehijas ekstralīgas komandas Vītkovices “Ridera” mājvieta, bet arī daudzu Ostravas reģiona sporta un kultūras pasākumu centrs. Jāatgādina, ka šī gada sākumā Vītkovices “Ridera” pievienojās arī Latvijas hokejists Rihards Bukarts, bet viņa brālis Roberts Bukarts šīs komandas rindās spēlē jau trešo sezonu pēc kārtas.
Arēna uzbūvēta 1986. gadā, bet atjaunota 2003. un 2004. gada mijā. Tās ietilpība 2018. gada vasarā tika samazināta no 12 500 līdz 10 004 sēdvietām. Tomēr, kā norādīts IIHF interneta vietnē, arēna nav zaudējusi ne mazumiņu no savas atmosfēras un, pateicoties modernajam aprīkojumam, var kalpot par visprasīgāko pasākumu rīkošanas vietu. Savukārt savu tagadējo nosaukumu arēna guva 2016. gadā, kad “Ostravar” alus darītava kļuva par tās ģenerālpartneri pēc tam, kad Čehijas enerģētikas kompānija “ČEZ” taupības nolūkos arēnas sponsorēšanu pārtrauca. Likumsakarīgi, ka visās arēnas kafejnīcās un pat tās tuvumā tiek pasniegts tikai “Ostravar” alus, bet citas markas miestiņš te var parādīties vien īpašos izņēmuma gadījumos.
Jāatzīmē, ka “Ostravar Arena” lielo hokeju neuzņem pirmo reizi – IIHF pasaules čempionāts hokejā šeit aizvadīts jau 2005. un 2014. gadā. Tiesa, tolaik tā nesa “ČEZ Arena” vārdu.


Pilsēta pie “Dzintara ceļa”
“Inter Cars Latvija” klienti varēs izbaudīt arī vienas no vecākajām Čehijas pilsētām – Ostravas – gaisotni. Pirmo reizi tā rakstveidā pieminēta 1229. gadā, tiesa, tikai kā apmetne, savukārt kā apdzīvota vieta tā rakstos rodama ar 1267. gadu. Pilsēta tika būvēta gar tā saukto “Dzintara ceļu”, ko tirgotāji kopš neatminamiem laikiem izmantoja kā galveno tirdzniecības maršrutu, kas savienoja Baltijas jūru ar Vidusjūru. Četrpadsmitā gadsimta otrajā pusē tika uzcelti pilsētas mūri un pils, kura, iespējams, veidoja nocietinājumu daļu. Mūsdienās no aizsargmūra ir saglabājies tikai ielas nosaukums “Na hradbách” un fragments pie Svētā Vāclava baznīcas.
Ostravu mēdz dēvēt arī par “Čehijas tērauda sirdi”, jo šeit atrodas valsts tērauda rūpniecības galvenā mītne. Saglabājies arī 19. gadsimta pirmajā pusē tapušais rūpniecības rajons, kas iekļauts Eiropas kultūras mantojuma sarakstā. Pilsētā netrūkst ne muzeju, no kuriem daļa izveidota kādreizējo raktuvju vietās, ne kafejnīcu, ne arī arhitektoniski interesantu ēku. Ja ir vēlme sīkāk iepazīties ar pilsētas vēsturi,
noteikti vērts apmeklēt Ostravas muzeju vecajā Rātsnama ēkā, savukārt iespaidīgs skats uz pilsētu, tās apkaimi un kaimiņos esošo Poliju paveras no visaugstākā Pulksteņa torņa Čehijā, kura skatu laukums atrodas 72 metru augstumā.
Par komfortu un naktsmītnēm ir padomāts!
Kā nozīmīga transporta maģistrāle Ostrava ir viegli pieejama ar automašīnu, dzelzceļu un gaisa transportu. Ostravas tūrisma piedāvājums vēsta, ka izmitināšana un ēdināšana ir tādā līmenī, kas ļauj apmierināt pat visprasīgāko viesu vēlmes. Tā arī ir, bet tikai ne tajā laikā, kad Ostravā virmos lielā hokeja kaislības! PČ hokejā laikā praktiski visas iespējamās naktsmītnes un viesnīcu numuriņi jau ir izpirkti, bet atrast piemērotu nakšņošanas vietu “Ostravar Arena” tuvumā jau ir neiespējamā misija. Tiesa, “Inter Cars Latvija” klientiem par to nav jāuztraucas – komfortabla dzīvošana viesnīcā viņiem ir nodrošināta. Atliek vien izpildīt LIQUI MOLY, OSRAM, EXIDE, TUDOR un DETA akcijas vai balstiekārtas produktu akcijas noteikumus, un lielais hokejs “Ostravar Arena” jūs gaida!
Izklaide 134
Savu tagadējo nosaukumu arēna guva 2016. gadā, kad “Ostravar” alus darītava kļuva par tās ģenerālpartneri.

MOTOREĻĻAS UN PIEDEVAS RAŽOTAS VĀCIJĀ EKSKLUZĪVAS SMĒRVIELAS KATEGORIJA: EĻĻAS/SMĒRVIELAS
Inovācijas un ilgtspējīga mobilitāte

Jūs varat uz to paļauties
Kādu laiku mēs vēl turpināsim darboties ar iekšdedzes dzinēju. Taču nākotne pieder e-mobilitātei un citām bezizmešu piedziņām. Uz ielas un autoservisā.
Tādēļ mēs rūpējamies par vienu lietu, neatstājot novārtā citu: MAHLE izstrādā un piedāvā atbilstošus produktus un risinājumus, kā arī visaptverošus servisa pakalpojumus ilgtspējīgai mobilitātei gan saistībā ar iekšdedzes dzinēju, gan ar elektropiedziņu vai alternatīvajām tehnoloģijām un degvielām. Mūsu sortiments aptver preces no dzinēju dzesēšanas un gaisa kondicionēšanas sistēmām līdz servisu aprīkojumam un diagnostikai.
Laikā, kad mobilitāte strauji mainās, mums nepieciešams pieredzējis, uzticams un inovatīvs partneris. Kāds, kurš ne vien
garantē kvalitāti, uzticamību un kompetenci, bet arī zina vēl “nebrauktus” ceļus.
Izmantojot MAHLE, jūsu darbnīca sasniegs 100% efektivitāti –šodien un rīt.

mahle-aftermarket.com

Ieslēdz elektrisko nākotni
Uzlabots elektroauto šķidrumu klāsts, lai palīdzētu elektriskajiem transportlīdzekļiem braukt tālāk¹, uzlādēties ātrāk² un kalpot ilgāk³
*Castrol EV šķidrumu priekšrocības tiek demonstrētas pēc veikto pasūtījumu testēšanas un izstrādes.
¹
²
netiešo
³ pret standarta elektroauto transmisijas šķidrumu
pret masu tirgus elektroauto rūpnīcās uzpildīto šķidrumu
pret
dzesēšanas akumulatoru sistēmu



nosacījumi – Monroe.com
*Garantijas
*
KALPOS ILGĀK
PAMATĪGI BŪVĒTS





































































































































































 Texa NP 01
Texa NP 01








 lai sniegtu vairāk jebkuros laikapstākļos
lai sniegtu vairāk jebkuros laikapstākļos






































































































































 NIEMIECKA PRECYZJA ZNANA NA CAŁYM SWIECIE
NIEMIECKA PRECYZJA ZNANA NA CAŁYM SWIECIE

Bremžu mehānismu filtri
Bremžu mehānismu filtri
































































































































































































 Inovācijas Ilgtspējība Uzticamība Augsta veiktspēja
Nākotnes radīšana – Exide stilā:
Inovācijas Ilgtspējība Uzticamība Augsta veiktspēja
Nākotnes radīšana – Exide stilā:













